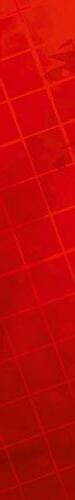
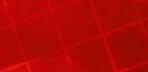

Marktübersicht Franchisekonzepte ab Seite 68
Marktübersicht Franchisekonzepte ab Seite 68




Marktübersicht Franchisekonzepte ab Seite 68
Marktübersicht Franchisekonzepte ab Seite 68



Liebe Leserin, Lieber Leser,

Am 4. November 2022 erreichte die Fitnessbranche die traurige Nachricht vom Tod Rainer Schallers. Nach dem Absturz eines Flugzeugs an der Küste von Costa Rica gab es Hinweise darauf, dass der McFit-Gründer an Bord des Flugzeugs gewesen ist. Erst nach tagelangem Warten konnte eine der gefundenen Leichen als Rainer Schaller identifiziert werden.
Daraufhin zollte eine ganze Branche einem ihrer größten Unternehmer und Visionäre Tribut. Denn auch wenn Rainer Schaller in der Fitnessbranche nicht unbe dingt von allen immer gemocht wurde, so hat er die Branche doch entscheidend geprägt und sie in vielen Teilen beeinflusst. Daher löste die Nachricht ein breites Echo bei Unternehmern in der Branche aus.
Selten bilden wir Personen der Branche auf unserem Cover ab, in diesem Fall schien es uns jedoch richtig zu sein, ihm unser Titelmotiv zu widmen. Zuerst stellten wir uns die Frage, ob es passend wäre, das verwendete Bild schwarzweiß zu färben, um das Andenken Rainer Schallers so zu würdigen. Aber wir entschieden uns dagegen, denn auch wenn er nicht mehr lebt, so ist sein Einfluss auf die Fitnessbranche nicht wegzudiskutieren und sein Andenken lebt in seinem Vermächtnis weiter. Daher erschien es uns ratsamer, das Bild farbig zu lassen und ihn so in Erinnerung zu behalten, wie er gelebt hat.
Zum Andenken an die Verdienste von Rainer Schaller widmen wir ihm unser Titelmotiv.

Titelgestaltung: Jessica Urich
Und nun viel Spaß beim Lesen!
 Ihr Jonathan Schneidemesser Chefredakteur
Ihr Jonathan Schneidemesser Chefredakteur














































































26 Die Rolle der Führungskräfte bei der Mitarbeiterbindung
Mitarbeiterbindung zahlt sich aus 36 Mitarbeiterbindung in anspruchsvollen Zeiten 42 Personalmangel durch Mitarbeiterbindung vorbeugen
Mitarbeiterbindung – wie machen Sie das?
96 Thalia: Trends frühzeitig erkennen und umsetzen 102 Unternehmerkrankheit Burnout 106 Steigerung der Nebenumsätze um 1.000 %
110 Zusammenarbeit entscheidend für die Zukunft der Fitness 114 Ein Tag gespickt mit Innovationen 120 Technogym Innovation Outlook in Frankfurt 122 Zwei Tage intensiver Austausch beim Aufstiegskongress 124 myline präsentiert Neuheiten auf Livetour 128 Das Finale der milon und five Stadiontour in der Allianz Arena 130 3. Fitnesswissenschaftskongress 132 Erfolgreicher DHZ-Partnertag in Berlin






Das neue Fitnessstudiokonzept „clever fit on“ spart durch ein nachhaltiges Ge bäudemanagement Licht, Wärme und Lüftungskosten. clever fit bietet seinen Franchisenehmern damit eine kostengünstige Variante für den ländlichen Raum, was Fläche und Personal angeht. Kürzlich wurde in der 8.000 Einwohner großen Stadt Dietenheim das erste „clever fit on“ auf nur 350 m² eröffnet. Bei „clever fit on“ läuft der Betrieb mit nur zwei Fachkräften in den Stoßzeiten. Ansonsten funk tioniert alles vollautomatisch.
KONTAKT +49 (0) 8191 / 3052600 | info@clever-fit.com | www.clever-fit.com
Die australische Fitnesskette Body Fit Training (BFT) kommt nach Deutschland. Body Fit Training wurde 2016 in Melbourne gegründet und hat mittlerweile 210 Standorte eröffnet und 450 Franchises in sechs Ländern verkauft. Durch den Verkauf des nordamerikanischen Body Fit Training-Geschäfts an Xponential Fitness ist das Unter nehmen nun für ein schnelles Wachstum gerüstet. Für In teressenten fanden am 21. November in Berlin und am 22. November in Köln zwei Roadshow-Veranstaltungen statt.

Die Studiosoftware agilea stellt ab dem 1. Dezember Schnittstellen zu zusätzlichen Zahlungsanbietern zur Ver fügung. Durch höchste Sicherheitsstandards und maxi male Flexibilität beim Bezahlen können Fitnessstudios Vertragsabschluss und Zahlung so einfach machen wie Anbieter von Streamingdiensten. Dank der Einbindung von Bezahldiensten können sie Mitglieder gewinnen und Rücklastschriften vermeiden. Mit Digital Payment macht agilea die beliebtesten Zahlarten für Fitnessstudios zu gänglich. Ab dem 1. Januar 2023 wird es noch mehr Flexibilität bei der Auswahl der Zahlungsdienstleister geben.
KONTAKT

Open SPACE heißt die neue digitale Plattform für die Fitnessbranche. Das von der Sport Alliance gestartete Projekt hat das Ziel, Fitnessstudiobetreiber und Industrie an einem Ort zusammenzubringen, wo sie gewinnbringende Inhalte teilen und sich gegenseitig unterstützen können. Ob inhabergeführte Fitnessstudios, Fitnessketten, Beratungs- oder globale Industrieunternehmen –Open SPACE soll für alle zugänglich sein, die der Fitnessbranche zu weiterem Wachstum verhelfen möchten.

KONTAKT +49 (0) 40 / 4293240 | info@sportalliance.com | www.sportalliance.com






21 Matrix Climbmills, Ausdauersportler Joe Kelly und 20 Unter nehmensteams – das war das Setting für den RTL Spenden marathon am 17. und 18. November 2022. 24 Stunden erklom men die Teilnehmer im Rahmen der Joey Kelly Challenge, die Teil des RTL Spendenmarathons ist, Stufe für Stufe, um den Weltrekord von 2 Mio. Stufen zu knacken und damit Kindern in Not zu helfen (Ergebnis stand zu Redaktionsschluss noch nicht fest). Alle Spenden, die im Rahmen der Joey Kelly Chal lenge eingesammelt werden, kommen der „Stiftung RTL –Wir helfen Kindern e. V.“ und damitnotleidenden Kindern zugute.
KONTAKT +49 (0) 2234 / 9997100 info@johnsonfitness.eu www.johnsonhealthtech.com
Basic-Fit konnte im laufenden Kalenderjahr bisher ein Mitgliederwachstum von 42 % auf 3,15 Millionen erzielen. Zu Beginn des Jahres waren es 2,22 Millionen Mitglieder. Angesichts der bisherigen positiven Entwicklungen in 2022 will das Unternehmen seine langfristigen Wachs tumspläne konsequent weiterverfolgen. Bis Ende 2022 soll es mehr als 1.200 Basic-Fit Clubs geben. Angesichts der aktuell schwierigen Situation geht das Unternehmen davon aus, dass man bis Ende des Jahres rund 3,35 Mil lionen Mitgliedschaften realisieren könne, was einem An stieg von 50 % entspräche. Ende des Jahres 2022 soll ein Umsatz von etwa 800 Millionen Euro erzielt werden. Das bereinigte EBITDA wird voraussichtlich zwischen 200 und 205 Millionen Euro betragen.
KONTAKT kundenservice@basic-fit.de www.basic-fit.com/de-de


Die Firmen Heuser und excio gehen fortan mit einer neuen Gesellschaft ge meinsame Wege. Die Heuser Excio GmbH tritt seit dem 1. Oktober 2022 am Markt auf und übernimmt den Betrieb der excio GmbH. Als Hersteller werden weiterhin Trainingsgeräte „Made in Germany“ gefertigt und über externe Ver triebsstrukturen am Markt angeboten. Durch die neue Gesellschaft werden künftig nicht nur Synergien im Vertrieb, sondern auch in Konstruktion und Fer tigung genutzt.
KONTAKT +49 (0) 6163 / 817500 | info@excio.de | www.excio.de
Alle Ausbildungstermine der Indoor Cycling Group (ICG) für das kommende Jahr sind ab sofort online buchbar. Für alle Cyclingbegeisterte, die Unterstützung auf ihrem Weg in die Indoor-Cycling-Karriere suchen, schafft eine Ausbildung zum ICG® Basic-Level-Instruktor geeignete Grundlagen. Gezielte Weiterbildungsmöglichkeiten finden Trainer bei einer Ausbildung zum ICG®-Pro-Level-, -Premium-Level- oderElite-Level-Instruktor. In zahlreichen Wahlmodulen können weitere Schwerpunkte ver tieft werden.

KONTAKT +49 (0) 911 / 544450 | info@indoorcycling.com | www.teamicg.de






Die milongroup und FACEFORCE präsentieren eine neue Lösungsstrategie zur Mitgliedergewinnung. Im Mittelpunkt steht eine vollautomatisierte „Maschine“ zur raschen Ge winnung neuer Mitglieder. Kombiniert mit neuen Kon zepten wie dem „Raum der Erkenntnis“ und den modu laren Trainingswelten der milongroup können die neuen Mitglieder anschließend langfristig gehalten werden. Die Einführungsangebote sind auf die Dauer von drei Mona ten begrenzt. Kunden der milongroup erhalten günstige Sonderkonditionen. Die Umsetzung ist in jeder Einrichtung möglich, unabhän gig von der bislang verwendeten Soft ware oder sonsti gen Ausstattungen vor Ort.
Digitalisierungsprojekte für KMU können in Deutschland in vielen Fällen vom Land oder Bund gefördert werden –meistens mit um die 50 % Zuschuss. Schon seit 2020 zählt die igroup Internetagentur zu den autorisierten Be ratungsunternehmen des Bundesministeriums für Wirt schaft und Klimaschutz (BMWK) für das bundesweite Pro gramm go-digital. Bei go-digital können Projekte mit bis zu 16.500 € Förderung vom BMWK unterstützt werden. Nun ist die igroup In ternetagentur für zwei in 2022 neu gestartete Module akkreditiert und kann damit offiziell für die drei Module Digi talisierungsstrategie, Datenkompetenz und Digitale Markterschlie ßung beraten.
KONTAKT +49 (0) 7253 / 9875600 info@i-group.de | www.i-group.de
Am 19. November wurde der erste deutsche Standort von UFC GYM Germany im ersten Stock des Medienbunkers auf St. Pauli eröffnet. UFC GYM Germany ist Teil des weltweit agierenden Fitnesskonzepts UFC GYM. Bei der Eröffnungsfeier wur den den Gästen ein breites Programm und ein vielfältiges Sportangebot geboten.

KONTAKT +49 (0) 171 / 1688498 | info@ufcgym.de | www.ufcgym.de


In der bevölkerungsrepräsentativ angelegten Be fragung über ein Onlinepanel durch das Deutsche Institut für Service-Qualität und ntv wurde die Kun denzufriedenheit mit den Unternehmen in den Be reichen Preis-Leistungs-Verhältnis, Zuverlässigkeit und Transparenz untersucht. Über 65.000 Kunden haben entschieden, wer aktuell in puncto Fairness führend ist. Ulrike Schönfelder, Unternehmenskom munikation INJOY/ACISO, nahm am 20. Oktober den Preis für den 1. Platz für INJOY beim Deutschen Fairness-Preis entgegen.
KONTAKT +49 (0) 89 / 45098130 info@injoy.de | www.injoy.de
Um die Entwicklung der Fitnessbranche zu erfassen und belast bare Daten zu generieren, ist die Teilnahme an der Eckdatenstu die 2023 von höchster Bedeutung. Der DSSV e. V., das Prüfungsund Beratungsunternehmen Deloitte und die DHfPG führen statistische Erhebungen zum deutschen Fitnessmarkt un ter dem Titel „Eckdaten der deutschen Fitnesswirtschaft“ (kurz: Eckdaten) durch. Die Eckdaten geben einen Über blick über Branchenkennzah len der Fitness- und Gesund heitsbranche. Alle Betreiber von Fitness- und Gesund heitsanlagen in Deutschland sind aufgerufen, an der On linebefragung teilzunehmen. Die Veröffentlichung der Er gebnisse wird im März 2023 stattfinden.

KONTAKT
Polar Electro launcht mit der neuen Ignite 3 eine Fitnessuhr, die dem Nutzer dabei hilft, im Einklang mit dem Rhythmus des Körpers zu leben und die innere Uhr besser zu verstehen. Die Ignite 3 ist mit Funktionen ausgestattet, die vom Training bis zum Schlaf dabei helfen, den Lebensstil mit dem zirkadianen Rhythmus in Einklang zu bringen. Die Uhr misst die tägliche Aktivität, Herzfrequenz und den Kalorienverbrauch. Nachts verfolgen Schlaftools die Dauer, die Qualität und die verschie denen Schlafphasen des Nutzers. Im Anschluss wird eine voll ständige Analyse darüber erstellt, wie sich der Körper über Nacht erholt hat.
KONTAKT +49 (0) 6152 / 9236600 | info@polar-deutschland.de | www.polar.com/de


Heal11 GmbH wurde im Jahr 2021 von Heiko Kandler, Dominik Fogt und Tobias Hofstetter gegründet, mit dem Ziel therapeutische Einrichtungen zukunftsträchtig digitalisiert aufzustellen und alltägliche Arbeitsprozesse mithilfe von intelligent aufeinander abgestimmter, nutzerfreundlicher Soft- und Hardware zu vereinfachen.




Simple, transparent und digital Die All-In-One-Software, Proleos, deckt alle wichtigen Bausteine ab. Darunter fallen Terminvergabe, Zugriffskontrollen, Rechtevergabe, Arbeitspläne, Terminbuchungen, Mitglieder-Management, Mitgliedschaft-Management, sowie Analysen & Berichte, anstatt viele Softwares parallel bedienen zu müssen. Gleichzeitig ist sie intuitiv aufgebaut, um allen Mitarbeitenden den Zugang und den Umgang zu erleichtern. Zuletzt vereint Heal11 in seiner Software-Lösung Proleos, die gemeinsam mit der HMM Deutschland GmbH entwickelt wurde. eine möglichst transparente Preisstruktur.
Patienten sinnvoll leiten – Arbeit einsparen Perfekt harmonierend mit der Proleos Software, aber auch allein uneingeschränkt funktional: das Patientenleitsystem. Dieses ermöglicht digitale, automatisierte Kundenprozesse, indem es den/die Patient:in intuitiv durch die Einrichtung und Behandlung führt. Bestehend aus einem Check-In, einem Therapiedesk, verschiedenen Bildschirmen und Roomterminals, sowie optional einer Stele vereinfacht das Leitsystem den Alltag und kann Effizienz und Umsatz erhöhen bei gleichzeitiger Arbeitsersparnis.
 SCAN MICH
SCAN MICH
Am Check-In können sich Patient:innen, die zu einem Termin erscheinen, selbstständig einchecken, das System meldet das Eintreffen des/der Patienten:in und zeigt alle dazugehörigen Daten an. Am Therapiedesk können Patient:innen ihre Rezepte einscannen, personen- und behandlungsspezifische Daten bearbeiten, den digitalen Anamnesebogen ausfüllen, Patienten-Behandlungsverträge und Zusatzvereinbarungen bearbeiten und ausfüllen sowie selbst alle weiteren Termine ausmachen.
Über die Bildschirme und Roomterminals werden die Patient:innen durch die Praxis, in den Wartebereich und zu den Behandlungsräumen mithilfe von individuell vergebenen Zahlenkombinationen gelotst, um Anonymität zu gewährleisten. Gleichzeitig ist alles über PC oder Tablet steuerbar. Mithilfe des optionalen Pakets „Entertainment & Sales“ können den Patient:innen über die Bildschirme wissenswerte Informationen, Aktionen und Zusatzleistungen vermittelt werden. Zudem besteht über die Stele die Möglichkeit Zusatzleistungen auch direkt zu buchen und zu bezahlen.
Über das optionale Softwaretool „Evidenzbasierte Anamnese“ können die Fortschritte der Patient:innen genaustens dokumentiert werden und die Erfolge des Therapieverlaufs anschaulich aufgezeigt und bewiesen werden.
Neben Soft-und Hardware zeichnet sich die Heal11 GmbH außerdem durch ganzheitliches Denken und bietet somit auch die Integration von Physiotherapie in Gesundheitsstudios an. Das Unternehmen steht hier bei von der Planung, über die Zulassung, bis hin zur Eröffnung als Partner an der Seite.
Wie kaum ein anderer Unternehmer prägte Rainer Schaller die Fitnesswelt zuerst in Deutschland und später europa- und weltweit. Er hat die Fitnesswelt nachhaltig verändert und zählt daher zu Recht als einer ihrer größten Visionäre. Nun ist er im Alter von 53 Jahren bei einem Flugzeugabsturz ums Leben gekommen. Mit diesem Artikel blicken wir auf sein Lebenswerk zurück.

Es ging wie ein Schock durch die Fit nessbranche, als die ersten Hinweise auf den Flugzeugabsturz von Rainer Schaller und seinen Begleitern an die Öffentlichkeit gelangten. Schlagzeile folgte auf Schlagzeile, bis durch die Identifiaktion der Leichen dann endgül tige Sicherheit herrschte: Der größte Fitnessunternehmer Deutschlands ist tot.
Schon früh von Fitness begeistert Vor seinem Tod errichtete er mit der RSG Group ein Unternehmen, das mehr als 20 Marken, darunter Gold´s Gym, John Reed, CYBEROBICS und seit Kurzem auch HEIMAT, 6,4 Mio. Mitglieder und 41.000 Mitarbeiter unter sich vereint. Dabei fing alles klein an. Als 15-Jähriger hatte er bereits viele Sport arten ausprobiert, darunter Titschtennis, Ju-Jutsu und auch Fußball, aber nichts konnte ihn so begeistern wie Fitnesstraining. Schon damals erwachte in ihm die Idee, in diesem Sport beruflich tätig zu werden. Be vor er das verwirklichen konnte, trat er aber erst einmal in die Fußstapfen seines Großvaters und seiner Mutter und absolvierte eine Ausbildung zum Einzelhandelskaufmann bei EDEKA. Er besaß selbst vier Filialen, eine da von sogar bis zu seinem Tod.
Entgegen allen Widerständen eröffnete er 1995 auf dem Dachboden des EDEKA-Ladens seine erste inoffizielle Filiale, für die er gebrauchte gym80Geräte vom ehemaligen Weltmeister im Bankdrücken „Frank the Bank“ kaufte. Sein Konzept unterschied sich damals von anderen eher wellnessorientierten
Konzepten durch den Fokus auf das Training. Durch Verzicht auf Sauna, Schwimmbad und Co. konnte er seine Leistung deutlich günstiger verkaufen. Er kam bereits früh mit dem ALDIKonzept in Berührung und wollte dieses Prinzip in der Fitnessbranche umsetzen.
Das erste offizielle McFIT eröffnete dann 1997 in Würzburg. Wie viele andere Be treiber zu dieser Zeit kümmerte sich Rainer Schaller um alles selbst – vom Training über die Mitgliederverwaltung bis hin zum Reinigen und Marketing. Schaller gelang es gezielt, Aufmerk samkeit zu erregen. So war sein Slogan für das erste McFIT: „Jetzt auch in Würzburg“ Auf die Frage, wo es denn weitere McFits gebe, antwortete er nur: „Demnächst auch in Erlangen.“ Die Anfangszeit von McFIT ist voller erzäh lenswerter Anekdoten, so auch die der Namensfindung. Mit den Vorschlägen einer Werbeagentur wurden sie nicht so richtig warm, bis seine damalige Partnerin vorbeilief und sagte: „Nimm doch McFIT.“ Obwohl dieser Name nicht auf der Liste stand, wurde er verwendet.
Fitness für alle Was sich hingegen nicht durchgesetzt hat, ist der Slogan „Fitnesshalle für alle“, der noch auf dem ersten McFIT prangt. Dieser Anspruch spiegelt sich allerdings in Schallers Lebenswerk und dem Portfolio der RSG Group wi

der. Er wollte Fitness für jeden zugäng lich und attraktiv machen. Erst einmal sollte das Wachstum aber organisch und langsam stattfinden. Im Jahr 2000 folgten Eröffnungen in Bochum und Oberhausen, 2002 dann in Berlin. Hier wurden sogar vier Filialen an einem Tag eröffnet. Vier Jahre später domi nierte McFit den deutschen Markt bereits als mitgliederstärkste Fitness studiokette. Wiederum vier Jahre da nach eröffnete in München die 100. Filiale und McFIT startete 2009 mit seiner Europaexpansion. Dann wur de das Tempo höher – Schaller wei tete sein Business aus und gründete mit der McFIT MODELS eine Mode lagentur, entwickelte das High5-Kon zept, launchte JOHN REED. 2019 rebrandete das Unternehmen dann zur RSG Group. Der nächste Pauken schlag ließ mit dem Kauf von Gold´s Gym nicht lange auf sich warten – der Coronapandemie zum Trotz. Weiter ging es mit dem ersten CelebrityFitnesskonzept und SERGIO RAMOS by JOHN REED, das die Persönlich keit des Fußballers in den Vordergrund stellte. Der bisher letzte große Launch der RSG Group war HEIMAT. Schaller wollte es schaffen, allen Menschen, die Fitness betreiben wollten, mindes tens ein Angebot machen zu können. Fitness für alle eben.
Trotz des stetigen Aufstiegs von Rai ner Schaller und seiner Marke musste
er auch Rückschläge verkraften. So fiel das visionäre Projekt „THE MIRAI“ in Oberhausen der Coronapandemie zum Opfer, das nun als digitale Platt form weitergeführt wird. Geplant war es, ein Fitnessstudio zu schaffen, in dem jeder kostenfrei trainieren können sollte. Zudem sollten hier viele Daten über Training gesammelt werden, um Geräte und Übungen weiterzuentwi ckeln. Zu den dunkleren Stunden in Schallers Leben gehört sicherlich die Loveparade in Duisburg in 2010. Bei einer Massenpanik starben dort 21 Menschen, über 650 wurden verletzt. Während der Verhandlung trat Rainer Schaller als Zeuge auf und versuchte, seinen Beitrag zur Aufklärung zu leisten. Er übernahm die moralische Verantwortung für das Unglück und führte bis zu seinem Tode Gespräche mit Betroffenen, um diesen Beistand zu leisten.
Und genau in dieser Tätigkeit zeigt sich ein Teil der Persönlichkeit Schal lers, der oft unerwähnt bleibt – er hatte das Bedürfnis, Menschen etwas zu rückzugeben und Menschen zu hel fen. So plante er, dem vom Krieg ge beutelten Kiew das weltgrößte Gold´s Gym zu schenken. Aber auch viele an dere Wegbegleiter berichten von ihm als Freund und Mentor. Auch wenn die Person Rainer Schaller nicht mehr unter uns weilt, so wird die Branche seine Leistungen und sein Erbe nicht vergessen.
McFIT-Gründer Rainer Schaller ist im Alter von nur 53 Jahren verstorben. In der Nacht vom 21. auf den 22. Oktober stürzte sein Kleinflugzeug vor der Küste Costa Ricas ab. An Bord waren neben einem Kollegen und dem Kapitän auch seine Lebensgefährtin und die beiden Kinder. Am 4. November wurden die beiden gefundenen Leichen identifiziert. Seitdem herrscht traurige Gewissheit, dass der Unternehmer und sein Sohn verstorben sind.
Mit Rainer Schaller verliert die Fitnessbranche einen ihrer größ ten Visionäre. Er hat die Branche mit seinen Ideen und seinem Weitblick entscheidend geprägt und vorangebracht. Über Jahrzehnte hat Rainer Schaller maßgeblich zum Aufschwung der deutschen Fitnessbranche beigetragen und dafür gesorgt, dass die Branche in der Öffentlichkeit wahrgenommen wird. Unsere Gedanken sind bei den Freunden und Angehörigen Rainer Schallers, denen unsere tiefste Anteilnahme und unser Mitgefühl gilt. Mit Rainer Schaller verliert die Fitness- und Ge sundheitsbranche einen der großen Pioniere.

„Die letzten Tage lassen uns erschüttert und betroffen zurück. Mit großer Bestürzung haben wir die traurige Gewissheit er halten, dass unser Gründer Rainer Schaller und sein Sohn als Verstorbene des Flugzeugabsturzes in Costa Rica identifiziert
wurden. Seine Lebensgefährtin, deren Tochter, unser Kollege sowie der Pilot, die ebenfalls an Bord waren, befinden sich weiterhin unter den Vermissten. In dieser schwierigen Zeit gilt unser ganzes Mitgefühl den Angehörigen aller Menschen, die bei diesem Unglück ihr Leben verloren haben oder nach wie vor verschollen bleiben.“
„Die traurige Gewissheit, dass Rainer Schaller nicht mehr un ter uns ist, lässt uns alle geschockt zurück. Wer Rainer kannte, weiß, dass er es immer geschafft hat, Menschen zu moti vieren, mitzureißen, zu begeistern und zu faszinieren. Seine Vielfältigkeit, Bodenständigkeit, Willenskraft und Authentizi tät waren einzigartig und haben seinen außergewöhnlichen Lebensweg erst möglich gemacht. Rainers vitalisierende Art sowie zukunftsweisende Ideen haben viele Menschen inspi riert und im wahrsten Sinne des Wortes bewegt. Der Verlust eines Wegbegleiters, meines Freundes und eines Visionärs trifft mich persönlich sehr. Ich bin stolz und dankbar, ihn als Freund in meinem Leben und als Partner bei gym80 gehabt zu haben. Ich wünsche dir und deinen Liebsten eine gute Reise, mein Freund. In unseren Herzen lebst du weiter, denn Legenden sterben nie.“
Jetzt ist der perfekte Zeitpunkt, um die Möglichkeiten mit einer LES MILLS Partnerschaft zu entdecken, Einnahmen zu steigern, Mitglieder zu gewinnen, sie langfristig zu halten und dem Erfolg im Studio den Turbo-Boost zu verleihen.

Die Frage, warum es sich lohnt, die rund 15.000 Einwohner große Stadt Isny im Allgäu an der Landesgrenze von Bay ern und Baden-Württemberg zu besuchen, ist spätestens seit dem 30. Juli dieses Jahres leicht zu beantworten. Denn genau an diesem Datum wurde das PEAKS eröffnet – das Projekt der beiden Freunde und Jungunternehmer Moritz Wagner und Thien Nguyen.
Moritz Wagner und Thien Nguyen haben sich 2015 kennengelernt. Mo ritz Wagner, der damals als Trainer in einem Fitnessstudio in Isny arbeitete, gab Thien Nguyen ein Probetraining. Es stellte sich heraus, dass die bei den die Leidenschaft fürs Bergstei gen teilen. Also vereinbarten sie eine gemeinsame Bergtour. Seitdem sind die beiden beste Freunde. Ihre zweite große Leidenschaft ist Fitness. Bereits 2018 hatten sie erstmals die Idee, ein eigenes Studio in ihrer Heimatstadt zu eröffnen. Die konkrete Suche begann dann vor zwei Jahren. Ideen für die Studioeröffnung waren reichlich vor handen, was fehlte, war ausreichend Eigenkapital. Durch die Hilfe von zwei befreundeten Investoren, die sie mit kleineren Geldbeträgen unterstützten, sowie die Überarbeitung des Konzepts führten letztlich dazu, dass die Haus bank und Leasinggeber ihre Finanzie rungszusage erteilten und das Projekt im Rotenbacher Weg in Höhe von 760.000 Euro realisiert werden konnte.
Berge, so weit das Auge reicht Moritz Wagner, der zuvor als Immo bilienmakler bei einer Bank tätig war und sich verstärkt um die Themen Buchhaltung, Steuern und Finanzen kümmert, und Thien Nguyen, der für organisatorische Aufgaben im Studio zuständig ist, waren sich schnell einig. Sie wollten unbedingt ihr Hobby, das Bergsteigen, in ihrer Anlage themati sieren. Zum einen haben sie mit dem Namen PEAKS einen Namen gewählt, der übersetzt Gipfel bedeutet, und zum anderen wurde das komplette Design darauf abgestimmt. Bereits im Treppenhaus, auf dem Weg ins Studio, das sich in der oberen Etage befindet, zieren riesige Motive von All gäuer Bergen die Wände. Bei Betre ten des Studios fallen sofort die vielen kleinen, dimmbaren Lampen ins Auge, die an langen Kabeln von der Decke hängen und über dem Check-in befes tigt sind. Die Idee mit den Lampen ist ein echter Hingucker, der im mittleren und hinteren Teil bzw. im Kardio- und


im Freihantelbereich erneut aufgegrif fen wurde. Vom Check-in aus kann man die gesamte, offene Trainingsfläche gut überblicken. Was sofort auf fällt, ist die perfekte Kombination aus schwarzen Trainingsgeräten, dunklen Decken und hellem Holzboden. Und sei es beim Kaffeeholen an der Theke, auf dem Weg in die Umkleide oder in der Umkleide selbst – das komplette Studio ist geschmückt mit Motiven


von beeindruckenden Bergen und Berglandschaften. „Mit dem Namen PEAKS können wir uns super identi fizieren, da unsere Leidenschaft das Bergsteigen ist. Gleichzeitig haben wir durch den Namen und das Design einen Bezug zu unserer Heimat ge schaffen. Und das Thema Bergsteigen zieht auch Personen an, die ansonsten einen großen Bogen um ein Fitness studio machen würden“, erklärt Moritz
Wagner. Wichtig sei es den beiden Studiobetreibern gewesen, so Wagner weiter, eine Wohnzimmeratmosphäre –rustikal, aber gleichzeitig auch cool –zu kreieren und einen Look ähnlich wie in einem Allgäuer Berghotel zu schaf fen. Doch nicht nur fürs Auge, son dern auch für die Nase wird im PEAKS etwas geboten. Der angenehme Duft, der in der Luft liegt, ist auf das Zirben holz zurückzuführen, das überall, z. B.

Der Kraft- und Beweglichkeitszirkel befinden sich direkt neben dem Check-in
in Möbel- und Einrichtungsstücken so wie der Sauna, eingesetzt wird.
Hochwertige Ausstattung trifft auf perfektes Design Zahlreiche Angebote von verschiede nen Geräteherstellern hatten Moritz Wagner und Thien Nguyen zu Beginn der Studioplanung eingeholt. Die erste Entscheidung fiel zugunsten der Kardiogeräte von Matrix. Neben der Qualität und dem Design der Geräte waren die Studiobetreiber vor allem vom En gagement und der Unterstützung in Person von Bernd Zimmermann an getan. „Kurz nach unserer Anfrage hat er uns bereits in Isny besucht und hat sich Zeit genommen, um über unsere Vorstellungen zu sprechen“, erklärt Moritz Wagner. André Gerasch, Ge schäftsführer von The Gym Designer, hat den Innenausbau übernommen. Unterstützt wurde er dabei von den beiden Clubbetreibern, die viele Ar beiten gemeinsam mit befreundeten Helfern selbst ausgeführt haben. Die Ideen und die Umsetzung für das Interior stammen von Dustin Kuhl.
Neben den Kardiogeräten von Matrix zählen ein flexx- sowie ein EGYM-

Der Freihantelbereich wird durch die zahlreichen, dimmbaren LED-Lampen gekonnt in Szene gesetzt
Zirkel zur Ausstattung, die in unmittelbarer Nähe zum Check-in und der gemütlichen Sitzecke platziert sind. Gerade auch die Möglichkeiten, die der Zirkel in Sachen Betreuung bie tet, zieht Interessenten an, die bisher eher wenig Erfahrung mit Fitnesstraining gemacht haben. Im Kraft- und im Freihantelbereich vertraut man auf Geräte von gym80, die ebenso wie alle anderen Geräte perfekt auf das Interior-Konzept abgestimmt sind. Auch im Lady-Fitness-Bereich, der sich in der Mitte der Trainingsfläche befindet, kommen gym80-Geräte zum Einsatz. Einziger Unterschied: Im Ge gensatz zur restlichen Trainingsfläche hebt sich die Frauen-Area stilistisch von der restlichen Studiofläche ab. Die Geräte sind hier nicht schwarz, son dern weiß. Große Spiegel und schöne Deko-Elemente wie z. B. stylische Lampen sorgen dafür, dass sich die weiblichen Mitglieder rundum wohl fühlen. „In Isny gibt es außer uns noch drei Studios. Die können aber in Sa chen Ausstattung bei Weitem nicht mit uns mithalten. Wir spüren schon, dass sich das allmählich herumspricht und immer mehr Interessenten den Weg zu uns ins Studio finden“, freut sich Thien
Nguyen. Derzeit zählt das PEAKS rund 450 Mitglieder.
Neben den topmodernen Trainings möglichkeiten steht den Mitgliedern eine Theke inklusive Kaffeespeziali täten zur Verfügung. Und auch das Thema Regeneration und Wellness kommt nicht zu kurz. Wer möchte, kann bereits in den Umkleiden die Seele baumeln lassen. Einmal mehr wurde hier das Thema Berge und Bergsteigen stilistisch perfekt und äu ßerst realitätsnah umgesetzt. Runde Spiegel, große Ablageflächen aus Holz und die edlen Umkleideschränke sorgen für die gewünschte Wohlfühlatmosphäre. Klein aber oho – das trifft auf den Wellnessbereich zu, der über die Herren- und Damenumkleide erreichbar ist. Neben einem Solarium und Massagesesseln und einer Hydrojet-Massageliege ist die Zirbenholzsauna das Highlight. Und natürlich, wie könnte es auch anders sein, kann auch beim Schwitzen in der Sauna ein Bergmotiv bestaunt wer den. Auch im Wellnessbereich wurde das Zusammenspiel aus hellen Holzund dunklen Farbtönen sehr gelungen umgesetzt.

Damen können im stylischen Ladies-Bereich trainieren
Name: PEAKS Fitness & Wellness Eröffnung: 30. Juli 2022 Lage: Isny im Allgäu. Isny hat rund 15.000 Einwohner und ein Einzugsgebiet von 30.000. Die Kleinstadt ist an der Landesgrenze von Baden-Württemberg und Bayern gelegen. Größe: 930 m2 Invest: 760.000 Euro (Neubau), Bauphase: 9 Monate Geschäftsführer: Moritz Wagner & Thien Nguyen Mitglieder: 450 (Stand 28. Oktober 2022) Besonderheiten: In der gesamten Anlage sind große Bildmotive von Allgäuer Bergen zu sehen. Das Bergstei gen ist die große Leidenschaft beider Studiobetreiber, die auf den Bildern teilweise selbst zu sehen sind. Das Ziel, durch das Design eine Verbundenheit zum Allgäu und gleichzeitig eine moderne, gemütliche Wohnzim meratmosphäre zu schaffen, wurde perfekt umgesetzt. Ausstattung: Matrix, EGYM, fle-xx, gym80 Design: Die Ideen und Umsetzung beim Interior stammen von Dustin Kuhl von Fifty Fifty Design, für den Innenausbau zeichnet André Gerasch von The Gym Designer verantwortlich. Kontakt: www.peaks-isny.de


Im PEAKS gibt es drei unterschiedliche Mitgliedschaftsvarianten – Silber, Gold und Platin. Gemeinsam haben sie die Laufzeit von jeweils einem Jahr. Der Basisvertrag bzw. die Silbervariante umfasst für 10 Euro pro Woche neben dem Training die Getränkeflat. Wer sich für das mittlere Angebot (Gold) entscheidet, kann für 12,50 Euro wöchentlich zudem am EGYM-Zirkel trainieren und die InBody-Waage zur


Körperanalyse nutzen. Im Preis inbe griffen ist zudem eine Kaffee-Flatrate. Die Platin-Mitgliedschaftsvariante kos tet 17,50 Euro pro Woche. Neben den bereits genannten Trainingsmöglich keiten ist die Nutzung des Wellness bereichs inkludiert.
Die Hartnäckigkeit und das Durchhal tevermögen von Moritz Wagner und Thien Nguyen haben sich definitiv

gelohnt. Mit dem PEAKS haben die beiden 27-Jährigen ihre Vision, ein hochmodernes Fitnessstudio in ihrer Heimatstadt Isny zu eröffnen, in die Tat umgesetzt. Selbst die Coronapande mie konnte die beiden Jungunterneh mer nicht von ihrem Vorhaben, sich selbstständig zu machen, abhalten.
Trotz einiger Rückschläge und Bauverzögerungen haben sie nie ihr Ziel aus den Augen verloren, so wie es sich für wahre Gipfelstürmer eben gehört.

milon YOU hebt den Screening- und Onboardingprozess für Training und Therapie auf ein neues Level und garantiert maximalen Erlebnisfaktor dank 3D-Avatartechnologie.

Der gesamte Onboardingprozess ist maximal verkürzt, sodass neue Mit glieder schnell und einfach ins Training gebracht werden können. Der Scan der Körpermaße liefert nun noch prä zisere Ergebnisse für ein höchst indi viduelles und effizientes Training, das sofort beginnen kann. Wie gehabt stel len sich alle milon-Q-Geräte anhand der gemessenen Daten automatisch ein. Während der Screenings lassen sich körperliche Einschränkungen so wie individuelle Schmerzpunkte und -zustände erfassen. Bereits im Studio vorhandene Tools oder Körperwaagen können zudem problemlos angesteu ert werden.
Bei der Entwicklung von milon YOU stand stets der User im Fokus. So soll der Trainierende ein besseres Ver ständnis für seinen eigenen Istzustand
und die angestrebten Ziele sowie Fort schritte auf dem Weg dorthin erhalten. Zu Beginn wird zwischen drei verschie denen Trainingsmotiven ausgewählt. Wenn gewünscht, kann der passen de Trainingsplan sogar automatisch zugewiesen werden. Dann stehen regelmäßige Re-Checks auf dem Pro gramm, die valide Auskunft über zen trale Fragen des Trainingszustandes geben – sowohl persönlich als auch im Vergleich zum Durchschnitt (Alter, Geschlecht). Im Rahmen von neuen Fitness- und Beweglichkeitstests stellt der Trainierende seine Reaktionsfähig keit, Beweglichkeit und die kognitiven Fähigkeiten auf die Probe. Verständli che Auswertungen mit neuen Visuali sierungen sorgen dabei für noch mehr Motivation im Trainingsalltag.
3D-Avatartechnologie
Highlight von milon YOU ist eine neue 3D-Avatartechnologie, die im Wett
bewerbsumfeld einzigartig ist. Auf dem riesigen Display erscheint der Benutzer oder die Benutzerin als digitales Abbild von sich selbst. Der wahlweise männliche oder weibliche Avatar schlüpft in die Rolle des Coaches oder Trainingspartners und gibt in Echt zeit konstruktive Rückmeldungen, die beispielsweise die richtige Haltung be treffen. Die besondere 3D-Optik bringt die User Experience auf ein neues Level.
milon Industries GmbH An der Laugna 2 86494 Emersacker
Tel. +49 (0) 8293 / 965500 E-Mail: info@milongroup.com Web: www.milongroup.com
Mit dem neuen XBody DRY-System können Sie ab jetzt allen Kunden ein EMS Training ohne Wasser anbieten, egal ob mit den „Studio-Anzügen“ und der trockenen Unterwäsche oder mit einem eigenen Anzug, dem „XBody Personal-Suit“.







































































































































































































Die potenzielle Gefahr, dass Mitarbeiter ein Unternehmen verlassen, ist so hoch wie noch nie. Gerade in der Fitnessbranche zeigt sich das derzeit deutlich. Daher ist es umso wich tiger, die Mitarbeiter, die im Unternehmen sind, mit Wertschätzung zu behandeln. Dabei spielen Führungskräfte eine ganz wichtige Rolle.
Was sind eigentlich die Top-5-Grün de, warum Mitarbeiter ihren Arbeit geber verlassen? Rollen wir das Feld mal von hinten auf, um die Spannung etwas zu erhöhen. 15 % wollen mit ihrem Wechsel eine attraktivere Posi tion erhalten, für 19 % sind es finan zielle Anreize. Die Chance, in einem attraktiveren Tätigkeitsfeld arbeiten zu können, bewegt immerhin 24 % zum Wechsel des Arbeitgebers. Und 27 % wechseln, um ihre Work-Life-Balance zu verbessern. Der absolute Spitzen

reiter und mit 28 % der wichtigste Grund, warum Mitarbeiter ihren Job wechseln, ist das Führungsverhalten der Vorgesetzten. Es geht also nicht primär um den Arbeitsplatz an sich, sondern um die Menschen, mit de nen man zusammenarbeitet. Andere Untersuchungen wie auch die Erfah rung zeigen, dass es viele Menschen trotz ungünstiger Bedingungen in ei nem Job hält, wenn die Beziehung zu den Kollegen und den Vorgesetzten stimmt.
Viele Mitarbeiter wollen wechseln Und jetzt wird es spannend. Aktuelle Zahlen des Engagement-Index zeigen, dass 15 % der befragten Angestellten bereits innerlich gekündigt haben und 61 % mit dem Arbeitgeberwechsel maximal noch ein Jahr warten wollen. Das sind erschreckend hohe Zahlen. Und genau hier müssen Unternehmen ansetzen und dieser Weg geht vor al lem über die persönliche Bindung zwi schen Mitarbeiter und Führungskraft bzw. den Inhaber.
Letztlich sind es viele Faktoren, die ei nen Mitarbeiter dazu bewegen, dem Unternehmen treu zu bleiben, und normalerweise niemals einer alleine. Im Allgemeinen ist es eine Mischung aus harten und weichen Faktoren.

Den Hauptanteil, und das zeigt auch die oben genante Top-5-Liste, macht die persönliche Bindung aus. Das be deutet nicht, dass Geld etc. keine Rolle spielt, aber eine gute emotionale Bin dung zwischen Mitarbeiter und Füh rungskraft kann viel Negatives kom
Passen Bewerber und Unternehmen gut zusammen, kommt es darauf an, die Verbindung zwischen beiden zu stärken. Und genau das ist die Aufga be der Führungskräfte. Dabei spielen folgende Faktoren eine Rolle: Gibt es regelmäßige Gespräche zwischen Führungskraft und Mitarbeiter? Ist ge nug Empathie vorhanden, um auf den Mitarbeiter eingehen zu können? Hat die Führungskraft die Fähigkeit, Aufga ben gerecht zu verteilen und für eine gute Stimmung im Team zu sorgen?
pensieren. Weitere relevante Punkte sind die gelebte Unternehmenskultur, die Zusammensetzung des Teams und eben der Führungsstil. Dieser soll te, gerade in Zeiten von einer hohen Fluktuation, darauf ausgerichtet sein, die Mitarbeiter an Unternehmen zu binden. Und ganz wichtig zu wissen, Mitarbeiterbindung beginnt nicht erst am ersten Arbeitstag, sondern bereits früher.
Mitarbeiter müssen zum Unternehmen passen Schon im Auswahlprozess können die ersten Weichen für eine langfris tige Beziehung gelegt werden, in dem Kandidaten ausgewählt werden, deren Profil gut zum Unternehmen passt. Dazu sollte man in einem ersten Schritt prüfen, ob die fachliche Qualifikation passt, und wenn das gegeben ist, in einem zweiten Schrit zu klären, ob die Erwartungen des Bewerbers in diesem Unternehmen erfülllt werden können. Und genau das wird noch zu selten gemacht. Man sieht, was der Bewerber alles kann, und freut sich darauf, einen neuen kompetenten Mitarbeiter eingestellt zu haben, nur um dann nach einem Jahr oder so gar schon früher genau diesen wieder gehen lassen zu müssen, weil er sich nicht im Unternehmen wiederfindet. Das setzt allerdings voraus, dass der Inhaber das eigene Unternehmen rea listisch einschätzen kann und weiß, wo Probleme sind und welche Erwartun gen einfach aus strukturellen Gründen nicht erfüllt werden können.
Dafür muss der eigene Führungsstil reflektiert und evtl. angepasst werden. Letztlich geht es bei all diesen Punkten um das Thema Wertschätzung. Ist die se vorhanden und wird durch die Füh rung gelebt, wird das Band zwischen Mitarbeiter und Führungskraft immer stärker, was die Wahrscheinlichkeit ei ner Trennung deutlich verringert. Und auch hier sprechen die Zahlen eine starke Sprache – fast die Hälfte der Befragten in einer Studie gab an, sich nicht wertgeschätzt zu fühlen. 43 % sprachen davon, manchmal wert geschätzt zu werden, und nur 11 % erfuhren regelmäßige Wertschätzung.
Nun ist es nicht so, dass Unternehmen nicht versuchen würden, ihre Mitarbei ter wertzuschätzen. Befragt man diese allerdings, in welcher Form sich diese Wertschätzung äußert, so zeigt sich wieder ein interessantes Bild. In 26 % der Fälle sind es Boni oder andere finanzielle Zuwendungen, mit denen Unternehmen Wertschätzung zeigen wollen, bei 5 % der Befragten waren es zusätzliche Urlaubstage, öffent liches Lob gaben 16 % an und jeder Zehnte gab an, dass Wertschätzung über eine Beförderung ausgedrückt wird. Aber 43 % sagten, dass sie nicht wissen oder erkennen können, wie ihr Arbeitgeber und ihre Führungskräf te sie wertschätzen. Hier gibt es also noch einiges zu tun. Auch unter dem Gesichtspunkt, dass die Generation Z nach und nach in den Arbeitsmarkt kommt und das Thema Wertschät zung noch deutlich stärker einfordert.
Schon im Auswahlprozess können die ersten Weichen für eine langfristige Beziehung gelegt werden
Eine gute Möglichkeit Wertschätzung zu zeigen, ist es, Interesse für das Gegenüber zu haben
Wie Wertschätzung zeigen?
Was also kann man als Führungskraft oder Inhaber tun, um Wertschätzung zu zeigen? Eine gute Möglichkeit ist es, auch in einem stressigen Arbeits umfeld Interesse für das Gegenüber zu zeigen, um mehr über die Person zu erfahren. In gemeinsamen Pausen, Gesprächen an der Kaffeemaschi ne oder zusammen durchgeführten Aktivitäten bietet sich die Möglichkeit dazu. Einerseits ist es hier sehr wichtig zuzuhören und andererseits sollte man auch einige Informationen über sich an das Gegenüber preisgeben. Diese Gespräche machen es dann leichter für den Alltag, eine nette Begrüßung auszusprechen oder den Mitrbeiter zu loben. Generell ist es ein Zeichen für Wertschätzung, wenn man sich kurz Zeit für einen Mitarbeiter nimmt. So kann sinnbildlich eine Türe entstehen, die wirklich immer offen ist.
Nette Worte sind aber nur der An fang eines wertschätzenden Verhal tens. Belohnungen sind auch nicht schlecht. Das können finanzielle Be lohnungen sein, die sich bei vielen aber sehr schnell abnutzen. Daher können es auch positive Leistungen sein, für die man den Titel „Mitarbeiter des Monats“ erhält, aber auch kreati ve Kuchen zum Geburtstag, die einen Teil der Persönlichkeit widerspiegeln. Je individueller die Ideen sind, desto stärker zahlen sie auf die Mitarbeiter bindung ein, denn so zeigt sich, wie

viel die Führungskraft über den Mitar beiter weiß. Daher sollten Mitarbeiter geschenke im Optimalfall auch nicht standardisiert sein.
Zu seinem Wort stehen Möglicherweise der relevanteste Punkt ist es, zu seinem Wort zu ste hen, also keine leeren Versprechungen zu machen. Wurden Veränderugen in den Abläufen oder an ihrem Arbeits platz zugesagt und es tut sich über eine längere Zeit nichts, werden diese Mitarbeiter unzufrieden und werten das als mangelnde Wertschätzung, auch wenn es von den Führungskräf ten her nicht so beabsichtigt ist. Mög licherweise haben sie es einfach noch nicht geschafft, es umzusetzen. Dann stellt sich aber wiederum die Frage der Priorisierung und gerade in Zeiten von hoher Mitarbeiterfluktuation kann man es sich nicht mehr leisten, Zusa gen zu machen, die nicht eingehalten werden.
Auch wenn man neue Mitarbeiter im Vorfeld so ausgewählt hat, dass sie gut zum Unternehmen passen, kann es sein, dass sie etwas Zeit brauchen, um ihr Potenzial zu entfalten. Das be deutet, man sollte dranbleiben und nicht zu schnell davon ausgehen, dass man die falsche Entscheidung getrof fen hat. Jeder Mitarbeiter macht in unterschiedlichem Tempo seine Fort schritte. Es zeigt Wertschätzung, wenn man Mitarbeiter in diesem Prozess
unterstützt und ihnen die Zeit gibt, die sie brauchen. So können Mitarbeiter nachhaltig entwickelt werden.
Im Vergleich zur Geringschätzung ist es ein Zeichen von Wertschätzung, sich auf die Stärken und guten Seiten eines Mitarbeiters zu konzentrieren und nicht das Negtive in der Vorder grund zu stellen und schon gar nicht vor anderen, insbesondere wenn der Betroffene gerade nicht anwesend ist. Und noch ein Tipp zum Abschluss: Wenn Mitarbeiter Anfragen stellen oder einen Wunsch äußern, sollte man zeigen, dass man diesen wahr genommen hat. Nicht jeder Wunsch kann umgesetzt werden, dann macht es aber Sinn, den Mitarbeiter mit in die Kommunikation zu nehmen und aufzuzeigen, warum es nicht geht. Oft stößt man damit auf Verständnis und wird nicht ständig darauf ange sprochen, weil der Mitarbeiter wissen möchte, wie der Stand seiner Anfrage ist.
Führungskräfte haben viele Möglich keiten, Wertschätzung gegenüber ih ren Mitarbeitern auszudrücken, und sie sollten das auch tun. Es gehört zu ihren wichtigsten Aufgaben. Und ein toller Nebeneffekt soll nicht unerwähnt bleiben: Mitarbeiter, die sich in einem Unternehmen wohlfühlen, sprechen darüber und machen das Unterneh men attraktiv für weitere Mitarbeiter.



Gutes Personal zu finden ist enorm schwierig und die Situation wird sich, da sind sich Ex perten einig, in den nächsten Jahren weiter verschärfen. Das Thema Mitarbeiterbindung sollte daher gerade auch in der Fitnessbranche oberste Priorität genießen und Chefsache sein. Wie Mitarbeiterbindung aussehen kann und was Studiobetreiber beachten müssen, darüber haben wir mit René Grendel gesprochen.
BODYMEDIA: Einige Branchen wur den durch die Coronapandemie stark gebeutelt. Auch in deutschen Fitness studios ist die Personalsituation der zeit angespannt wie nie zuvor. Wie kann es Studiobetreibern gelingen, Mitarbeiter an ihr Unternehmen zu bin den, trotz einiger Hindernisse wie z. B. niedrigerer Löhne und unattraktiver Arbeitszeiten?
René Grendel: Der besonderen Her ausforderungen in der Vergangenheit als auch aktuell, insbesondere in der Fitnessbranche, bin ich mir vollkommen bewusst. Lassen Sie mich dennoch mit Gegenfragen antworten: Sprechen wir tatsächlich von Hindernissen? Sind die Löhne tatsächlich niedriger? Im Ver gleich zu welchen Berufsgruppen? Und wenn ja, warum ist das so und muss das so bleiben? Ohne zu sehr ins Detail gehen zu wollen: Es gibt über 100 legale Möglichkeiten, die Lohnbestandteile zu optimieren. Davon profitieren Ar beitnehmer und Arbeitgeber zugleich! Gerade in der aktuellen Zeit können und sollten Arbeitgeber diese sinnvoll nutzen, Zeichen setzen und mit dem richtigen Arbeitgebermarketing die emotionale Mitarbeiterbindung massiv erhöhen.
Arbeitszeiten: Sind diese tatsächlich so unattraktiv? Warum betrachten wir es nicht einmal entgegengesetzt? Die Fitnessbranche bietet Arbeitnehmern den Vorteil, eben nicht Nine-to-Five arbeiten zu müssen, sondern erlaubt maximale Flexibilität bei den Arbeits zeiten. Das hört sich doch schon viel besser an, oder? Flexibilität im
Wie Sie Top-Fachkräfte binden können und so das Wachstum beschleunigen können, erfahren Sie im Buch von René Grendel mit dem Titel „Mitarbeiterbin dung – die Superkraft“.
www.buch-rene-grendel.de
die die nicht normalen Arbeitszeiten sehr schätzen und als Vorteil sehen, also lassen Sie uns das auch als posi tives Merkmal hervorheben.
BODYMEDIA: Welche Formen der Mitarbeiterbindung gibt es? Welche Maßnahmen haben sich in der Praxis bewährt?
René Grendel: Grundsätzlich lässt sich die Mitarbeiterbindung in vier ver schiedene Bereiche aufteilen. Rationale Mitarbeiterbindung: Mitarbeiter erhal ten mit Geld bewertbare Leistungen.
Normative Mitarbeiterbindung: Mitar beiter verspüren die moralische Ver pflichtung, für Sie und Ihr Unternehmen zu arbeiten. Sie wissen, wie wichtig sie für Ihr Unternehmen sind, und sind gleichzeitig dankbar, bei Ihnen sein zu dürfen. Perspektivische Mitarbeiterbin dung: Mitarbeiter sehen, dass sie in Ih rem Unternehmen aufsteigen und sich weiterbilden können. Emotionale Mitar beiterbindung: Mitarbeiter identifizieren sich besonders stark mit Ihrem Unter nehmen und den Zielen und Werten.
Ein Mix aus normativer, perspektivi scher und emotionaler Mitarbeiterbin dung ist das wichtigste Mitarbeiter bindungsinstrument, bei gleichzeitig für beide Seiten zufriedenstellender Vergütung. Dennoch habe ich einen persönlichen Favoriten: die emotio nale Mitarbeiterbindung. Nicht unbe gründet, denn emotional gebundene Mitarbeiter zeigen hohe Eigeninitia tive und bringen viele Ideen ein, sind
seltener krank, kündigen nicht bei fi nanziell besseren Angeboten und zei gen hohes Engagement in Bezug auf die Unternehmensziele. Mitarbeiter emotional zu halten bzw. zu binden kostet im Vergleich zu den anderen Bindungsarten wenig Geld; die ver meintlich einfachste Variante, jedoch in der Praxis die oftmals schwierigste. Die eine Maßnahme gibt es nicht, ein Zusammenspiel vieler einzelner Bau steine macht Arbeitgeber noch erfolg reicher. Einige Ideen sind:
• offene und ehrliche Kommunikation
• Feedbackkultur, Probleme ernst nehmen
• Interesse an den Mitarbeitern zeigen
• Wertschätzung / wertschätzen des Miteinander
• Verantwortungen übertragen/ „abgeben“ können
• Eigenverantwortung fördern und fordern
• Fortbildungen/Weiterbildungen anbieten
• Karrierechancen/Perspektiven konkret aufzeigen
• Weiterentwicklungswünsche erfragen
Die Themen gehen im Tagesgeschäft oftmals unter und es ist nicht immer Zeit dafür, insbesondere bei Personal mangel. Auch fällt es den Gesprächs partnern teilweise schwer, wirklich offen zu kommunizieren. Die Charak tere sind unterschiedlich ausgeprägt, das ist völlig normal und auch gut so! Daher ist es sehr wichtig, eine interne digitale Kommunikationsplattform zur
Verfügung zu stellen und regelmäßig den Status quo mit gezielten Formulie rungen zu erfragen.
BODYMEDIA: Sollten Führungskräfte das Thema Mitarbeiterbindung als Arbeitsprozess verstehen? Wenn ja, welche Aufgaben, Herausforderun gen und Investments erfordert dieser Prozess?
René Grendel: Ja, unbedingt. Mitar beiterbindung ist ein Entwicklungspro zess, sowohl für Mitarbeiter als auch Arbeitgeber. Der Vergleich mit einem Fitnesstraining passt hervorragend, es wird ein Trainingsplan erstellt, der sich sukzessive steigert, um dann den Wunsch-Fitness-Zustand zu erreichen. Und auch dann ist es wichtig: dran blei ben, um das Fitness-Level zu halten. Übertragen auf die Mitarbeiterbindung bedeutet das, eine konzeptionelle Vor gehensweise ist unbedingt erforderlich, damit gut gemeinte Maßnahmen nicht ins Leere laufen oder sogar kontrapro duktiv sind. Mitarbeiterbindung ist Chef sache, d. h. diese muss auch von ganz oben und allen Führungskräften gelebt und unterstützt werden. Die Heraus forderung aus Arbeitgebersicht ist, die richtigen und für die Belegschaft pas senden Benefits herauszufiltern. Der Markt ist diesbezüglich sehr unüber sichtlich, da es nahezu nur sogenannte Einprodukt-Lösungen gibt. Das Kon zept Mitarbeitermagnet® und seine Vor gehensweise haben sich in der Praxis als enorm hilfreich erwiesen. Das Gute aus Arbeitgebersicht: Es sind haupt sächlich nicht monetäre Anreize, die relevant sind. Ich vertrete die Meinung, dass einem Arbeitgeber ein Mitarbei ter mindestens 10 15 %, gemessen

am Bruttogehalt, mit Zusatzleistungen wert sein muss. Berücksichtigt werden hierbei direkte und indirekte monetäre Leistungen.
BODYMEDIA: Kann man erkennen, wenn Mitarbeiter mit dem Gedanken spielen zu kündigen? Falls ja, was gilt es zu tun, um dies verhindern zu können? René Grendel: Das ist aktuell eine nicht zu unterschätzende Gefahr, in den USA auch „Great Resignation“ oder „Big Quit“ genannt. In Deutschland wol

oder durch die bereits genannten re gelmäßigen digitalen Befragungen. Regelmäßig bedeutet hier konkret: alle vier Wochen. Natürlich nicht im Um fang eines Reflexionsgespräches, son dern gezielte sieben Fragen (inkl. zwei Skalierungsfragen), aus deren Beant wortung sich das Stimmungsbild und konkreter Handlungsbedarf ableiten lassen. Dieser Handlungsbedarf, der bestenfalls auch positive Stimmungs bilder beinhaltet, muss umgehend be arbeitet, hinterfragt und kommuniziert
oder „Quiet Quitting“ die Rede. Zwei unterschiedliche Vorgehensweisen von Arbeitnehmern, bei der letzteren bleibt der Mitarbeiter im Unternehmen, der Schaden ist jedoch umso höher:
• Mitarbeiter übernimmt keine Verantwortung mehr
• Qualität der Arbeit sinkt
• Leistung lässt nach, erst margi nal, dann immer deutlicher
• Man kann sich nicht mehr auf den Mitarbeiter verlassen
• Pausen werden länger und länger
• Kritik und disziplinarische Maßnahmen werden teilnahmslos hingenommen
• Keine eigenen Ideen oder Vorschläge mehr
• Keine Bereitschaft mehr, Überstunden zu machen und für Kollegen einzuspringen
Eine sehr große Gefahr, denn das Verhalten färbt auf Kollegen ab und die Leistungsbereitschaft und Stim mung des gesamten Teams leiden. Bei einer derartigen Konstellation besteht dringender und sofortiger Handlungsbedarf!
BODYMEDIA: Was können Füh rungskräfte und Unternehmer allge mein tun, um ein positives Arbeitsklima zu schaffen?
René Grendel: Bei allen bereits auf geführten Vorschlägen und Ideen, die Sie von mir erhalten, ist eines enorm wichtig: Seien und bleiben Sie bei al lem, was Sie machen, authentisch. Ein Mitarbeiter merkt sofort, wenn Verän derungsprozesse nicht aus Überzeu gung angestoßen werden. Fragen Sie die Mitarbeiter, was sie beschäftigt und ihnen wichtig ist.
len einer aktuellen Studie zufolge 17 % der Arbeitnehmer ihren Job kündigen. Weitere 31 %, und das ist erschre ckend, wären nicht abgeneigt, sollte sich eine Gelegenheit ergeben. Haupt gründe hierfür sind mehr Flexibilität bei der Wahl des Wohnorts, interessantere Arbeitsinhalte, Sinn in der Tätigkeit, Unternehmenskultur, individuelle Ent faltungsmöglichkeiten, Weiterentwick lungsmöglichkeiten und flexiblere Ar beitszeiten. Um Kündigungsgedanken zu erkennen, ist lediglich eines erfor derlich: Kommunikation! Sei es direkt
werden. Entsprechende Maßnahmen bzw. Weiterentwicklungen, auf jeden Fall deren Kommunikation, müssen ebenfalls zeitnah erfolgen. So fühlen sich die Mitarbeiter ernst genommen und spüren, dass ihre Meinung der Geschäftsleitung wichtig ist und auch Veränderungsprozesse angestoßen werden. So ziehen final alle an einem Strang. Emotionale Mitarbeiterbindung par excellence. Ergänzend ein kleiner Exkurs: Wenn wir über „Great Resig nation“ oder „Big Quit“ sprechen, ist auch oft von der inneren Kündigung
BODYMEDIA: Die Ansprüche seitens der Arbeitnehmer sind im Vergleich zu früher gestiegen. Welche Kriterien muss ein Unternehmen heute erfül len, um als attraktiver Arbeitgeber zu gelten?
René Grendel: Durch die Pandemie haben sich viele Arbeitnehmer mit The men auseinandergesetzt, die vorher als selbstverständlich hingenommen wurden. Die Work-Life-Balance hat mehr an Bedeutung gewonnen. Geld ist nicht mehr alles, insbesondere bei den Generationen Y und Z. Wichtig ist, sich auf die Mitarbeiter, die Zielgruppe
Mitarbeiter emotional zu halten bzw. zu binden kostet im Vergleich zu den anderen Bindungsarten wenig Geld
einzustellen. Auch hier gibt es keine einheitliche Lösung für alle Arbeitgeber, maßgeblich für ein individuelles Kon zept sind die Branche des Unterneh mens, die Altersstruktur des Unterneh mens, der geografische Standort des Unternehmens, die Art der Tätigkeiten der Belegschaft und die Wünsche der Belegschaft. Was jedoch inzwischen nahezu alle Mitarbeiter eint, ist der Wunsch nach einer, nach eigener De finition, sinnvollen Tätigkeit, sprich ein Arbeitgeber sollte diese sinnvolle Tätig keit zur Verfügung stellen.
BODYMEDIA: Was zeichnet gute Mit arbeiterbindung aus?

René Grendel: Dass sie ernst ge meint ist und vorgelebt wird.
BODYMEDIA: Inwiefern zahlt es sich für Unternehmen aus, die in Mitarbeiterbindung investieren?
René Grendel: Das ist eine einfache Rechenaufgabe: Eine Neueinstellung kostet gut 30 % eines Jahresgehaltes der zu besetzenden Stelle, mit externen Beratern sogar gut 50 %. Hinzu kom men sogenannte versteckte Kosten. Bei der Übergabe eines Aufgabenbe reichs und Einarbeitung müssen zwei Mitarbeiter gleichzeitig an derselben Aufgabe arbeiten. Und interne Prozesse müssen erst erlernt und kennengelernt werden, sodass die Effizienz am Anfang nicht vollständig gegeben ist. Nicht messbar sind z. B. Überlastung der Be legschaft, die Arbeit auffangen muss, sowie Qualitäts- und Reputationsverlust, wenn die Stelle nicht direkt neu besetzt werden kann. Diese Kosten sind somit um ein Vielfaches teurer als Mitarbeiterbindungsmaßnahmen.
BODYMEDIA: Der „war for talents“ ist in aller Munde. Wie werden sich der Arbeitsmarkt und die Arbeitswelt Ihrer Meinung nach in den nächsten Jahren entwickeln? Worauf müssen sich Unternehmer und Führungskräfte einstellen und welchen Stellenwert wird das Thema Mitarbeiterbindung einnehmen?

René Grendel: Was wir aktuell erle ben hinsichtlich des „war for talents“, ist nur der Anfang, die Vorstufe. Allein 2022 werden über 300.000 Personen mehr in den Ruhestand gehen, als in den Arbeitsmarkt eintreten. Bis 2030 sind es kumuliert sogar 5 Millionen. Die Themen Recruiting und Mitarbeiter
bindung sind somit Dauerthemen von höchster Priorität, ich hatte es bereits erwähnt: Chefsache! Unabhängig da von werden sich der Arbeitsmarkt und die Arbeitswelt enorm verändern durch den Einfluss der künstlichen Intelligenz. Das Gute ist, wir wissen grundsätzlich schon sehr viel, d. h. wir können uns vorbereiten, müssen dies aber auch jetzt clever anstoßen. Ein passendes Zi tat von Darwin: „Es ist nicht die stärkste Spezies, die überlebt, auch nicht die in telligenteste, sondern diejenige, die am besten auf Veränderungen reagiert.“
Jedes Unternehmen benötigt Mitar beiter, die mit Freude und Leidenschaft ihren Beruf ausüben. Hier sind wir als Arbeitgeber gefragt, dieses Umfeld zu gestalten und die richtigen Mitarbeiter auszuwählen. Wo finden Sie Mitarbei ter, die den Job mit Leidenschaft aus üben? Einmal darüber nachgedacht, den Kundenbestand nach Trainingsan wesenheiten zu selektieren? Die Men schen, die am häufigsten vor Ort sind, würde ich direkt ansprechen. Wir müs sen uns dem Wandel stellen und, so schwierig das jetzt klingen mag, diese Veränderungen als Chance sehen und nutzen.
BODYMEDIA: Vielen Dank für das Interview.
René Grendel hat sich sehr jung selbst ständig gemacht und sich auf das Thema Mitarbeiterversorgung und Be triebsrenten als einen Baustein der Mit arbeiterbindung spezialisiert. In seiner inzwischen über 26-jährigen Berufser fahrung mit zahlreichen Auszeichnungen und über 5.000 Mitarbeitergesprächen konnte er einen umfassenden Eindruck von der Motivation und den Bedürf nissen von Mitarbeitern gewinnen. Er hilft Arbeitgebern mit dem Mitarbeiter magnet® dabei, die Top-A-Mitarbeiter noch stärker an das Unternehmen zu binden und so vor Abwerbungsversu chen und einem möglichen Verlust von Firmen-Know-how zu schützen. www.rene-grendel.de












Die Fitnessbranche oder zumindest das Arbeiten im Fitnessclub stand schon immer unter besonderen Voraussetzungen. Anfangs als Hobby abgetan, dann als Job für Enthusiasten, hat sich zumindest das Qualitätssegment der Branche immer weiter zum professionellen Dienstleister entwickelt, mit all seinen Vor- und Nachteilen für den Arbeitnehmer.

Durch den grundsätzlichen Arbeits kräftemangel in fast allen Branchen, die Coronakrise und ständig steigen der Inflation wird es in der Dienstleis tungs- und damit auch in der Fitnessbranche immer schwerer, gute Mit arbeiter zu finden und diese auch zu halten. Deshalb setzen in jüngster Zeit auch viele Unternehmen des Qualitäts segments auf einen hohen Grad der Automatisierung, um entweder Kosten
zu sparen und/oder um die benötig ten Arbeitsstunden überhaupt noch decken zu können. Im Low-BudgetBereich mag das funktionieren ‒ ob das jedoch der zielführende Weg für Premiumanlagen ist, kann angezwei felt werden. Denn bei Mc Donalds setzt man schon lange auf große Displays, die die Bestellung entgegennehmen und die Bezahlung abwickeln, und es wird auf jede Art der Personalisie
rung oder Individualisierung verzichtet. Wenn man aber ein hochwertiges Re staurant besucht, erwartet der Kunde, dass er begrüßt und zum Platz geführt wird, ein netter und kompetenter Kell ner die Tagesgerichte erklärt und zum gewählten Gericht noch den richtigen Wein empfiehlt.
Im Fitnessclub kommt erschwerend hinzu, dass die Kunden meist ihr ge
stecktes Zeil nicht erreichen, es fehlt also das Ergebnis. Ersatzweise binden kann man dann Kunden oftmals nur durch Erlebnisse. Aber für beides be nötigt man erfahrene, qualifizierte und hoch motivierte Mitarbeiter. Zumindest das Qualitätssegment wird sich hierzu folglich Gedanken machen müssen, wie es höhere Preise rechtfertigen will.
Formen der Mitarbeiterbindung kön nen die perspektivische, normative, emotionale und rationale Bindung sein.
Die perspektivische Bindung, also die Möglichkeit des beruflichen Auf stieges, der Weiterbildung und der Übernahme von Verantwortung, mag zunächst aufgrund der meist flachen Hierarchien innerhalb eines Fitness studios als schwierig erscheinen. Allerdings beginnt es hier bereits beim Auszubildenden oder Studenten. Junge Menschen merken sehr schnell durch ihre Vernetzung und spätestens beim Austausch mit anderen Kolle gen an der Schule oder Uni, ob sie im Ausbildungsbetrieb lediglich als günstige Arbeitskraft eingestellt wur den und in den ersten Monaten oder gar Jahren den Theken- und Geräte bereich sauber halten sollen oder ob sie in ihrem Club von Anfang an durch eine gut strukturierte Einarbeitung und zusätzliche Fortbildungsmaßnahmen über die Berufsschule hinaus schnell für andere Arbeitsbereiche und Ein satzgebiete vorbereitet werden. Durch diese Vorleistung wird dem jungen frischen Mitarbeiter schnell klar, dass es dem Betrieb wichtig ist, Auszubil dende über die reine Lehrzeit hinaus an das Unternehmen zu binden und zu übernehmen.

Der Grad der Automatisierung in ei nem Club taucht nun ein weiteres Mal auf. Denn obwohl z. B. vollelektroni sche Trainingslösungen, virtuelle und digitale Angebote ihre absolute Sinn haftigkeit und Berechtigung haben, muss man sich Gedanken machen, was darüber hinaus dem Kunden als individualisierte Lösungen durch gut qualifizierte Mitarbeiter angeboten wird. Keine Fachkraft wird auf Dauer 50 % oder mehr ihrer Arbeitszeit mit immer wieder gleichen und stupiden Tätigkeiten füllen wollen. Denn nur wenn hochwertige und individual-
isierte Leistungen das Angebot ergän zen, machen weiterführende und ver tiefende Ausbildungen Sinn.
Normative Bindung Unter normativer Bindung versteht man, dass das Unternehmen und das gesamte Team und damit jeder einzelne Mitarbeiter mit gemeinsamen Zielen und Werten arbeiten. Der ge genseitige Mehrwert muss erkennbar sein und das Unternehmen braucht eine klare Zukunftsvision.
zunächst überhaupt existieren und er arbeitet werden. Damit sie dann aber nicht auf einem Stück Papier in der Ablage verschwindet, muss sie von möglichst vielen Mitarbeitern mitgetra gen werden. Das wird erreicht, indem man viele oder am besten alle Mitarbei ter in den Gestaltungsprozess einbin det. Durch diese Einbindung steigen die Identifikation und die Verbun denheit mit dem Unternehmen. Nun müssen die Ziele und Werte regelmä ßiger Bestandteil der Kommunikation
Ganz abgesehen davon, dass die genannten Punkte für den wirtschaft lichen Erfolg eines Unternehmens elementar wichtig sind, arbeiten viele Unternehmer mit ihren Mitarbeitern zwar ständig im Unternehmen, aber nicht am Unternehmen. Eine Unternehmensvision mit den daraus ab geleiteten Zielen und Werten muss
werden. Beginnend im Einstellungsprozess, denn damit weiß jeder von Anfang an, auf was er sich mit diesem Arbeitsplatz einlässt und ob er ein langfristiger Teil des Systems werden möchte. In fortlaufenden Meetings muss immer wieder über Vision, Ziele und Werte gesprochen werden, zum einen, um jeden, der nicht an
Ein Paradebeispiel in Sachen Mitarbeiterbindung ist die HARDY’S Unternehmensgruppe, wie die folgenden Fakten beweisen:
• Mitarbeiterfluktuation unter 7 %
• Jährlich rund 100 Initiativbewerbungen pro Studio
• Der durchschnittliche Bruttostundenlohn inklusive Provision (ohne Führungskräfte) liegt bei 18,23 Euro. Das entspricht bei einer 40-Stunden-Woche einem Bruttogehalt von 3.150 Euro.
Die emotionale Bindung ist in der Arbeitswelt genau wie in zahlreichen anderen Lebensbereichen viel stärker ausgeprägt und wichtiger als die rationale Bindung
der Gestaltung direkt beteiligt war, ins Boot zu holen, zum anderen, um alle Teammitglieder immer wieder an das gemeinsam Erarbeitete zu erin nern. Das Unternehmen hat nun ei nen klar kommunizierten Kompass, an dem sich alles Handeln und auch alle Entscheidungen orientieren. Die Steuerung des Unternehmens ist somit für jeden ein Stück weit beein flussbar und auf jeden Fall immer klar nachvollziehbar.
Die emotionale Bindung ist in der Ar beitswelt genau wie in zahlreichen anderen Lebensbereichen viel stärker ausgeprägt und wichtiger als die ra tionale Bindung. Empfinde ich meine Arbeit als sinnstiftend, empfange ich dafür Wertschätzung und besteht eine
gute Beziehung zu Kollegen, zu den Führungskräften, zum Chef?
Hier könnte der Fitnessclub als Arbeit geber leicht punkten und trotzdem werden oftmals Möglichkeiten und Chancen nicht genutzt. Denn viele junge Menschen beginnen aus Ent husiasmus und Leidenschaft heraus die Ausbildung in einem Fitnessclub und müssen dann nach kurzer Zeit frustriert feststellen, dass sie Tag für Tag Neukunden an standardisierten Gerätesystemen einweisen müssen und die Kunden häufig kein zweites Mal mehr treffen. Noch einmal muss betont werden, dass standardisierte Lösungen für Kunden eine durchaus sinnvolle Ergänzung oder einen einfa chen Trainingseinstieg darstellen kön nen. Aber es gibt natürlich zahlreiche
Mitglieder, die darüber hinaus hochin dividuelle Varianten ausprobieren und nutzen wollen. Mitglieder scheitern meist nicht am falschen Training bzw. Trainingssystem, sondern am fehlen den Reiz und an der Regelmäßigkeit des Trainings. Die beiden letztgenann ten Faktoren für ein erfolgreiches Trai ning kann nur ein Mitarbeiter liefern. Diese Möglichkeit muss dem Kunden und dem Mitarbeiter gegeben wer den. Über betreutes Gruppentraining, Groupfitness, Workshops, Personal Training, Rehasport und Präventions kurse werden Mitglieder erfolgreich. Für motivierte und erfahrene Trainer stellt sich nun Sinnhaftigkeit ein, weil sie endlich Mitglieder auf dem Weg zum Trainingserfolg begleiten können. Die gebührende Wertschätzung ist nun eine logische und nicht zu ver

hindernde Folge. Erfolgreiche Kunden sprechen darüber, empfehlen ihren Club und ihren Trainer.
Neben der Wertschätzung der Kunden sind für Mitarbeiter kleine Aufmerk samkeiten vonseiten des Arbeitge bers aber ebenso entscheidend. Lobgespräche, Herzlichkeitsgeschenke, regelmäßige Teamevents oder Weih nachtsfeiern, die über ein langweiliges Abendessen hinausgehen und einen wirklichen Incentive-Charakter haben. Vor allem müssen große, aber auch kleine Erfolge gefeiert werden.
Viele der bereits angeschnittenen Themen münden automatisch in der rationalen Bindung eines Mitarbei ters. Denn wenn der Arbeitgeber alle Bindungsmöglichkeiten nutzt, ist es nun kein Problem mehr, flexible Ar beitszeitmodelle, transparente Bonussysteme und betriebliche Altersvor sorge anzubieten. Die 40-StundenWoche muss nicht der Standard sein. Gerade die Generation Z will eine
Auszeit nehmen und etwas von der Welt sehen. Über Sabbatical-Modelle öffnet der Betrieb diese Möglichkei ten und macht sie somit vielleicht überhaupt erst wirtschaftlich umsetz bar. Wenn Trainer ihre Stunden nicht nur nach betrieblichen Bedürfnissen abarbeiten müssen, sondern z. B. über Personal Training mit jeder ge leisteten Stunde hohe Zusatzumsätze generieren, dann kann es dem Betrieb egal sein, wann diese Stunden geleis tet werden. Gut gebuchte Personal Trainer, die in 50 % oder mehr ihrer Arbeitszeit für hohe Renditen sorgen, können damit auch einen großen Teil ihrer Arbeitszeit mitbestimmen und gestalten. Über Bonussysteme wie Provisionen für Mitgliedschaftsverkauf, Personal Training oder Zusatzvergü tung für hochwertige Arbeitsinhalte wie Kursstunden können Stunden löhne von 25‒50 Euro brutto reali siert werden. Jedem Fitnessclub und auch jedem Mitarbeiter muss klar sein, dass man nicht schlechten Mit arbeitern möglichst geringe Löhne zahlen will, sondern den besten


Mitarbeitern Top-Gehälter ausschüt ten möchte. In Vollanstellung sind für normale Mitarbeiter ohne Führungs verantwortung Monatsgehälter von 3.500‒4.500 Euro brutto leicht dar stellbar, aber der Arbeitgeber muss die Voraussetzung dafür schaffen. Wenn dann zusätzlich Ziele, Zahlen und Ergebnisse regelmäßig transpa rent kommuniziert werden, erzeugt man Sog statt Druck und gewinnt ein Team von Leistungsträgern und High-Performern.

Florian Möger ist Dipl.-Kaufmann und Teil der Geschäftsführung der HARDY’S Fitnessclubs. Zudem ist er ACISO-Coach für Personal-TrainingKonzepte und Vertrieb.

Wir helfen Ihnen dabei, neue Kunden zu akquirieren, Umsatz zu steigern und Ihre Kunden bindung zu stärken. Mit den InBody-Konzepten bieten Sie Ihren Trainern und Mitgliedern ein präzises und innovatives Analysesystem und festigen Ihren Status als Gesundheitsexperte. Für mehr Anerkennung und eine höhere Sichtbarkeit. Für mehr Mitglieder und einen höheren Umsatz.
In drei Schritten zum wirtschaftlichen Erfolg
Durch eine InBody-Messung beim Walk-in steigt Ihre Konvertierungsrate spürbar. Ein qualifizierter Check-up mit unserer medizinisch zertifizierten Hardware bietet die optimale Grundla ge zur Sensibilisierung der Interessen ten für ihre individuellen Gesundheits risiken und Defizite. Mit professioneller Eingangsanalyse und individueller Be darfsermittlung lassen sich individuelle Maßnahmen aus den Leistungen Ihrer Einrichtung zusammenstellen. Das Er gebnis: mehr Mitgliedschaften.

Durch die befundbasierte Bedarfser mittlung lassen sich Zusatzleistungen, wie Personal Training, Ernährungsbe ratung und Abnehmprogramme, effizi enter vermitteln. Erhöhen Sie den The kenumsatz, indem Sie Ihre Mitglieder über den Zusammenhang zwischen dem Muskelaufbau und dem Protein

bedarf aufklären und individuelle Defi zite mit dem InBody-Befundbogen be legen. Das Ergebnis: höherer Umsatz.
Mit regelmäßigen Re-Check-ups ver buchen Ihre Kunden belegbare Erfolge, die zum Fortführen und Aufrechterhal ten motivieren. Durch die professionelle Betreuung stärken Sie die Loyalität zu Ihrer Einrichtung. Ihre Mitglieder tolerie ren höhere Beiträge für eine Dienstleis tung mit einem höheren Ausstattungs-, Service- und Kompetenzniveau und sind resistenter gegenüber kostengüns tigeren Wettbewerbsangeboten. Das Ergebnis: niedrigere Kündigungsrate.
Jede gute Dienstleistung beginnt mit einem präzisen Check-up. Nur diese genaue Analyse der Ist-Situation er möglicht es Ihnen, effektive und sinn volle Trainingsempfehlungen zu geben und Trainingserfolge klar zu kontrollie ren. Fehlt die exakte Analyse, basiert Ihre Beratung auf Schätzungen und ist nicht so nachhaltig und effektiv. In
Kombination mit unseren medizinisch zertifizierten Körperanalysegeräten und digitalen Lösungen positionieren Sie sich als moderne Gesundheitseinrich tung der nächsten Generation.
Über 4.000 Gesundheitseinrichtungen in Deutschland haben wir mit unseren Konzepten auf ihrem Weg zum Erfolg begleitet. Möchten Sie ein Teil unserer Erfolgsgeschichte sein? Dann freuen wir uns über Ihre Kontaktaufnahme. Jetzt den QR-Code scannen und Ih ren persönlichen Beratungstermin vereinbaren. Kontakt
InBody Europe B. V. Niederlassung Deutschland
Mergenthalerallee 15–21 65760 Eschborn Tel. +49 (0) 6196 / 7691662 E-Mail: erfolg@InBody.com Web: www.InBody.com


 Weitere Artikel und News auf bodymedia.de
Weitere Artikel und News auf bodymedia.de
Derzeit häufen sich immer mehr die Aussagen von Inhabern, Geschäftsführern und Be reichsleitern, die schon seit Monaten neue Mitarbeiter suchen und niemanden finden. Ist es denn wirklich nahezu unmöglich geworden, die richtigen Mitarbeiter zu finden? Dieser Artikel gibt Einblicke und Tipps, wie Studiobetreiber motivierte Mitarbeiter für ihr Fitnessund Gesundheitsunternehmen finden können.
In zahlreichen anderen Branchen wird häufig das Thema des Fachkräfteman gels aufgeführt. Leider ist das oftmals eine gern benutzte Ausrede. In einer Studie von Manpower (Studie über Fachkräftemangel) nannten die be fragten Unternehmen ihre wichtigsten Gründe für den Fachkräftemangel. Diese lauten:
• 35 % zu wenig oder keine Bewerber
• 34 % unzureichende Fachkenntnisse
• 22 % fehlende Erfahrung
• 17 % fehlende soziale Kompetenz
• 13 % Bewerber fordert zu viel Gehalt und zu viel Freizeit
Falsche Suche, keine Bewerber
Viele Fitnessunternehmen klagen über insgesamt zu wenig Bewerber. Allerdings stellt sich auch die Frage, auf welchem Weg sie nach ihren Wunsch kandidaten suchen. Ein Großteil in seriert noch immer im Stellenteil der (regionalen) Zeitung. Häufig wird zu dem parallel mit einer Online-Anzeige

5 Minuten Feedbackgespräche in der Woche können helfen, eine gute Stimmung im Unternehmen beizubehalten
geworben, die allerdings nur eine PDF-Variante der Printanzeige ist. Da durch sieht der Stellenmarkt in den verschiedenen Medien jede Woche gleich aus: Stellenanzeigen in vorge gebenen Formaten enthalten zumeist Standardtexte wie z. B.: „Wir sind ei ner der Fitnessmarktführer und su chen Verstärkung für unser Team. Unser Wunschkandidat soll vor allem teamfähig, flexibel und belastbar sein. Soziale Kompetenz und gute Kommu nikationsfähigkeit setzen wir voraus. Senden Sie uns bitte Ihre aussagekräf tige Bewerbung.“
Dann wird nur noch der Name des Unternehmens eingesetzt, eine Liste mit mindestens 15–25 fachlichen An forderungen hinzugefügt und schon kann die Anzeige gedruckt werden. Falls zu wenige Bewerbungen beim jeweiligen Studio eintreffen, wird die Anzeige einfach noch mal durch Farbe oder Größe hervorgehoben. Diese Art von Stellenanzeigen bieten dem po tenziellen Kandidaten wenig konkrete Informationen und vor allem wenig Anreiz, darauf einzugehen.
Um eine Stellenanzeige richtig zu ge stalten, ist es wichtig, dass die Ziel gruppe sich angesprochen fühlt. Ganz
nach dem Motto „Der Köder muss dem Fisch schmecken, nicht dem Angler“. Jede Werbung sollte mit einer sprachlichen Wirkung gestaltet wer den. Das lässt sich auch für Stellenin serate nutzen, denn die Anzeigen sind vor allem Werbung. Werbung für Ihr Unternehmen, Werbung für einen Ar beitsplatz. Es ist durchaus sinnvoll, da für einen Textprofi zu beauftragen. Am besten mit einem Texter, der Profi im Verkauf ist. Denn genau das ist es. Sie wollen Ihr Unternehmen „verkaufen“, sodass ein Interessent bereit ist, die ses Angebot dann auch zu „kaufen“.
Möglichkeiten, Mitarbeiter zu finden
Für Fitness- und Gesundheitsunter nehmen bieten sich mehrere Möglich keiten an, um geeignete Mitarbeiter zu finden. Folgende Punkte sind dabei zu empfehlen:

• Aktiv einen Pool mit Wunschkan didaten aufbauen
• Empfehlungsprogramme im Unternehmen implementieren
• Kooperationen mit anderen Unternehmen aufbauen
• Neue Zielgruppen ausfindig machen (Personen aus anderen Bereichen ansprechen)
• Talente über die Ausschreibung eines Wettbewerbs oder Awards ansprechen
• Ansprechende Botschaften veröffentlichen
• Sich als Unternehmen beim Wunschkandidaten bewerben
• Umständliche Bewerbungstools ausschalten und möglichst früh persönlich mit den Wunsch kandidaten kommunizieren
• Kunden im Studio darauf anspre chen, dass für einen wichtigen Bereich ein neuer Mitarbeiter gesucht wird.
Mitarbeiter zu halten lohnt sich Der günstigste Weg, um Ihre Stellen zu besetzen, ist Mitarbeiter zu halten und wenn es geht, an Ihr Unternehmen langfristig zu binden. Für jeden Mitar beiter, der nicht kündigt, müssen Sie keinen Ersatz finden. Schaffen Sie ein Arbeitsklima, in dem sich Ihre Beschäf tigten wohlfühlen. Bieten Sie Ihnen Entwicklungschancen. Sprechen Sie mit solchen, die unzufrieden sind, und suchen Sie nach Lösungen.
Wie gelingt es, Mitarbeiter zu halten?
Die ersten Maßnahmen drehen sich um das Thema Onboarding und Probezeit
von Mitarbeitern. Onboarding ist ein Begriff aus dem Personalmanagement. Er bezeichnet das Einstellen und die Aufnahme neuer Mitarbeiter durch ein Unternehmen und vor allem alle Maß nahmen, welche die Eingliederung fördern.

Wiki-Seite erstellen, in der alle wich tigen Informationen aufgeschrieben werden, die für Sie von Interesse sind und die Sie gerne wissen möchten. Clubbetreiber sollten Wert darauf le gen, dass die Mitarbeiter diese Seite immer weiter vervollständigen und mit
beitern. Eventuell ist auch einmal die Woche ein gemeinsames Mittagessen möglich. Dort lassen sich oftmals viele schwierige Themen besprechen und beheben.
1. Arbeiten Sie mit Erwartungslisten Gehen Sie eine Liste mit klaren Erwar tungen und Zielen mit Ihrem Mitarbei ter durch. Es sollten Termine festgelegt werden, z. B. alle 4 Wochen, 3 Monate oder 6 Monate, bei denen die Punkte der Liste besprochen werden. Wichtig: Verteilen Sie Lob und sprechen Sie auch deutlich an, welche Erwartungen nicht erfüllt wurden, und geben Sie ggf. Hilfestellungen, damit der Mitar beiter es besser machen kann.
2. Aushängen einer Art „Wiki-Seite“ Lassen Sie Ihre Mitarbeiter eine Art
wichtigen Informationen füllen. Sie als Unternehmer profitieren davon, dass sie irgendwann ein tolles Tool haben, in dem alles Wichtige und Wissens werte zum Unternehmen steht. Diese Liste sollte vom Betreiber oder einer Führungskraft regelmäßig gecheckt werden.
3. Regelmäßig Feedback einholen 5 Minuten Feedbackgespräche in der Woche können helfen, eine gute Stim mung im Unternehmen beizubehalten. Wenn es nicht vor Ort möglich ist, dann telefonieren Sie mit Ihren Mitar
4. Erstellen Sie ein Persönlichkeitsprofil von Ihrem Team Wussten Sie, dass die Veränderung mit dem Verstehen beginnt? Um den besten Weg zum Wohlbefinden der Mitarbeiter zu finden, müssen Sie wis sen, was diese eigentlich wollen. Hier für empfehle ich die Durchführung des HUCO Wellbeing Navigator. Dieser hilft Ihnen dabei, die Stärken Ihrer Mitarbeiter zu erkennen, sodass Sie letztlich davon profitieren können. Da rüber hinaus ermöglicht er, potenzielle Fallstricke zu entlarven und zeigt auf, welche Kommunikationsformen es zu vermeiden gilt, um Mitarbeiter nicht zu demotivieren. Wellbeing Navigator basiert auf einer dynamischen Befra gung, die online durchgeführt wird. Auf Basis der Befragung erstellt der Wellbeing Navigator dann einen vi suellen Bericht, der Ihnen ein umfas sendes Bild Ihrer Ausgangssituation
Der günstigste Weg, um Ihre Stellen zu besetzen, ist Mitarbeiter zu halten
vermittelt. Sie werden etwas Neues über die Gewohnheiten von sich und Ihren Mitarbeiter entdecken, die sich auf das Wohlbefinden von Ihnen auswirken.

5. Status aller Zahlen und Ziele regelmäßig sichtbar machen Durch das regelmäßige Teilen der wichtigsten Zahlen und Ziele des Un ternehmens mit Ihrem Mitarbeiterteam entsteht ein Sicherheitsgefühl bei Ihren Mitarbeitern und Sie verhindern das Entstehen von Gerüchten. Alter nativ kann auch einmal pro Monat ein Gesamtüberblick an die Mitarbeiter herausgegeben werden.
6. Für regelmäßige Weiterbildungsmaßnahmen sorgen Ambitionierte Mitarbeiter wollen sich kontinuierlich weiterentwickeln. Die sen Wunsch zu erfüllen bringt auch viel Mehrwert für das Unternehmen. Schließlich wird das neu erworbene Wissen direkt in die Praxis umgesetzt. Leider gibt es immer noch zu viele Un
ternehmen, in denen Weiterbildungs angebote eher die Ausnahme als die Regel sind. Als Führungspersönlich keit sollte man unbedingt regelmäßig die Weiterbildungswünsche im Team erkennen und fördern. Dafür eignen sich sowohl interne als auch externe Schulungen, Online-Workshops, We binare oder Videokurse, Bücher und Magazine. Tipp: Stellen Sie jedem Mit arbeiter ein festes Weiterbildungsbud get pro Jahr zur Verfügung, das dieser ganz nach seinen Wünschen einsetzen kann.



In der Fitness- und Gesundheits branche gibt es verschiedene Mitar beiterbindungsmaßnahmen, die sich bewährt haben. Dazu zählen der re gelmäßige Austausch mit den Mitar beitern und Feedback, die Erstellung und Umsetzung eines WellbeingNavigators, das Angebot regelmä ßiger Aus- und Weiterbildungen und Provisionsmodelle.
Vergessen Sie vor lauter Suche nach neuen Mitarbeitern nicht Ihr aktuelles Team. Versuchen Sie eher, dieses zu halten, denn jede Suche nach einem neuen Mitarbeiter ist deutlich teurer, als auf das bestehende Personal zu setzen.
Stephan Müller ist Vorstand des Bundesverbandes Personal Training (BPT e. V.). Der Inhaber des Glucker Kollegs betreut als PT und Ernäh rungsexperte zahlreiche Olympiasieger und Weltmeister. Zusätzlich ist der mehrfache Buchautor regelmäßig monatlich live als Experte bei ARD und SWR im Fernsehen und im Radio im Einsatz. www.gluckerkolleg.de

Fitness First soll „die motivierteste Kette und das digitals te Unternehmen der Fitnessbranche werden“. Nicht zum Selbstzweck, sondern um dank der Digitalisierung die Prozesse zu verschlanken, sodass die Mitarbeiter Zeit und Energie haben, sich wirklich um die Kunden zu kümmern. Fitness First mit seinem Deutschland-Geschäftsführer Jo hannes Maßen setzt deshalb voll auf das EGYM-Ökosystem: Nahezu alle der rund 60 Fitness-First-Clubs in Deutschland sind inzwischen mit EGYM-Equipment ausgestattet.
Johannes Maßen ist seit zwei Jahren Deutschland-Chef von Fitness First. Ihn treibt an: möglichst wenig Admi nistration für die Mitarbeiter. „Als Ers tes brauchst du schlanke Prozesse. Denn nur dann, wenn ein Mitarbei ter motiviert ist, kann er auch ande re Kunden motivieren.“ Also machte sich das Team von Fitness First dar an, die Prozesse im Club komplett zu verschlanken: „Und da kommt EGYM ins Spiel. Wir haben Geräte, die sich auf den Kunden einstellen, Trainings progression und Fortschrittsmessun gen, die von den Geräten selbststän dig und eigenständig vorgeschlagen werden.
Der Fitness-Hub gibt uns Hinweise da rüber, wo wir beim Kunden ansetzen. Über das Biologische Alter sehe ich ganz genau, wer wo Defizite hat. Die Trainingspläne in der EGYM Trainer
App sind für uns ein weiteres wertvol les Hilfsmittel. Es unterstützt unsere Mitarbeiter dabei, noch individueller auf unsere Kunden einzugehen.“ Zwei ter wichtiger Punkt für Johannes: „Er folge müssen messbar sein!“ Die Digi talisierung sei hierzu Mittel zum Zweck – „und dazu ist EGYM der perfekte Partner für uns!“
In nahezu allen der rund 60 deutschen Fitness-First-Clubs sind neben dem EGYM-Fitness-Hub und den EGYMSmart-Strength-Geräten auch die Branded-Member-App und die Trai ner-App im Einsatz. Johannes Maßen: „Das bietet ein perfektes Ökosystem und entlastet unsere Mitarbeiter, so dass sie genau die Zeit haben, sich um die Kunden zu kümmern und sie bei ihren Trainingsfortschritten zu un terstützen. Meiner Ansicht nach ist das wirklich genial!“

„Wir motivieren die Leute, den inneren Schweinehund zu be siegen und die Vorteile von regelmäßigem Training zu erle ben. Wenn der Kunde sich bei uns wohlfühlt, eine gute Zeit hat und Spaß hat, dann kommt er auch wieder. EGYM ist ein su per Werkzeug für uns, um das zu erreichen.“ Sehen Sie im Video, wie Fitness First vom EGYM-Ökosystem profitiert:
EGYM GmbH
Einsteinstraße 172 81677 München
Tel. +49 (0) 89 / 9213105100
E-Mail: sales@egym.com Web: www.egym.com

Die Körperanalyse aus der Welt der Medizin jetzt in Deinem Studio. Bestimme die Muskelmasse, Fettmasse und viele weitere Parameter und hilf Deinen Mitgliedern ihr gesünderes Selbst zu entdecken.

secaTRU.com
Jetzt Termin vereinbaren
DIE BIA FÜR MEDICAL FITNESS.Der Arbeitsmarkt hat sich in den vergangenen Jahren drastisch verändert. Gutes Personal zu finden, wird immer schwieriger. Nicht umsonst ist die Rede vom „War of Talents“. Umso wichtiger ist es für Unternehmen, ihr Personal langfristig zu binden. Wir haben nachgefragt, welchen Stellenwert Mitarbeiterbindung in der Fitnessbranche hat und wie sie praktiziert wird.


„Ich bin dankbar für jeden einzelnen Mitarbeiter, der sich auf eine gemeinsame berufliche Zeit mit mir einlässt. Zu einer langfristigen Mitarbeiterbindung gehört, vor allem am Anfang, eine wertige Inte gration. Vertrauen bilden, Druck nehmen und vor allem Augenhöhe bieten. Nicht jeder kann damit umgehen, aber die, die es schaffen und genießen, werden wichtig im Unternehmen. Es ist entschei dend, Verantwortung zu übergeben und klar zu kommunizieren. Reine Befehlsempfänger schalten ab und blockieren langfristig. Wer sich einbringen möchte und somit dem Unternehmen guttut, braucht Vertrauen und Verantwortung. Alle entscheidenden Perso nen sind bei uns schon lange im Unternehmen, sie wissen oft mehr als ich. Sie spüren Vertrauen und ich verlasse mich auf sie, ihr ver antwortungsvolles Tun und ihr Wort. Das ist mein entscheidender Punkt für langfristige Mitarbeiterbindung.“

„Wir haben unsere Unternehmenswerte gemeinsam und de mokratisch mit allen Mitarbeitern entwickelt und diese Werte sind auch fester Bestandteil jeder Form von Kommunikation im Arbeitsalltag. Dazu gehört auch eine konsequent eingeforderte Feedbackkultur in alle Richtungen. Weiterhin ist es nach unse rem Verständnis wichtig, die Mitarbeiter in die Entscheidungs prozesse und die Unternehmensentwicklung mit einzubinden. Darüber hinaus schaffen wir natürlich so viele attraktive Per spektiven zur persönlichen und finanziellen Weiterentwicklung wie möglich und besprechen diese in jährlich stattfindenden Zukunftsgesprächen.
Als Anbieter eines ganzheitlichen, betrieblichen Gesundheits managements bieten wir diesen Service als umfassendes, pro fessionelles Angebot natürlich auch intern den eigenen Mitar beitern an. Zu guter Letzt bedeutet Mitarbeiterbindung für uns aber auch: Erfolge muss man gemeinsam kräftig feiern dürfen – das scheint uns gut zu gelingen. Jedenfalls betiteln die Mit arbeiterinnen und Mitarbeiter unsere Sommerfeste und Weih nachtsfeiern gerne als legendär.“


„Grundsätzlich bieten wir als Grundvoraussetzung für ein lang fristiges Engagement einen der modernsten und schönsten Ar beitsplätze Deutschlands an. Wir sind der sehr erfolgreiche, re gionale Marktführer und dadurch in der Lage, immer wieder neu zu investieren und somit immer innovativ und up to date auch für unsere Mitarbeiter zu sein. Als weitere Maßnahmen zur Mitar beiterbindung bieten wir flexible, individuelle Arbeitszeitmodelle, die Möglichkeit zur Weiterentwicklung und Optimierung beste hender Konzepte, aktive Gestaltungsmöglichkeiten bzgl. der Ein führung neuer Konzepte und zusätzliche Verdienstmöglichkeiten über verschiedenste Provisionskonzepte. Zudem können unsere Mitarbeiter gratis im anima trainieren und erhalten 25 % Rabatt auf alle Angebote des Clubs. Sämtliche Kosten von Weiterbil dungsmaßnahmen werden übernommen und es finden jährlich 2–3 Mitarbeiter-Incentives statt. Durch ein positives und profes sionelles Arbeits- und Betriebsklima, offene und direkte Kommu nikation mit allen Mitarbeitern und Jahresabschlussgesprächen mit Zielvereinbarungen leisten wir einen weiteren Beitrag zur Mitarbeiterbindung.“
„Vermutlich kann man als Unternehmer sehr viel versuchen, und dennoch gelingt es einem nicht immer, die Mitarbeiter nachhaltig zufrieden zu stellen. Bislang konnten wir eine recht geringe Mitarbeiterfluktuation verzeichnen und erfreulicherweise freie Stellen auch stets sehr gut besetzen. Ich bin für alle Mitarbeiter stets erreichbar. Ich lebe unsere Philosophie vor und verlange nie etwas, was ich nicht auch selbst mache. Mein tagtägliches Ziel ist es, Unternehmer, aber auch Mensch zu sein. Ich denke, dass es genau in die sen Zeiten darauf ankommt, zusammen zu halten.
Da nette Worte der Wertschätzung nicht ausreichen, haben wir daher den Weg eingeschlagen, unsere Personalstruktur zu optimieren. Wir haben keine großen Teams mehr, viele Prozesse digitalisiert und vergüten unsere Mitarbeiter überdurchschnittlich. Zudem haben Studioleiter bzw. stellv. Studioleiter und der Leiter unseres Therapiezentrums Geschäftsfahrzeu ge. Darüber hinaus erhalten unsere Mitarbeiter Zuschüsse zur betrieblichen Altersvorsorge, Kraftstoffgutscheine und derzeit planen wir, für unsere festangestellten Mitarbeitern eine betriebliche Krankenversicherung abzu schließen, mit der sie dann z. B. bei einem stationären Krankenhausauf enthalt wie Privatversicherte behandelt werden. Zusätzlich beinhaltet diese Versicherung weitere Vorteile in den Bereichen Zahnzusatz, professionelle Zahnreinigung und Sehhilfen. Außerdem versuchen wir eine gute Balance bei den Schichtmodellen zu finden, sodass man auch seine freien Abende und Wochenenden hat.“













„Die neue Generation Arbeitnehmer hat sich zu den vorherigen deutlich weiterent wickelt: Gehalt, Benefits und Co. sind zwar weiterhin relevant, aber nicht mehr aus schlaggebend für die Stellensuche. Stattdessen rückt die Sinnhaftigkeit einer Tätig keit in den Fokus. Um diese Generation zu gewinnen, muss man deren Wünsche und Bedürfnisse an eine berufliche Aufgabe wahrnehmen und erfüllen. Wer Mitarbeiter lediglich als wirtschaftlichen Faktor sieht, wird auf dem heutigen Rekrutierungsmarkt Schwierigkeiten bekommen. Aus diesem Grund liegt unser Fokus auf dem Sinn un serer Arbeit: In der Fitnessbranche kümmern wir uns um die physische und psychi sche Gesundheit unserer Kunden. Als Geschäftsführerin ist es meine Aufgabe, diese Sinnhaftigkeit als Vision und Unternehmensphilosophie an mein Team weiterzuge ben. Wir wollen die Welt gesünder machen. Das vereint uns als Team, motiviert uns und ist die Basis der erfolgreichen Mitarbeiterbindung an unser Unternehmen.“

„Wir legen bereits seit vielen Jahren Wert auf eine professionelle Personalentwicklung. Zufriedene und zugleich engagierte Mitarbeiter entstehen in erster Linie durch eine gute Arbeitsatmosphäre, die durch Vertrauen, Menschlichkeit und Wertschätzung geprägt ist. Bei unseren Auszubildenden und Studenten setzen wir auf einen gut organisierten Know-how-Transfer, welchen wir in unserer Top Sports Academy bündeln. Es gibt klar kommunizierte Perspektiven mit Weiterentwicklungs- und Karrieremöglichkeiten. Unsere Führungskräfte erhalten frühzeitig und proaktiv Transparenz in unserer wirtschaftlichen Entwicklung sowie strategischen Überlegungen. Wir teilen den Erfolg gerne in Form von hochwertigen Incentive-Reisen oder Events, aber natürlich auch mit monetären Bonifika tionen für besondere Leistungen. Das Fach- und Spezialwissen unserer Mitarbeiter kann in unsere Prozesse einfließen. Hierfür finden wöchentliche Führungskräfte-Meetings statt. In regelmäßigen Personalgesprächen (2- bis 4-mal pro Jahr) zeigen wir ehrliches Interesse an der Situation des Mitarbeiters und fragen aktiv nach konstruktiver Kritik. Wir sehen unsere Mitarbeiter als Familienmitglieder. Dies leben wir aktiv und unterstützen auch im privaten Bereich bei möglichen Problemen stets pragmatisch und vor allem sehr schnell. Aktuell un terstützen wir unsere Mitarbeiter bei den Energiekosten. 50 % der Aufnahmegebühr kommen in einen Topf. Das Geld wird auf alle Festangestellten gleichermaßen aufgeteilt.


„Es ist uns bewusst, dass wir mehr in Sachen Mitarbeiterbindung tun müssen, um weiter er folgreich am Markt operieren zu können. Neben einer guten Bezahlung etablieren wir immer mehr erfolgsabhängige Vergütungsmodelle. So können z. B. Azubis und Studierende ihr Ge halt verdoppeln, sofern sie alle Ausbildungen abgeschlossen haben, die für den Einsatz als Trainer oder Kurskraft notwendig sind. Darüber hinaus binden wir unsere Mitarbeiter aktiv bei Entscheidungen zur Entwicklung des Unternehmens ein und entwickelten gemeinsam mit ihnen unsere WOF-Unternehmensvision für 2030 mit dem Ziel, in den Köpfen der Arbeitneh mer eine Entwicklung zum echten Mitarbeitenden anzustoßen. Aktiv fördern wir eine eingeschworene WOF-Gemeinschaft, die füreinander und miteinander steht. Diese WOF-Familie unterstützt auch in außerberuflichen Notlagen, so z. B. Mitarbei ter, die von der Flutkatastrophe getroffen wurden. Zudem praktiziert die Geschäftsführung die Politik der offenen Tür. Jeder Mitarbeiter kann, wenn er mit seinem Anliegen bei seinem Vorgesetzten kein Gehör findet, auch die Geschäftsführung an sprechen und sein Anliegen vortragen. Employer Branding wird 2023 eine wichtige unternehmensstrategische Maßnahme sein, um unseren Erfolg auch in der Zukunft sicherzustellen.“


„Vor allem in den letzten drei Jahren haben wir gelernt, wie wichtig es ist, dass eine Füh rungsperson das Team zusammenhält. Dabei geht es um fordern und fördern der Mitar beiter, um delegieren und loslassen, damit auch Raum für Freiheiten bleibt. Wir arbeiten als Team zusammen. Dabei ist es uns wichtig, dass alle Mitarbeiter das Thema Fitness leben und verinnerlichen. Meine Führungscrew und ich, wir besuchen regelmäßig die Clubs und fordern dabei die Clubteams stets zu einem Fitnessbattle auf. Das schweißt zusammen und macht gleichzeitig deutlich, wofür wir jeden Tag arbeiten. Wenn die Mitarbeiter Spaß bei der Arbeit haben, lieben, was sie tun, und ihren Fähigkeiten und Vorlieben entsprechend eingesetzt werden, können wir viel mehr bewegen und auch eine Krise besser meistern.“
„Jede Unternehmensstrategie und Vision ist nur so stark, wie das (Führungs-)Team, welches diese im Alltag lebt. Ich bin der festen Überzeugung, dass eine wertschätzende und fördernde Führung der Teams deutlich mehr Einfluss auf die Mitarbeiterbindung hat als z. B. monetäre Anreize. Gerade bei der Vielzahl an strukturierten und zentralisierten Prozessen, mit denen Fitnessketten arbeiten, wächst die Bedeutung der Führungsteams im operativen stark an.“
Mit dem neuen Virtual Training Cycle können alle Mitglieder jetzt echtes Indoor Cycling auf der Cardiofläche erleben – wann und wie sie wollen!

Dabei bleiben sie mit exklusiven Programmen wie Sprint 8 Intervalltraining, Virtual Active und Target Training hoch motiviert und können sich
bei interaktiven On-Demand Cycling Kursen zu sätzlich herausfordern.
Wer sich beim Workout lieber unterhalten lässt, streamt seine persönlichen Lieblingssongs, Filme oder Serien. Alles auf einem Cycle, das speziell für intensivste Trainingseinheiten entwickelt wurde.
Die Fitness- und Gesundheitsbranche hat bewiesen, dass sie langlebig, anpassungsfähig und innovativ ist. Und angesichts der gegenwärtigen und künftigen Herausforderungen, die sich aus der globalen Wirtschaftskrise ergeben, wird sie diese bewundernswerten Ei genschaften auch im Jahr 2023 unter Beweis stellen müssen.

Glücklicherweise glaube ich, dass unsere digital transformierte Branche gut aufgestellt ist, um diese Hürden zu überwinden und zu wachsen. Mit einem Kundenpool, der das Poten zial hat, tiefer und vielfältiger zu sein als je zuvor. Durch immer mehr Pro dukte und Innovationen, die auf den Markt kommen, haben Fitnessclubbetreiber die Möglichkeit, kosten- und zeiteffiziente Lösungen zu nutzen, um ihr Geschäft zu verwalten und ihre Kunden sowohl außerhalb als auch innerhalb der vier Wände ihrer Ein richtungen zu motivieren. Vor diesem Hintergrund gehe ich in diesem Artikel auf die drei größten Trends ein, die ich im Jahr 2023 im Bereich Gesundheit und Fitness erwarte.
Die Erkenntnis, dass Fitnesskonsu menten in zunehmendem Maße nach einem 24/7-Angebot suchen, das auf ihre individuellen Bedürfnisse zuge schnitten ist, hat unserer Branche die Augen für die verschiedenen Möglich keiten geöffnet, sie anzusprechen, zu motivieren und zu binden. Konzepte, die früher nur als Ideen galten, sind schnell von der Peripherie ins Zentrum des Fitnesserlebnisses gerückt. Ein klares Beispiel ist die Gamification. Die Hauptmotivation für sportliche Betäti gung ändert sich. Es ist nicht mehr nur ein Mittel zum Zweck, sondern auch eine Möglichkeit, Spaß zu haben. Fit ness wird zum gemeinsamen Erlebnis mit anderen, bei dem der körperliche Gewinn nur einer der vielen Vorteile ist. Wie wäre es denn, wenn die meisten
Menschen nicht aus einem Bedürfnis heraus Sport treiben würden, sondern weil es ihnen Spaß macht?

Für das Jahr 2023 prognostiziere ich eine weitere Zunahme von gamifizier ten Fitnesserlebnissen. Mithilfe mobiler Technologien und integrierbarer trag barer Geräte können starke Gruppenerlebnisse geschaffen werden, bei denen Fitnessstudios und Trainer ihre Kunden zusammenbringen, um sich gegenseitig zu motivieren, egal wo sie sind. Sie können ihre Leistung in Echt zeit verfolgen und in einem unterhalt samen Umfeld gemeinsam antreten, um persönliche oder gemeinsame Fit nessziele zu erreichen. Dies fördert die Gemeinschaft und die Markentreue.
Dieser Anstieg wird durch die zuneh mende Entwicklung und Zugänglich keit modernster Gamification-Technologien wie Virtual Reality (VR) und Aug mented Reality (AR) begünstigt, die meiner Meinung nach einen besonders starken Einfluss auf die Zukunft der

Fitness haben werden. Eine aktuelle Studie des globalen Marktforschungs unternehmens Technavio hat erge ben, dass der AR-/VR-Markt bis 2025 voraussichtlich um 162,7 Milliarden Dollar wachsen wird, was haupt sächlich auf die Nachfrage zurückzu führen ist. Anfang dieses Jahres hat Basic-Fit beispielsweise ein neues ARProdukt mit Snapchat auf den Markt



Der Wert von sicher gesammelten Daten für Fitnessclubs ist inzwischen allgemein bekannt. Ebenso wie das Bewusstsein für die Bedeutung von Fitness-Apps für Fitnessstudios und die Tatsache, dass der Trend zur Leistungsmessung weiterhin ungebro chen ist. Ein Fitness-App-Report von






gebracht, um kurze Workouts mit einer Linse zu spielen, die Körperbewegun gen und Wiederholungen bestimmter Übungen verfolgt. Der Einsatz dieser Technologie mag sich derzeit noch in einer eher experimentellen Phase be finden, aber ich gehe davon aus, dass sie sich zu einer ernst zu nehmenden Kraft und einem Kernbestandteil des integrierten modernen Fitnesserleb nisses entwickeln wird.
2022 stellte unter anderem fest, dass das Gesundheitsbewusstsein und die zunehmende Digitalisierung den glo balen Fitness-App-Markt bis ins Jahr 2028 jährlich um 21 % wachsen las sen werden, während eine deutsche Umfrage zur Unterhaltungselektronik von 2022 ergab, dass der Absatz von Wearables im Jahr 2021 um 9 % stieg und sich seit 2017 fast verdoppelt hat.
Die Synergie zwischen physischen und digitalen Dienstleistungen wird zunehmen
Infos!
Das Wachstum in diesen Bereichen in Verbindung mit den Fortschritten bei automatisierten Clubmanagement lösungen – von Zugangskontrollen bis hin zu KI-gesteuerten Trainings geräten – bietet mehr verwertbare Daten als je zuvor, die als Grundlage für Geschäftsentscheidungen dienen können. Dies wiederum macht es für Fitnessstudios und Trainer noch wich tiger, dass sie wissen, wie sie diese Daten am sichersten sammeln und nutzen können. In der Lage zu sein, effektiv personalisierte Erfahrungen zu bieten, um individuelle und Gruppenbedürfnisse zu unterstützen, könnte den Unterschied zwischen Kunden, die bleiben oder gehen, auf dem extrem wettbewerbsorientierten Fitnessmarkt ausmachen.
Ich gehe davon aus, dass im Jahr 2023 die uns zur Verfügung stehende datengesteuerte Technologie und die Art und Weise, wie wir sie nutzen, weiter verbessert und zugänglicher werden. Das bedeutet, dass Kunden dabei geholfen werden kann, ihre Ziele schneller und nachhaltiger zu errei chen und gesunde Gewohnheiten zu entwickeln. Zum Beispiel durch die Verfolgung, Messung und Zusam menführung von Daten zur Erstellung von Trainingsplänen und -inhalten. Ich gehe davon aus, dass wir hier weitere Innovationen sehen werden. Der Wert dieses Strebens nach Daten erstreckt sich auch auf die Unterstützung von Marketingkampagnen und Wettbe
werben, die Kommunikation mit der Gemeinschaft und die Generierung weiterer Einnahmequellen, z. B. durch flexible Mitgliedschaftsoptionen, Web shops und Up-Selling von Angeboten. Motivationen, Verhalten und Vorlieben zu verstehen war für Fitnessanbieter noch nie so wichtig wie heute. Mit den richtigen technologischen Lösungen kann diese Aufgabe erheblich erleich tert werden – und der Nutzen ist noch größer.

Trend 3: Die Synergie zwischen physisch und digital nimmt zu Früher gab es Bedenken hinsichtlich der Auswirkungen, die die Technologie auf die Fitnessbranche haben könnte. Die jüngsten Erkenntnisse zeigen aber, dass diese Sorgen unbegründet sind. Tatsächlich glaube ich, dass die Technologie dazu beigetragen hat, das Fitnesserlebnis zu verbessern und nicht zu verschlechtern, und dass sich dieser positive Trend im Jahr 2023 noch verstärken wird, da immer mehr Clubs auf hybride Online- und Offlinegeschäftsmodelle setzen.
Ein Fitnessstudio wird für einen großen Teil unserer Fitness-Community immer im Mittelpunkt des Fitnessangebots stehen und ich bin zuversichtlich, dass die Bedeutung von körperlichem Trai ning und sozialer Interaktion bestehen bleiben wird. Der Unterschied? Die Kunden werden deutlich mehr Ange bote haben, wie sie sich körperlich und geistig fit und gesund halten und
Die Kunden werden zukünftig deutlich mehr Angebote haben, wie sie sich körperlich und geistig fit und gesund halten, z. B. durch ein ausgewogenes Verhältnis zwischen Video-Workouts zu Hause und persönlichen Trai ningseinheiten im Studio
mit Gleichgesinnten in Kontakt treten wollen, z. B. durch ein ausgewogenes Verhältnis zwischen Video-Workouts zu Hause und persönlichen Trainingseinheiten im Studio. Eine Studie von Deloitte aus dem Jahr 2022 über den deutschen Fitnessmarkt hat ergeben, dass 20 % der Menschen inzwischen hybride Trainingsroutinen verfolgen, bei denen sie zu Hause und im Fitnessstudio trainieren.

Wir erleben, wie Technologie ein inte graler Bestandteil des Clubangebots sein kann, der das Workout ergänzt und die Art und Weise, wie es verwal tet wird, verbessert, anstatt nur ein „nice to have“ zu sein. Im nächsten Jahr wird sich die Beziehung zwischen Online- und Offlinefitness weiterent wickeln und wachsen, wobei Studios im Zentrum dieser Synergie zwischen physischen und digitalen Dienstleis tungen stehen werden.
Hugo Braam ist Mitbegründer und CEO von Virtuagym. Das Unternehmen bietet u. a. hybride All-in-one-Trainingssoftware für Fitness- und Gesund heitsstudios an.

Internetaktivitäten sind inzwischen fest in den Alltag integriert. Die Nutzung wird für Men schen, die nicht mit dem Internet aufgewachsen sind, den sogenannten „Digital Immigrants“, immer selbstverständlicher. Insbesondere ist die Generation X, also die Geburtenjahrgänge zwischen 1965 und 1980, für digitale Anwendungen sensibilisiert. Der Einsatz von digitalen Tools wird daher in den nächsten Jahren noch stärker in den Fokus der Fitnessanbieter rücken. Betrachtet man daneben das bestehende Körper- und Gesundheitsbewusstsein in der Bevölkerung, so birgt die allgemein voranschreitende Digitalisierung ein erhebliches Marktpotenzial im Kontext Fitness in sich.
Im Zusammenhang mit Fitnesstrends und Digitalisierung ist der Bereich Virtual bzw. Augmented Reality zu finden. Dieser existiert bereits seit mehr als 40 Jahren. War es zu der Zeit eher ein laborbasiertes Konstrukt, gilt die Tech nologie seit etwa 20 Jahren als prakti sches, nützliches und erschwingliches System. Unter Virtual Reality, oder auch abgekürzt VR, versteht man eine alternative Wirklichkeit mit echten phy

sikalischen Eigenschaften, die vom je weiligen Nutzer in Echtzeit erlebt wird.
Im allgemeinen Sprachgebrauch wird zwischen „Virtual“ und Augmented Reality“ unterschieden. Während bei „echter“ Virtual Reality eine vollends künstliche Welt vor den Augen des Betrachters erschaffen wird, werden bei Augmented Reality nur künstliche Fragmente in die wirkliche Welt pro
jiziert. Dies geschieht meist mittels computergenerierter Einblendungen oder Überlagerungen auf Bildschir men. Die Hardware für dieses Erlebnis besteht, vereinfacht erklärt, aus zwei Komponenten. Zum einen aus einem hochauflösenden Bildschirm und zum anderen aus dem innen liegen den Trackingsystem. Dieser Bild schirm wird meistens als sogenanntes „Head-Mounted Display“ verbaut, was
bedeutet, dass sich das Display mithilfe einer Halterung direkt vor den Augen befindet. Um den Eindruck einer drei dimensionalen Welt zu vermitteln, be dient man sich der Technik der Stereoprojektion. Das bedeutet, dass für je des Auge ein minimal unterschiedliches Bild dargestellt wird, welche vom Gehirn für die Tiefenwahrnehmung kombiniert werden. Der verbaute Bewegungssensor ist dafür zuständig, die Bewe gungen des Kopfes in die Software zu übertragen, damit der Nutzer stets ein dynamisches Bild geliefert bekommt.

Im Bereich Fitness gibt es bereits An sätze, VR-Brillen in das Training zu involvieren. Als Praxisbeispiel ist vor diesem Hintergrund das Trainings gerät „Icaros“ zu nennen. Es handelt sich dabei um eine Art Metallschlitten, der mittels Muskelkraft gesteuert wird, während man mit einer VR-Brille eine Flugsimulation erlebt. Der Einsatz die ser Technologie ist derzeit vorrangig noch auf den Leistungssport fokus siert. Anwendungen aus dem Bereich der Virtual Reality haben laut Experten großes Potenzial für den Breiten- und Freizeitsport, werden aber in der Pra xis bislang nahezu ausschließlich zu Forschungs- und Technikzwecken verwendet. Im Vergleich zu VRAnwendungen hat die Konnektivität bzw. Koppelung von bestehenden digitalen Tools z. B. mit dem Smart phone oder auch Trainingsgeräten im Fitnessstudio hohe Relevanz. Da durch bieten sich für die Studiomit glieder eine Vielzahl an Möglichkeiten. Dementsprechend umfassend sind bereits digitale Bewegungs- und Ge rätekonzepte, wie auch webbasierte Trainingsprogramme, spezielle Onlineplattformen oder digitale Medien, die von Fitnessanlagen schon berücksich tigt und in ihrem Angebot integriert werden.
Daten sind die neue Währung Durch die stetige Weiterentwicklung von Trackingtechnologien in Form von tragbaren digitalen Messgeräten bzw. Wearables, wird zukünftig eine zuneh mende sowie weitreichendere Gene rierung von personalisierten Daten zu erwarten sein. Dadurch könnten eins tige, ausschließlich im Kontext Fitness gesammelte Informationen, auch an derweitig verwertbar werden. Die Nut
Es gibt bereits verschiedene Ansätze, wie sich VR-Brillen in das Training involvieren lassen
zung dieser sensiblen Personen- und Vitaldaten, welche aus datenschutz rechtlichen Gründen Konsequenzen bzw. Probleme mit sich ziehen würde, könnte demzufolge zu ökonomischen Zwecken ausgewertet werden. Für bestimmte Unternehmen stellen Vitalwerte oder auch Bewegungsprofile ein großes wirtschaftliches Interesse dar, da insbesondere Fitness- und Gesundheitsdaten ein handelbares Wirtschaftsgut geworden sind. Dieses Phänomen lässt daher eine Schnitt stelle zu beispielsweise Ärzten, Phar maunternehmen, Krankenversicherungen oder auch Arbeitgebern und Sportartikelherstellern vermuten. Als eines der ersten Beispiele aus der Unterneh menswelt kann hierbei die Übernahme der Fitnessapp „Runtastic“ im Jahr 2015 durch den Sportartikelhersteller „Adidas“ aufgeführt werden.
Die Nutzung digitaler Fitnesstools ist inzwischen alltäglich geworden. Inwie weit die Einhaltung von geltenden da tenschutzrechtlichen Bestimmungen im hier beschriebenen Szenario in Zukunft gewährleistet werden kann, bleibt abzuwarten. Jedoch erscheint die Tatsache, dass der Umgang mit dem sensiblen Datenmaterial, welches im Zuge von digitalen Anwendungen generiert und auch ausgewertet wird, Anlass zu kontrovers geführten Dis kussionen gibt und voraussichtlich auch weiterhin geben wird. Ob und inwieweit der digitale Wandel und die
damit einhergehenden Veränderungen für die gegenwärtige als auch zukünf tige Studiomitgliedschaft aus Sicht der Kunden mitgetragen, gewünscht oder sogar gefordert werden, kann zum jetzigen Zeitpunkt aus wissen schaftlicher Sicht kaum prognostiziert werden.
HOJA, E. (2014). Die digitale Revolution der Fitnessund Gesundheitsbranche – Eine kritische Betrach tung. Grin Verlag
SANCHEZ-VIVES, M.V., SLATER, M. (2005). From Presence to Consciousness through Virtual Reality, Nature Reviews Neuroscience 6
SCHWARZENBERGER, D. (2021). Fitnessstudios im Trend der Digitalisierung – Eine Untersuchung relevanter Aspekte zur Kundenzufriedenheit im Kontext der Kundenbindung. Hofmann-Verlag
Bereits seit 2003 setzt sich Dr. Daniel Schwarzenberger sowohl in der Theorie als auch in der Praxis mit dem facettenreichen Bedeutungsfeld der Fitnessstudios auseinander. So konnte er beruflich neben einer langjährigen Leitungsposition auch zahlreiche Er fahrungen als Dozent und Berater im Sport- und Gesundheitsmanagement sammeln.


Nach mehreren Jahren mit rückgängigen Mitgliederzahlen für viele Clubs gilt es in diesem Herbst und Winter, den Vertrieb wieder auf Hochtouren zu bringen. Der große ACISO Bran chencheck im August/September dieses Jahres brachte vielfach erschreckende Resultate. Kontaktanfragen per E-Mail oder Social Media werden überhaupt nicht oder erst sehr spät bearbeitet, Telefonkontakte enden ohne konkreten Terminvorschlag oder die Aufnahme von Kontaktdaten, im Verkauf wird nur dürftig beraten … die Liste ließe sich lang fortsetzen.
Mit der Unterstützung von Björn Schneidereit (Head of SALES FORCE 2.0) haben wir unseren Vertrieb professionalisiert und allein in den ersten Tagen über 150 Kontakte generiert und 12 Neukunden gewonnen. Elfi Merx, INJOY Neuöttingen
Mit Sales Coaching zum Ziel Um die großen Potenziale des Marktes effektiv zu nutzen, müssen sofort alle Vertriebsprozesse optimiert werden. Erfahrene Sales-Coaches und Marke tingspezialisten helfen dir, wieder ins Wachstum zu kommen. Mit erprobten Kampagnen und Vertriebsmaßnah men erhöhst du spürbar und schnell deine Interessentenzahlen. Dabei kommen sowohl Online- wie Offline maßnahmen zum Einsatz, gleichzeitig schiebt dein Team die interne Weiter empfehlung an oder sorgt bei Promo tion für qualifizierte Leads.
Damit aus den Interessenten auch Kunden werden, unterstützen die Coa ches dein Verkaufsteam dauerhaft. Sie analysieren die Prozesse und sorgen für maximale Effizienz. Sie schulen und coachen dein Team in der Praxis und
sorgen so für die nötige Abschlusssicherheit. Und sie bleiben dran, bis das Ziel erreicht ist.
1 Stunde, die sich garantiert lohnt! Wenn du mehr wissen willst, schau dir unbedingt im ersten Schritt unser SalesWebinar an. Auf der Seite aciso.com/ sales findest du alle Informationen. Nimm jetzt mit uns Kontakt auf, um dir deinen Vertriebserfolg zu sichern!


ACISO CONSULTING GmbH

Valentin-Linhof-Str. 8 81829 München
Tel. +49 (0) 89 / 45098130 E-Mail: info@aciso.com Web: www.aciso.com/sales
Mit der neuen Version 6 von CenterCom setzten Sie es um!

Mit dem Sales Manager können Interessenten 24/7 online ganz einfach einen Vertrag abschließen.
Der Reservation Manager sorgt rund um die Uhr für die ideale Auslastung Ihrer Trainer und Kurse.

Mit der Member App hat das Mitglied ständig Verbindung zu Ihrem Club.
Das ist echter Service, spart Personalkosten und steigert den Ertrag! Mehr Infos auf www.mac-centercom.de
Was gibt’s eigentlich Neues in der Fitnessbranche? Dieser Frage sind wir nachgegangen und stellen Ihnen nachfolgend einige Start-ups und spannende Innovationen vor.


Alpha Cooling Professional (ACP) ist die erste professionelle GanzkörperKältebehandlung, die nur über das sanfte Herabkühlen der Handflächen funktio niert. Kein Entkleiden, kein Frieren. Die Wirkung setzt dennoch von Kopf bis Fuß ein. Das Produkt wird von der ALPHA Industries AG in Leutkirch im Allgäu her gestellt, wo auch die Forschung und Entwicklung stattfinden. Die Anwendungen sind denkbar einfach und niederschwellig, was insbesondere für die ältere Generation attraktiv ist – genügt es doch, einfach die Hände in die dafür vorgesehenen Unterdruck-Kältekammern zu legen, ohne sich bis auf die Unterwäsche entkleiden zu müssen, wie man es bisher von konventioneller Cryo-Therapie kennt. Ein ACPBehandlungszyklus dauert gerade einmal zwei Minuten und ist mit +4 Grad scho nend und sanft zur Haut, was die Anwendung überraschend angenehm macht. Fitness- und Gesundheitsstudios können damit Kältebehandlung auf kleinstem Raum anbieten, wie es vorher nur mit Kältekammern und Eisbädern möglich war. Fitnessstudios können zudem das wartungsfreie Gerät zur Generierung von Neukundenanfragen und einer völlig neuen Ziel gruppe einsetzen, die Fitnessclubs sonst kaum aufsuchen. Alpha Cooling Professional ist anzuwenden bei starken und chro nischen Beschwerden wie z. B. Rheuma, Arthritis, Nervenschmerzen, Zerrungen, Karpaltunnelsyndrom, Gelenkschmerzen, Migräne, Muskelschmerzen und -Entzündungen, Fibromyalgie, Sportverletzungen u. v. m.
Weitere Informationen unter: www.alphacooling.de
Seit vier Monaten ist die erste achtteilige Outdoor-Basisserie von GS MEGAfit Kraftmanufaktur am Markt. Der Individualität der High-End-Kraftmaschinen aus Edelstahl ist dank der Fertigung in der Manufaktur keine Grenze gesetzt. Die achtteilige Basisserie kann mit individuellen Kundenwünschen erweitert und ergänzt werden. Egal ob Sonderausführungen im Lederbezug, Gravur, eigenes Logo, Zusatzausstattungen für etwaige Geräte wie Tablet, Handy oder Trinkflasche.
Dabei wird nichts dem Zufall überlassen: Mit Ingenieuren, Technikern, Sportwis senschaftlern und Fitnesstrainern werden die spezifischen Wünsche der Kunden professionell verarbeitet, um das perfekte Trainingserlebnis zu ermöglichen. Die Serie umfasst die folgenden Geräte: Trizeps-Dips, Schulterpresse, Rudermaschine, Latzug, Kabelturm Dual, Brustpresse, Bizepsmaschine und Brustpresse.





Die puristischen Kraftgeräte aus rostfreiem Edelstahl werden zu 100 % in Deutschland produziert und sind extrem wetterfest und wartungsarm. GS MEGAfit bietet einen 360-Grad-Service, der Beratung, Verkauf, Gestaltung durch den Architekten, Installation und Service umfasst.

Jan Schlott, Vertriebsleiter der GS MEGAfit Kraftmanufaktur, freut sich auf Ihre Kontaktaufnahme.
Weitere Informationen unter: www.gs-megafit.com
Die armbar ist ein neues, in Deutschland entwickeltes, patentiertes und pro duziertes Freihantel-System. Mit dem innovativen Widerstand aus Pendel- und Gewichtskraft kann armbar neue Reize wecken. Jeder einzelne Muskel kann spürbar besser beansprucht und damit der Trainingserfolg gesteigert werden. Zudem bietet die armbar während des Trainings 100 % Bewegungsfreiheit. Dadurch wird die Koordination gestärkt und die Stabilität verbessert werden. Dementsprechend lassen sich mit armbar nicht nur Übungen, sondern auch Be wegungsmuster abbilden. Während des Trainings wird eine Fläche von 7–12 m2 benötigt. Diese kann über eine Schiene auf knapp 6 m2 verringert werden. In der Parkposition beansprucht armbar lediglich 1 m2


Die armbar ist einfach wie komplex. Deshalb ist sie perfekt einsetzbar im Fitness studio, zu Beginn für ein oder mehrere einfache Übungen. Diese Übungen ma chen für den Trainierenden einen großen Unterschied, weil es eine andere und in tensivere Belastung ist im Vergleich zu anderen Übungen und Geräten. Vor allem folgende Übungen versprechen einen ganz neuen Trainingserfolg mit der armbar! Der BizepsCurl bekommt durch den Zug der Pendelkraft so richtig Feuer, und das über die gesamte ROM. Beim vorgebeugten Rudern erzeugt die Gewichtsund Pendellast eine Mischung aus Latzug- und Ruderbewegung. Das Bankdrü cken und der Floor Press vereint die armbar zu einer Symbiose aus engem und fliegendem Bankdrücken.
Weitere Informationen unter: www.atlasign.com
Betrachtet man das Geräteportfolio von Mindzmove, wird klar: Hier geht es um die Themen Beweglichkeitstraining, Flexibility, Muskellängentraining und Faszientraining. Trainingsformen, die sich längst etabliert haben und in keiner Trainingseinrichtung mehr fehlen dürfen. Mit den Übungen im Mindzmove-Parcours werden auf schonende Art und Weise und unter konsequenter Berücksichtigung der funktionellen Muskelketten die natürlichen Spannungsverhältnisse der myofaszialen Strukturen wieder hergestellt und leisten sowohl bei akuten Schmerzen als auch präventiv einen wichtigen Beitrag zur Gesundheit des Körpers.
Bei Mindzmove geht es nicht nur um körperliches Training, sondern auch um die Entwicklung von Bewusstsein für den eigenen Körper, die Emotionen und den Geist. Dafür kann der Gerätepark mit einer eigens für diese Trainingsform entwickelten Software erweitert werden. Erstmals kommen dabei auch mentale und emotionale Aspekte zur Trainings steuerung zur Anwendung. Anwender können die Geräte als reines Bewegungskonzept nutzen, aber auch als ganz heitliche Anwendung und um eine mentale Ebene ergänzen. Deshalb werden Parcourslösungen für beide Anwendungs bereiche – mit und ohne Software-Unterstützung – und ei nem vollständigen Betreiberkonzept angeboten. Letztend lich ist das Mindzmove-Training wie Yoga am Gerät. Das bedeutet, man kommt ohne Leistungsdruck in sanfte Bewe gung, die genau darauf abgestimmt ist, was dem Übenden, seinem Körper und seiner Psyche gerade guttut.
Weitere Informationen unter: www.mindzmove.de
Bereits 2013 kam der Sportwissenschaftlerin Prof. Dr. Anna Lisa Martin-Niedecken die Idee, den [ExerCube] zu entwickeln. 2018 gründete sie mit drei Partnern die Sphery AG in Zürich und seither erweitert Sphery mit einem starken Team aus Bewegungs- und Kognitionswissenschaftlern sowie Personal Trainern und externen Forschungs- und Industriepartnern ständig die Grenzen im Bereich des digitalen Trainings und der Therapie. Der [ExerCube] ist eine barrierefreie, dreidimensionale Trainingsfläche, die es ermöglicht, digitale und analoge Trainingsansätze zu kombinieren. Die offene Form för dert die soziale Interaktion und regt zu neuen Formen der digitalen und analogen Zusammenarbeit zwischen Trainer bzw. Therapeuten und den


forschungsbasierte Entwicklung bildet dabei ein wichtiges Qualitätsmerkmal. So belegen u. a. Studien der Charité Berlin und der ETH Zürich die Verbesserung der kognitiven Funktionen sowie die positiven Effekte auf Herz-Kreislauf-Parameter und die Erzeugung idealer Trainingsintensitäten. Die moderne Trainingswelt verlangt neue Kompetenzen, neue Motivation und neue Erlebnisse.
Bei der Neukundengewinnung ist dabei wichtig, dass auch neue Zielgruppen angesprochen werden. Nur wer die Zukunft aktiv mitgestaltet, wird erfolgreich sein. Spannende Zusatznutzen für die moderne Trainingswelt in den Bereichen Prävention, Sport und Rehabilitation bieten die motorisch-kognitiven Trainingskonzepte von Sphery.
Weitere Informationen unter: www.sphery.ch
Wissenschaftlich basiertes Training zur effektiven Steigerung der kognitiven, mentalen und physischen Fähigkeiten. Individuelle Echtzeitanpassung für maximale Trainingserlebnisse.
www.sphery.ch - www.ergo-fit.de
Dennis Gries ist Gründer des Start-ups GymBubble. Die Idee zu GymBubble ist durch den Einsatz im eigenen Studioumbau entstanden. Der Jungunternehmer wollte dem neuen Studio noch ein optisches Highlight verpassen und einen Mehrwert für Mitglieder schaffen. Als der erste Prototyp des Automaten im Studio hing, war die Begeisterung groß, sodass dies der Startschuss für die Produktion war.
Der Automat im Vintage-Design ist nicht nur ein echter Hin gucker, sondern ermöglicht die optimale Unterstützung der Muskeln während des Trainings. GymBubble versorgt die Trainierenden mit hochwertigen Supplements. Einfach 1 Euro einwerfen und eine Bubble mit vier Kapseln und Motivationsspruch rollt in die Hände. Zur Auswahl stehen Creatin oder BCAAs. Beide Produkte sind zu 100 % Made in Germany und vegan. Aktuell gibt es GymBubble in über 60 Studios.


Weitere Informationen unter: www.gym-bubble.com
Sich selbst aus einer völlig neuen Perspektive sehen? Das ist in we nigen Sekunden mit SCANECA möglich. Das 3D-Körperanalysesystem erstellt mithilfe von Hunderten hochpräzisen 3-D-Aufnahmen der Körperoberfläche einen detailgetreuen virtuellen Zwilling in 360°Ansicht. Auf dieser Basis werden alle fitnessrelevanten Körperwerte und Umfangsmessungen ermittelt und analysiert. Immer exakt an den selben Stellen, sodass Reports valide und reproduzierbare Ergebnisse liefern, die kontinuierlich vergleichbar sind.
Eine integrierte Haltungsanalyse gibt Aufschluss über Haltungsfehler. Die deutliche Visualisierung des Körperzustandes verhilft zu einer hohen Motivation, die Inanspruchnahme zielführender Fitness- und Therapieangebote und einer umsatzsteigernden Kundenbindung.
SCANECA wurde 2018 gegründet. Bereits zahlreiche Einrichtungen nutzen die innovative Messmethode, die aufgrund der Forschungs aktivitäten von dem Stifterverband „Innovativ durch Forschung“ aus gezeichnet wurde. Das Berliner Unternehmen profitiert von stetigen Innovationen und ermöglicht sich so ein rein organisches Wachstum. Nachdem das neue Haltungsanalysetool viel Aufmerksamkeit gewon nen hat, arbeitet SCANECA bereits am nächsten Update mit neuen Technologien für noch mehr Messergebnisse an den Extremitäten.
Weitere Informationen unter: www.scaneca.de

Franchisesysteme gehören seit einigen Jahren fest zur Fitnessbranche und haben einen großen Anteil am schnellen Wachstum der Branche. Grund genug, um einen Blick auf den aktuellen Status im Bereich der Franchisesysteme im Rahmen einer Marktübersicht zu werfen.

Die Zahl der Franchisesysteme ist in den vergangenen Jahren in Deutsch land stark gewachsen. Mittlerweile gibt es Konzepte in nahezu jedem Segment und für alle Alters- und Zielgruppen. Sowohl Existenzgrün der als auch potenzielle Kunden ha ben die Qual der Wahl. Egal ob EMS, Functional Training, reine Frauenstu dios, Pilates, Trainingskonzept für Senioren, gesundheitsorientiertes Krafttraining, Premium-Fitness oder klassi sches Fitnessangebot – es gibt nichts, was der Fitness-Franchisemarkt nicht bietet.
Dabei sind die Vorteile für den Fran chisenehmer groß: Durch das Knowhow des Franchisegebers werden Gründungsfehler vermieden. Das ist sicher der wichtigste Erfolgsfaktor der Franchisesysteme. Dazu kommt die Zugehörigkeit zu einem Verbund, die Integration in ein funktionierendes
Marketing- und Vertriebssystem, Kos tenvorteile und eine stärkere Verhand lungsposition bei den Banken.
Für Gründer ist das aufzubringende Eigenkapital in vielen Fällen über schaubar und ausschlaggebend, um den Schritt in die Selbstständigkeit zu wagen. Unternehmer, die ein Fran chisestudio zusätzlich zu ihrer be stehenden Anlage eröffnen, können möglichen Wettbewerbern zuvorkom men und weitere, neue Zielgruppen ansprechen. Ein großes Argument pro Franchiseclub ist sowohl für Existenz gründer als auch erfahrene Fitnessunternehmer die Tatsache, dass die Kunden, je nach Konzept, bereit sind, über 100 Euro monatlich zu bezahlen. In Sachen Anlagengrößen sind die Unterschiede immens. Vom Boutique studio mit knapp 100 m2 bis hin zum Komplettanbieter mit ca. 3.000 m2 ist alles vertreten. Eine Gemeinsamkeit ist
bei den meisten Franchisesystemen zu erkennen. Sie setzen auf hoch effektives Training und kurze Workouts, um vor allem auch Kunden mit knappem Zeitbudget ansprechen zu können.
Die Ursprünge von Fitness-Franchi sesystemen in Deutschland liegen in den 1960er- und 1970er-Jahren. 1967 wurde mit Kieser Training der älteste und wohl auch einer der bekanntesten Anbieter gegründet. Durch die Ent wicklung der vergangenen Jahre und die gestiegene Zahl an Franchisesys temen ist der Markt noch umkämpfter geworden, als er ohnehin schon war. Fest steht, dass die Digitalisierung auch vor den Franchisesystemen nicht Halt machen wird. Dieser Heraus forderung müssen sich die Systeme stellen und ihre Produkte und Dienst leistungen mithilfe beständiger Innova tionen aufrüsten.
Dazu Carsten Pachnicke, Gründer von 25MINUTES: „Das Bewusstsein für Gesundheit ist stärker denn je und Ge sundheit braucht Fitness. Besonders Mikrostudios gelten als Wachstumstreiber der Fitnessbranche. Personal Training, Top-Service, Premium-Hygiene und Individualität sind mehr als jemals zuvor gefragt. Klasse statt Masse! Un ser Training ist einzigartig. Daher auch unser Claim: „A Training as unique as you are.“ Gestalten Sie jetzt die Zu kunft von morgen und treffen Sie die Vorbereitungen, um im Trendmarkt Gesundheit mit einem starken Partner an Ihrer Seite durchzustarten.“
Kaiser-Wilhelm Straße 93 20355 Hamburg +49 (0) 40 / 3571690 info@hamburg-city.25minutes.de www.25minutes.de
FitT für die Zukunft mit 25MINUTES
25MINUTES setzt einen ganz neuen Standard für ganzheitliches bioelektri sches Personal Training in der Fitness branche. Eine Symbiose aus Smart Health Training mit bioelektrischen Impulsen und Hightech Fitness mit Echtzeit-Tracking. Schnell. Effizient. Einzigartig.
25MINUTES bietet ein innovatives Franchisekonzept mit krisenerprobten Abläufen und hohen Qualitätsmaß stäben. Franchisepartner profitieren von einer Premiummarke, einem ein heitlichen Unternehmensauftritt sowie erfolgreichen Marketing- und Kundengewinnungskonzepten.

Die Konzept-Studios von 100% Fitness bieten für verschiedenen Ausgangssi tuationen angepasste Lösungen. An lagen von 200 bis 2.000 m2 können gewinnbringend mit diesem Konzept betrieben werden. Aktuell sind Analgen im ländlichen Bereich mit bis zu 400 m2 im Fokus der Betreiber. Dabei können die Anlagen ohne Personal, oder mit deutlich weniger Trainerstunden als üb lich geführt werden. Dadurch wird ein enormes Einsparpotential ermöglicht.

Die Lizenznehmer von 100% Fitness werden dabei von Beginn an begleitet und profitieren auch nach der Studioeröffnung weiterhin von der Unterstüt zung der Konzeptgeber. Die wirtschaft liche Einschätzung des Standortes, die Hilfe bei Vertragsverhandlungen, die Beratung bei der richtigen Studio ausstattung, sowie alle Schritte bis zur Eröffnung der Anlage gehören zu dem Leistungsumfang des Konzeptes. Für den späteren Erfolg stehen neben ver
schiedenen Marketingvorlagen, einem professionellen Web-Auftritt und einer vollautomatischen Mitgliedergewinnung, die Betreiber den Konzeptpartnern wei ter zur Seite.
Neben der Eröffnung neuer Analgen bietet das Konzept von 100% Fitness auch die Umgestaltung einer beste henden Anlage in das Konzept an. Die sehr geringen Konzeptkosten zu sammen mit einer geringen Investition ermöglichen auch Branchenfremden Unternehmern einen Einstieg in die Fitnessbranche.
Alleinstellungsmerkmale
Body Shape Fitness ist ein Franchisesystem für Boutique-Fitnessstudios. Die Studios kombinieren EMS-Training, Zirkel- und Beweglichkeitstraining, be gleitet von Personal Trainern. Neueste Geräte und Erkenntnisse kennzeichnen Ausstattung und Trainingsmethoden bei Body Shape Fitness. 2019 als Franchise gestartet, sucht das Unter nehmen Partner in Deutschland.


Das Unternehmen Body Shape Fitness ist nicht einfach ein Franchisegeber, sondern ein Geschäftspartner mit Betonung auf „Partner“. Nur im Erfolg ihrer Franchisenehmer sehen die Body Shape-Gründer ihren eigenen Erfolg. Dafür bieten sie jede Unterstützung für die Existenzgründung – von der Standortsuche über das Onboarding bis hin zu allen Formalitäten zur Studioeröffnung.

Wer an EMS denkt, denkt automatisch an Bodystreet. Die 2007 gegründete Boutique-Fitness-Marke Bodystreet, ist längst zum Synonym für EMS-Studios geworden. Die Kombination aus einer starken Marke und lokaler Verantwor tung selbstständiger Franchiseunter nehmer erweist sich als Erfolgsformel –in über 300 Bodystreet-Studios auf drei Kontinenten. Mit beeindruckender Performance: Deutscher Fairness-Preis 2022, Global Franchise Award 2022, Leading Employer Deutschland 2022, Focus Money Deutschland Test „höchste Kundenzufriedenheit“ 2022,

Deutscher Fairness-Preis 2021, Green Franchise Award 2021, Global Franchise Award für bestes Fitness-Franchise 2020.
Das alles ist jedoch kein Grund sich darauf auszuruhen. „Ambient“ beschreibt die Bodystreet Innovationen digitaler Customer Touchpoints, sowie der neuesten EMS-Technologie. Was zählt ist die Customer Experience. Ob im Studio, draußen in der Natur oder zu Hause im Wohnzimmer, Bodystreet betreut Mitglieder dort, wo sie sich gerne aufhalten – und trainieren.
Bahnhofstraße 24 55218 Ingelheim am Rhein +49 (0) 6132 / 9748073 business@bodyshape-fitness.de www.bodyshape-fitness.de
An der Steinernen Brücke 1 85757 Karlsfeld bei München +49 (0) 89 / 210195633 franchise@bodystreet.de www.bodystreet.de
















Das Circelone – ein innovatives Boutique-Club-Konzept

Bei CIRCLEONE® dreht sich alles um die Zielerreichung und Motivation des Mitglieds. Zum Konzept gehören nicht nur gesundheitsorientiertes Kraft-, Ausdauer und Beweglichkeitstraining als Trainingsmethoden, sondern auch alle Prozesse drumherum – damit die Mitglieder nachhaltig im Programm bleiben und Ihre Ziele erreichen. Sämt liche Faktoren die sonst zu einem „Drop Out“ des Mitglieds führen könn ten, werden bei der Planung von je dem Club berücksichtigt und ausge schaltet. In einem durchgestylten Club auf 200 m2 Fläche werden so, neben der zeitsparenden Trainingsmethode an Geräten der neuesten Generation, vor allem die Betreuungsqualität be rücksichtigt und nachhaltig gefördert.
Der Erfolg stellt sich ein, weil die Mit glieder systematisch und ohne per sonalabhängige Schwankungen der
Dienstleistungsqualität extrem gut be treut werden. Neben den digitalen Er fassungsmöglichkeiten des Trainings, werden regelmäßig Krafttests und BIA-Messungen durchgeführt. Über eine App können Mitglieder die eige nen Trainingserfolge nachverfolgen.
Im CIRCLEONE® Club durchlaufen die Mitglieder alle Bereiche des Trainings in maximal 35 Minuten. CIRCLEONE® plant jeden Club mit viel Liebe zum Detail, damit sich Mitglieder wohl fühlen und jeder Club eigene Erfolgsgeschichten schreibt.
Salzufler Straße 2 32052 Herford +49 (0) 5221 / 6999805 info@circleone.de www.circleone.de
Wir bei clever fit sind stolz darauf, mit derzeit über 500 Fitnessstudios in Deutschland und Europa zu den stand ortstärksten Franchiseanbietern von Fitnesskonzepten zu zählen. Nicht ohne Grund: Denn wir verfügen über 15 Jahre Expertise: skalierbare Gesundheitskonzepte, eine ausgereifte Fitnessstudioplanung, innovativste Technologien zur Digitalisierung, ausgefallenes Design und einer Weiterbildungsakademie für Ihre Mitarbei ter – alles aus einer Hand. Unsere Erfahrung ist Ihr Plus, Ihr Erfolg unser Ansporn.



Nach wie vor ist die Ursprungsidee von Gründer und CEO Alfred Enzens berger, körperliche Fitness mit Fokus auf hochwertige Geräte, kombiniert mit einem sehr guten Preis-LeistungsVerhältnis, einer sehr breiten Zielgruppe zu ermöglichen, so bestechend wie ein fach. Denn Fitness ist aktive Gesundheitsvorsorge, Krankheitsprävention und gibt dem Leben mehr Resilienz. Ein Grund mehr für Franchisesuchende die Fitnessbranche auf dem Radar zu haben.
Augsburger Str. 52 86889 Landsberg am Lech +49 (0) 8191 / 3052600 info@clever-fit.com www.clever-fit.com
Wofür steht die DSB-digital systemische Betriebskonzepte GmbH? Digital: Wir digitalisieren sämtliche Prozesse Ihres Clubs, angefangen vom automatisierten Vertrieb, über alle Verwaltungsaufgaben, Thekenlösungen bis hin zur gesamten Customer Journey.
Vor über zehn Jahren hatten wir die Vision vom Fitnessclub der Zukunft. Ein digitalisierter Fitnessclub, wo Mit glieder alles selbst steuern, verwalten und buchen konnten und Personal dort eingesetzt wird, wo es auch zur Wertschöpfung beiträgt. Dadurch ent standen hochprofitable Betriebstypen, die sowohl im Premium- als auch im Discountbereich hohe Erträge erwirt schaften. Heute vertrauen mehr als 200 Clubbetreiber als Franchisenehmer der DSB – entweder als „white label“ oder im Markenfranchise „MYGYM“.
Systemisch: Sämtliche DSB-Prozesse greifen ineinander und basieren auf ei ner optimalen Abstimmung von Hard ware und Software. Das ermöglicht jedem Fitnessstudiobetreiber Arbei ten auf höchstem, ISO-zertifiziertem, Standard.
Unser DSB-Netzwerk lebt von TopExperten aus den Bereichen IT, Mar keting und Unternehmensstrategie, aber auch von einem offenen und ehr lichen Austausch innerhalb der DSBCommunity. Werden auch Sie Teil der DSB-Community und entscheiden Sie sich für Ihren Erfolg.

Alpenstraße 95-97 A-5020 Salzburg
Am Leinwedel 6 D-74889 Sinsheim office@dsb.digital www.dsb.digital
DSB-Hector – Unternehmensberatung, Franchisegeber, Systemhaus, Digitalagentur Siegfried Manz & Christian Hörl | office@dsb.digital +49 (0) 7261 94 88 94 | www.dsb.digital
Erleben Sie, wie Sie Ihren Fitnessbetrieb mit dem Digitalisierungs- & Franchisekonzept der DSB gewinnbringend führen. Sie gehen mit einer klaren Perspektive für eine erfolgreiche Zukunft in der Fitnessbranche nach Hause.
DSB – Erfolg ist digital.
erfahre bei uns alles über das DSB FranchiseKonzept – im Whitelabel oder als erprobtes und erfolgreiches MYGYM-Fitnessstudio.
Melde Dich jetzt zu einem der Termine an & nimm Deine Zukunft selbst in die Hand!


Als professioneller Dienstleister im Bereich Medical Fitness und Gesund heitssport beschäftigt sich Exclusive mit dem individuellen Training bei Rückenbeschwerden, anderen orthopädischen Problemen und HerzKreislauf-Beschwerden.
Die Konzeption der Exclusive Clubs steht bewusst in direktem Zusammen hang zu der demografischen Entwick lung in Deutschland und bietet der älteren Generation und Personen die auf außerordentliche Qualität Wert le
gen ein individuelles präventives und rehabilitatives Angebot. Dabei setzen die Clubs auf ein extrem hochwertiges Trainings- und Betreuungskonzept in einem exklusiven Ambiente, eine Kombination aus medizinischem Fit nesstraining und modernster Technik.



Im Oktober 2014 wurde der Exclusive Medical Fitness GmbH im Bundesmi nisterium für Wirtschaft und Energie in Berlin der Gründerchampions Award 2014 (Saarland) von der KfW (Kre ditanstalt für Wiederaufbau) verliehen; zudem ist Exclusive Vollmitglied im Deutschen Franchiseverband.

Mitglieder so überdurchschnittliche Ergebnisse. fitbox® ist weltweit erster Anbieter mit einem strukturierten Vor verkaufskonzept, womit die Franchiselizenzpartner bereits vor Eröffnung planbare Umsätze, Kundendaten und Beratungstermine sicherstellen. Über 100 Standorte und eine Zentrale in Berlin mit fast 20 Mitarbeitern gehören inzwischen zum Netzwerk.
Bliesgaustr. 3 66440 Blieskastel +49 (0) 6842 / 9730101 info@exclusive-clubs.de www.exclusive-clubs.de

Das Franchise-Netzwerk fitbox® be treibt EMS-Mikro-Fitnessstudios mit einem besonderen Alleinstellungs merkmal. Hier wird die Elektrische Muskel-Stimulation mit Ganzkörperkraftund Kardiotraining mit Ernährungs coaching durch einen Personal Trainer kombiniert. In nur 20 Minuten Training pro Einheit und max. zwei Einheiten pro Woche erzielen fitbox®
Oranienburger Straße 5c 10178 Berlin +49 (0) 30 / 51304978 franchise@fitbox.de www.fitbox-franchise.com
Das Franchisesystem EASYFITNESS. club ist ein Anbieter von Fitnessstudios. Inzwischen zählt EASFITNESS zu den größten Fitnessketten in ganz Europa. Durch die Diversifizierung der eigenen Marken macht es dem Franchisenehmer in Zukunft noch leichter, sein eigenes Business aufzubauen oder den vorhandenen Markt zu sichern. Durch das Multi-Franchisesystem mit den Tochtermarken EASYFITNESS „Lifestyle & Sport“ (Discount), „Premium“,







„EMS“ und „The Smart Gym“ (vollautomatisierte Microstudios) können die unterschiedlichsten Zielgruppen an gesprochen und so das vorhandene Marktpotenzial noch besser ausge schöpft werden.
Nehmen Sie Kontakt mit uns auf www.easyfitness.club/franchise und gehen Sie den ersten Schritt in eine Zukunft voller Freiheit, Möglichkeiten, Erfolg und Selbstbestimmung.

Lifestyle-Entwurf stetig weiter aus. Mittlerweile zählt unsere Fitnesskette 28 eröffnete Clubs. Moderne Geräte, fundierte Trainingsmethoden und ei gens ausgebildete Trainer sind für uns ebenso wichtig wie der einladende Wellnessbereich inklusive Sauna, Solarium und Massage.
Das Besondere am FitnessLOFT? Wir bieten eine Vielfalt, die das Fitnessherz höherschlagen lässt. Mit Deiner Vision und unserer Erfahrung, betreuen wir Dich individuell auf dem Weg von der Idee bis hin zu Deinem eigenen LOFT.

Trainieren kannst Du überall – zu Hause bist Du nur bei uns im FitnessLOFT. „Feels like home“ – das Motto darf man wörtlich nehmen. Hier trifft ein breit gefächertes Fitnessangebot auf innovative Ausstattung, stylisches LoftDesign und ein familiäres Miteinander.
Seit der Gründung 2009 breitet sich FitnessLOFT mit seinem individuellen
Das Lizenzkonzept GET FIT eignet sich für Personal Trainer, Quereinstei ger und Menschen, die bisher nicht aktiv in der Branche tätig waren. Das Lizenzsystem basiert auf den fünf Säulen: Fitnessgeräte, Studioausstat tung, Onboarding der Lizenznehmer, Digitalisierung und Onlinemarketing.
Ist ein Standort gefunden, wird die Raumaufteilung und Ausstattung des Studios mithilfe eines 3D-Planers vi sualisiert. Wurden die Räumlichkeiten dann an die Bedürfnisse angepasst, beginnt die Studiobranding-Phase, in der die Ausstattung angeliefert und installiert wird. Zudem wird der Lizenz nehmer mit einem Branding-Paket ausgestattet. Ist dieser Prozess ab geschlossen, können die Mitglieder zum Training kommen. Damit diese dann auch kommen, sollte der Be treiber rechtzeitig mit Marketingmaß nahmen beginnen. Den Hauptanteil dabei macht das Onlinemarketing aus.
Die Marketingmaßnahmen werden zentral geschaltet. Um das Ziel des Break-even optimalerweise mit der Neueröffnung zu erreichen, werden die ersten Werbemaßnahmen ca. 6 Monate vor der Eröffnung geschaltet.
GET FIT bietet drei Pakete an, die sich bzgl. Fläche und Ausstattung unter scheiden. Das SMART-Konzept bie tet Ausstattung für eine Größe von ca. 200 m2. Das Paket „BOUTIQUE“ wurde für eine Größe von ca. 300 m2 und die „CLUB“ Variante für Clubs ab 500 m² konzipiert.
Böcklerstraße 30 38102 Braunschweig +49 (0) 531 / 79389640 franchise@fitnessloft.de www.fitnessloft.de/franchise

Am Bahnhof 11 63607 Wächtersbach +49 (0) 176 / 96943897 info@getfit-lizenz.de www.getfit-preiswerttrainieren.de

M.A.N.D.U. ist österreichischer EMSMarktführer und begeistert Member seit mittlerweile 10 Jahren mit einem hocheffizienten EMS-GanzkörperTraining, kombiniert mit individuellem Personal Coaching in Privatsphäre. Über 3.600 Mitglieder in Europa in 38 Stores und in insgesamt mehr als 50 Stores in fünf Ländern sind davon bereits begeistert.

Nach dem Motto „Maximale Wirkung, minimaler Zeitaufwand“ stärken die Mitglieder bei M.A.N.D.U. – immer be gleitet von einem Personal Coach – in nur 15 Minuten einmal pro Woche ihre Muskeln. Das EMS-Training kräftigt gelenkschonend die gesamte Musku latur und die Trainingserfolge sind mit der InBody-Waage 770 sofort spürund messbar.



„M.A.N.D.U. ist das einzige Franchisesystem, welches als Genossenschaft
organisiert ist“, führt M.A.N.D.U. Initiator Philipp Kaufmann aus und ergänzt: „Der Franchisenehmer ist damit nicht nur sein eigener Chef, sondern auch am Franchisegeber beteiligt.“ Dazu M.A.N.D.U.-Genossenschaftsvorstand
Christian Mayrleb: „Jeder Partner ist Miteigentümer. Nach dem Motto ‚einer für alle und alle für einen‘ sitzen alle Franchisepartner im selben Boot und bestimmten gemeinsam die Geschicke des Systems. Zudem haben wir eine Struktur aufgesetzt, wo wir nur 3 % Franchisegebühr verlangen – kosten günstiger geht es nicht.“

Franchisenehmer von INJOY profitieren Sie von den vielen Vorteilen eines gro ßen Verbundes unter einer starken und bekannten Marke.
INJOY ist eines der führenden Franchisesysteme in der deutschen Fitness- und Freizeitbranche. Ein flächendeckendes Netzwerk inhabergeführter QualitätsFitnessanlagen. Individuell und flexibel. Unsere Franchisepartner sind sowohl in urbanen Hotspots als auch in ländli chen Regionen vertreten.


Mit INJOY haben Sie einen erfahre nen Partner für Ihr Unternehmen. Als
Mit dieser gemeinsamen Stärke und Strategie steht Ihrem Erfolg nichts mehr im Wege. INJOY schafft die notwendige Flächendeckung und transportiert ein positives Image und einen hohen Be kanntheitsgrad. Gesundheitsorientier tes Fitnesstraining ist ein effizientes Produkt mit Zukunft. Unser Auftrag lautet: Mehr Menschen an ein gesundes und aktives Leben zu führen. Starten Sie mit uns Ihre Unternehmerkarriere.
Valentin-Linhof-Straße 8 81829 München +49 (0) 89 / 45098130 info@aciso.com www.injoy.de

Die LifeFitGroup bringt Anfang 2023 das am schnellsten wachsende PilatesBoutique-Konzept – Club Pilates –nach Deutschland. Mit über 600 Fran chisestudios ist Club Pilates weltweit das größte Netzwerk von Reformer Pilates Studios. Trotz Pandemie hat Club Pilates seit 2020 mehr als 60 neue Studios eröffnet. Auch in Spanien eröffneten bereits in kürzester Zeit sechs erfolgreiche Studios und zei gen mit dem schnellen Wachstum, wie hoch der Bedarf auch in Europa ist. Aufgrund des beeindruckenden natio nalen und internationalen Wachstums wurde Club Pilates 2019 und 2020 auf Platz 1 der Franchise Times® Fast & Serious gewählt.
Franchisenehmer profitieren von einem erfolgreichen Premium-Boutique-Kon zept, das sich etabliert hat. Die LifeFit Group steht ihren Franchisenehmer auf dem Weg in die Selbstständigkeit mit ihrer umfassenden Erfahrung in allen
Phasen der Unternehmensgründung und -führung mit kontinuierlicher und professioneller Beratung zur Seite.
Für Mitglieder jeden Alters und jeden Trainingslevels ist das Training, das auf Joseph Pilates ursprünglicher Me thode „Contrology“ basiert, ideal. Die Studios bieten mit 12 Reformern aus gestattet, verschiedene Gruppenkurse für unterschiedlichste Trainingslevels, sowie einen privaten Trainingsraum. Ein skalierbares Konzept, das es so auf dem deutschen Markt bisher noch nicht gibt.
Erfolgreich als PRIME TIME fitness Franchisenehmer!










In Kennzahlen wie Mitglieder pro m2, Umsatz pro Mitglied, Cashflow-Marge, „time to break even“ setzt PRIME TIME fitness Benchmarks. Eröffnen Sie Ihren PRIME TIME fitness Club in attraktiver Lage auf 350-1.200 m². PRIME TIME fitness steht für Premium Training und bietet, einzigartig auf dem Markt, Per
sonal Training im Abomodell an. Die Ausstattung ist handverlesen und bie tet das beste der Branche vereint an ei nem Ort. Auch Sie erwartet unsere Un terstützung. Ein Team aus Spezialisten verschiedener Fachbereiche steht Ih nen von Tag 1 an zur Seite. Erfüllen Sie sich Ihren Traum vom Unternehmer und werden Sie als Franchisenehmer erfolgreich!
Selbstständig werden mit dem besten Mrs.Sporty aller Zeiten! Mrs.Sporty ist als vierfach ausgezeich netes „Bestes-Franchise-System“ der richtige Partner für den eigenen Fitnessclub. Das erfolgreichste und innovativste Gesundheits- und Fitnesskonzept für Frauen in Europa ermöglicht wirt schaftlichen Erfolg, Selbstbestimmung und Flexibilität im Alltag. Als erster Body positive Fitnessclub der Welt bie tet Mrs.Sporty seinen Mitgliedern maß geschneiderte, individuelle Trainingseinheiten, abwechslungsreiche Kurse, angepasste Ernährungspläne, Abnehmcamps und gesundheitsfördernde Angebote, wie das spezielle Beckenbodentraining, Lymphmassagen und Schmerzlinderungs- und Beweglich keitsprogramme. Die Steigerung der Lebensqualität der Frauen ist bei Mrs. Sporty immer das Ziel.

Jetzt ist Ihre Zeit!
Ob Quereinsteiger oder Profi: Mit
„Sporteve® – Pure Lady Fitness“ ist eine Sportclubmarke von Frauen für Frauen. Zur Zielgruppe zählen alle Frauen, unabhängig von Alter und Fitnesslevel. Im Mittelpunkt steht das Zirkeltraining mit effektiven 30minütigen Sporteinheiten. Teil des am Markt erprobten Konzepts ist zudem ein schlaues Ernährungsprogramm, inklusive eigenen Proteinprodukten und optionale Kurse wie Yoga, Zumba, BBP oder TRX-Training. Auch Rehaund Präventionstraining ist möglich. Die Kurse sind hoch effektiv und pas sen in jeden Terminkalender. Egal, ob die Konzeptlinie „gerätegestütztes“ oder„FunXtion“ Training im Studio ge lebt wird, es ist immer ein Trainer vor Ort, der das Mitglied begleitet.

Jetzt Sporteve® -Partner werden Begeistern Sie sich für Frauen-Fitness und möchten mit einer starken Marke in die Selbstständigkeit starten? Oder besitzen Sie bereits einen Club und
unserer starken Marke im Rücken und einer großen Franchise-Community, bekommen Sie immer volle Unterstüt zung durch die Franchisezentrale und von allen anderen Franchisepartnern.
Ihre Vorteile als Mrs.Sporty Franchisepartner sind: Geringes Startkapital und hohe Profitabilität, Gebietsschutz und Standortanalyse für optimale Startbedingungen und Sicherheit, Unter stützung im Marketing, Vorverkauf und bei der Mitgliederbindung und kontinu ierliche Aus- und Weiterbildungen für den Erfolg Ihres Clubs.
Helmholtzstraße 2-9 10587 Berlin +49 (0) 30 / 308305360 franchise@mrssporty.com www.mrssporty-franchise.com
suchen ein frisches Konzept, mit dem Sie sich weiterentwickeln können? Das Partner-System von „Sporteve® –Pure Lady Fitness“ bietet Ihnen tolle Wachstumschancen.
Wir möchten, dass Sie erfolgreich sind. Deshalb unterstützen wir Sie als Sporteve®-Partnerin nicht nur mit auf merksamkeitsstarken Marketingmaß nahmen, sondern geben Ihnen auch Hilfestellung bei Fragen rund um die Themen Unternehmensgründung und -führung, Standortwahl, Investitionen und Weiterbildung.
„Train Different!“, das verspricht das amerikanische Fitnessfranchise UFC GYM weltweit. Nun startet das Konzept auch auf dem deutschen Markt durch. Das Angebot reicht von UFC inspirier ten Mixed-Martial-Arts Kursen, über klassische Fitnessprogramme, bis hin zu Wellness- und Recovery-Leistungen. Mit starken internationalen Partnern wie Gympass, Les Mills oder dem in novativen Healthtech-Unternehmen Myzone, verspricht UFC GYM den hie sigen Fitnessmarkt nachhaltig zu ver ändern. „Individualität und Ganzheit lichkeit sind für ein effektives Training essenziell, weil eben nicht alle Gäste dieselben Ziele oder Ausgangspunkte haben. Schon lange sucht die Ziel gruppe nicht mehr nur nach Erfolgen im Spiegel, sondern vielmehr das Ge fühl, etwas Gutes für sich selbst getan und die eigenen Grenzen überwunden zu haben. Und genau dafür stehen wir!“, so Robert Jablukov CEO UFC GYM Germany.

Der erste Standort in Deutschland von UFC GYM Germany wurde am 19.11.2022 im Medienbunker St.Pauli (Hamburg) eröffnet. Weitere 60 UFC GYMs in ganz Deutschland sollen bis Ende 2032 folgen. „Wir sind auf der Suche nach geeigneten Franchise partnern, die gemeinsam mit uns die Marke UFC GYM und unsere „Train Different“-Philosophie vorantreiben wollen. Vor allem Standorte in Großstäd ten wie Berlin, München, Köln oder Frankfurt haben dabei eine große Be deutung für uns“.


Studiobetreiber gehen heute mit dem Trend der Zeit und setzen auf moderne Erlebniswel ten. Eine wirksame Attraktion für Kundengewinnung & Kundenbindung. In unserer schnell lebigen und hektischen Zeit nimmt der Trend zur Entspannung, Wellness und Gesunder haltung weiter zu. Daher ist die Schaffung von Erlebniswelten, die diesem Trend folgen, ein zukunftssicheres Geschäftsmodell für Ihr Studio.
medi stream ® – hinlegen, entspannen, wohlfühlen
Die Überwassermassageliege medi stream® spa sowie das Medical-Produkt medi stream® 3000 sind die Synthe sen drei bekannter und bewährter Behandlungsformen zu einem inno vativen Ganzen. Sie bieten sowohl die stimulierenden Elemente der Unterwassermassage, der klassischen Massage als auch die wohltuende Wir kung der Wärme.

medi Lounge – eintauchen, entde cken, relaxen
Gestalten Sie Ihren Raum durch eine individuelle Ausstattung nach Auf maß oder nutzen Sie die freistehende
Lounge und verschaffen sich so einen zusätzlichen „Raum“ in Ihrem Studio. Bestimmen Sie aus der vielfältigen Auswahl „IHR MOTIV“.
Solevitarium – hinsetzen, einatmen, genießen In einer wunderschönen Umgebung mit fantastischem Panorama können Körper, Geist und Seele für eine kurze Zeit Urlaub machen. Der Sole-Ultra schallvernebler erzeugt aus einer spe ziellen Solelösung mikrofeinen, trocke nen Nebel, der über die Atmung und über die Haut aufgenommen wird. In Verbindung mit reinem Sauerstoff und negativen Ionen entsteht die optimale Vitalkur für den ganzen Körper.
Solarium & Collarium – liegen, bräunen, regenerieren Erleben Sie intensives Sonnenlicht mit extrahohem UVB-Anteil für verstärkten Pigmentaufbau und Vitamin-D-Bildung oder entspannen Sie im Beauty-Licht, welches die körpereigene Collagen produktion in der Haut aktiviert.
EQUIMED Vertriebs GmbH Wilhelm-Röntgen-Str. 4 59439 Holzwickede Tel. +49 (0) 2301 / 188900 E-Mail: info@equimed.de Web: www.equimed.de

 Text Jan Paffhausen
Text Jan Paffhausen
Faul, verwöhnt und unbelastbar sind nur einige Attribute der langsam auf den Arbeitsmarkt drängenden Generation Z. Dass diese Generation aber durch aus leistungsfähig und auch bereit ist, weiß unser Gastautor Jan Paffhausen. Er hat jede Menge Tipps im Gepäck, wie man mit dieser Generation umgehen kann.
Alle Lebensbereiche haben eines ge meinsam: Sie werden durch und mit Menschen zum „Leben“ erweckt. Er folgreiche Kundenakquise, erfolgreiche Kundenbetreuung und erfolgreiche Kundenbindung erfordern das Ver ständnis der Bedürfnisse und Erfahrun gen des Gegenübers. Dies bedarf einer empathischen und eindeutigen Kom munikation. Eindeutige Kommunikation kann z. B. im Funkverkehr zwischen Piloten und Fluglotsen eindrucksvoll
beobachtet werden. Klare Fakten und Intentionen werden durchgegeben und durch „Readbacks“ bestätigt. Ohne diese Bestätigungen würde durch fal sche Aussprache, schlechte Tonquali tät oder unklare Anweisungen Chaos in der Luft herrschen – mit nicht vorstell baren Folgen für die Flugsicherheit.
Nun kann im Flugverkehr nicht von ei ner empathischen Kommunikation ge sprochen werden, wenn blanke Fakten
und Intentionen ausgetauscht werden. Empathie ist die Fähigkeit, sich in die Einstellungen anderer Menschen ein zufühlen – und die Bereitschaft dazu. Empathie und eindeutige Kommuni kation sind allerdings nicht nur „Tools“, um Kunden zu gewinnen und zu bin den. Sondern sie sind auch essenziell im Personalrecruiting und bei der Per sonalbindung. Zwei Bereiche, die die Fitness- und Gesundheitsbranche seit Jahren beschäftigt.













Konflikte im Personalrecruiting und der Personalbindung entstehen häufig durch Generationenkonflikte. Aktuell befinden sich vier Generationen auf dem Arbeitsmarkt: die Babyboomer (Jg. 1950–1965), Generation X (Jg. 1965–1980), Generation Y (1980–1995) und die „berühmt-berüchtigte“ Generation Z (Jg. 1995–2010). Jede Generation wird von der vorangegan genen Generation beeinflusst. Erzie hung, Werteinstellungen, Prägungen und Glaubenssätze in der Arbeitswelt werden entweder verstärkt ausge prägt oder versucht, komplett anders zu gestalten.
Die Babyboomer, die in den nächsten Jahren aufgrund Renteneintritt peu à peu aus dem Arbeitsmarkt ausschei den, ist die Generation der „vielen“. Loyalität, Idealismus und Karrieres treben sind zentrale Ausprägungen. Allerdings musste diese geburten stärkste Generation auch auf dem Ar

beitsmarkt hart „kämpfen“, da es viele Mitbewerber gab. Folglich hat sich das Karrierestreben in der nachfolgenden Generation X verstärkt. „Ich“, meine Karriere und meine Statussymbole waren und sind die Glaubenssätze in der Arbeitswelt. Wohlstand und Mate rielles haben einen großen Stellenwert. Arbeit steht im Fokus, um diese bei den Ziele zu erreichen. Die Generati
diesem Hinterfragen der traditionellen beruflichen Vorstellungen.
Generation Z in der Diskussion Über die Generation Z wird sehr rege dis kutiert. Viele Vorurteile kursieren in den beruflichen Netzwerken. Kein Arbeitswille, freizeitorientiert, Selbstdarsteller. Aktuell macht diese Generation einen geringen Anteil am Arbeitsmarkt aus,
on Y stellt diesen Fokus infrage. Sind Wohlstand und Materielles wirklich das Wichtigste? Was trage ich Sinn volles bei? Das Streben nach indivi dueller Selbstverwirklichung hat sich auch durch die aufkommende Optionenvielfalt beschleunigt, die sich durch das Internet aufgetan hat. Der Begriff der „Work-Life-Balance“ kommt aus
der aber in den nächsten Jahren an steigen wird – und damit großen Ein fluss auf die Arbeitswelt haben wird.
„Wie kann mein Gegenüber auf seiner Insel nicht verstehen, was ich auf mei ner Insel denke?“ Ein Zitat von Vera F. Birkenbihl, einer deutschen Manage menttrainerin. Auf den Kontext des
Generationenkonfliktes angewandt: Wir setzen die eigenen Wert- und Ar beitsvorstellungen als Selbstverständ lichkeit voraus, die das Gegenüber kennen muss. Daher ist das Wissen um den anderen so essenziell für den Kommunikationserfolg. Und das Wissen über die Generation Z für den Erfolg in deren Recruiting und Bindung.

Die Generation Z steigt mit einem hoch ausgeprägten Selbstbewusstsein in die Arbeitswelt ein, was nicht überraschen sollte. In der Schule werden der de mografische Wandel und der auf kommende Fachkräftemangel thema tisiert, von dem die „Zler“ profitieren. In der Erziehung wird häufig vermittelt, dass die Zöglinge alles können und bei falscher Auswahl der Karriereweg neu eingeschlagen werden kann. Es ent steht eine Entkoppelung des eigenen Anspruchs und der Anstrengung, die für diesen Anspruch geleistet werden muss. Die Zler sehen somit die Berg spitze, aber nicht den anstrengenden Weg, der auf den Gipfel führt. Daher wird schon früh der Anspruch auf eine Führungsposition formuliert, obwohl die Fertigkeiten hierzu noch nicht aus geprägt sind. Folglich kommt Unzu
friedenheit auf, die den eingeschlage nen Weg infrage stellt. Dropouts sind somit die Regel.
Einen bestimmten Karriereweg zu verfolgen bedarf einer klaren Ent scheidung. Die Optionenvielfalt, die an Ausbildungen, Studiengängen oder weiteren beruflichen Möglich keiten existiert, macht es zunehmend schwierig, einen klaren Weg einzu schlagen. Es könnte stets eine Mög lichkeit geben, die noch besser ist. Aus den sozialen Netzwerken kennt man die „Fear of Missing Out“ (FOMO). Sprich, die Angst, spannende Events zu verpassen, wenn entsprechende Beiträge angezeigt werden. Die Ge neration Z ist mit den sozialen Medien wie Instagram, Snapchat und TikTok aufgewachsen. Da verwundert es nicht, dass sich die „FOMO“ auch auf die Karriere überträgt.
Die beherrschenden gesellschaftli chen Themen der letzten Jahre, die allesamt als Krisen gelten dürften (Klimawandel, Corona, Ukraine-Krieg, nun Energiekrise), haben zu einem Pa radox geführt. Auf der einen Seite hat sich mit der „Fridays for future“-Bewe gung gezeigt, dass sich die Genera tion Z vehement für ein höheres Ziel
einsetzen kann. Auf der anderen Seite sorgen die Krisen für Unsicherheit im Leben der Zler.
Bei Unsicherheit und Entscheidungs mangel sucht der Mensch naturgemäß die Sicherheit bei anderen Menschen. Bei den Zlern sind es die Eltern, die diese Sicherheit bieten. Zum einen mit der Möglichkeit, lange im gewohnten Umfeld zu verharren. Zum anderen mit einer beratenden, unterstützenden Funktion. Die Kommunikation auf Au genhöhe, wie eine Art Lebensberater oder Coach, überträgt sich auch auf die Erwartung in der Arbeitswelt. Mit autoritären oder dominanten Füh rungsstilen kann somit nicht umge gangen werden, da sie nie erfahren wurden.
Soziale Netzwerke gehören zum Alltag dazu
Der Lebensbereich, in dem Eltern na hezu „machtlos“ sind, ist der Umgang mit sozialen Netzwerken. Der Wandel an Angeboten für Jugendliche und junge Erwachsene ist rasend schnell. Hatte Facebook vor 10 Jahren noch die Vormachtstellung im Internet, ist es heute TikTok auf dem Smartpho ne. Eine Führung durch diesen dich ten Wald an Angeboten durch Ältere
bereiten die wichtigsten Muskelketten auf das Krafttraining vor.

wirken Verspannungen und Fehlhaltungen aus dem Alltag entgegen.
mit Schuhen und im Stehen. für eine breite Zielgruppe, da Übungen im Knien entfallen.
für geringen Platzbedarf und mehr Durchlauf in Deiner Einrichtung.
ist fast nicht möglich. Somit probieren sich die Zler aus und erkunden die an gebotenen Apps und Funktionen auf eigene Faust. Die digitalen Fähigkei ten, die sich die Zler selbst erwerben, können im Arbeitskontext Gold wert sein. Es gibt keine Generation, die versierter in Sekundenschnelle Inhalte sichten und filtern kann. Zudem weiß sich keine Generation besser in Szene zu setzen und zu vermarkten. Nur das Besondere führt zu Likes und Follo wern. Eine schnelle Anpassung an den Zeitgeist ist hierfür elementar.
Der Zeitgeist an Wertvorstellungen unterscheidet sich deutlich von den vorhergehenden Generationen, wobei sich Elemente der Generation Z darin wiederfinden. Der Begriff der „WorkLife-Balance“ wurde neu interpretiert –mit dem Fokus auf „life“. Reisen, Mode und Hobbys sind Priorität. Ar beit, hohes Einkommen und Statussymbole sind nachrangig. Dies be deutet nicht, dass die Zler keine Überstunden machen möchten. Der Ausgleich dieser Zeit ist gewünscht. Im Arbeitsumfeld ist der Generation Z das Arbeitsklima am wichtigsten, noch vor dem Überstundenausgleich oder Einkommen. Arbeit soll nicht nur ernst sein, sondern auch Spaß machen –mit den Kollegen. Die Zler suchen auch auf der Arbeit nach echten, festen Bindungen. Menschlichen Bindungen, die im Kontext der sozialen Medien so nicht realisiert werden können. In der Anonymität der Followerzahl können diese Bindungen auch nicht entste hen. Jedoch werden diese häufig als solche interpretiert, wenn z. B. Likes weniger werden oder Follower „ent folgen“. Im Aufbau echter Bindungen liegt eine Chance für das erfolgreiche Recruiting und die Bindung dieser Ge neration. Aus den Eigenschaften der Generation Z folgen klare Handlungs empfehlungen für Recruiting, Onboar ding und Bindung.
Recruiting Tipp #1: Einer der zentrals ten Aspekte im Recruiting der Gene ration Z ist, seine Stellenangebote als Produkte zu sehen, die verkauft wer den müssen. Branchen und Unterneh men stehen im ständigen Wettbewerb um dieselbe Zielgruppe. Der eigene Webauftritt sollte daher auf den Prüf stand gestellt werden:
• Sind meine Stellenangebote auf einen Klick zu erreichen? Und kann ich mit dem 2. Klick direkt den Bewerbungsprozess einleiten? Ist mein Bewerbungs prozess mobil optimiert und kann vom Smartphone oder dem Tablet durchgeführt werden?
• Habe ich Hürden im Bewer bungsprozess, wie bestimmte Dateiformate, Obergrenzen der Dateigröße, fehlende An sprechpartner oder mehrere Bewerbungsgespräche?
• Berücksichtige ich die zentralen Wünsche der Generation Z im Arbeitsumfeld, wie z. B. Über stundenausgleich, angenehmes Arbeitsklima, freies WLAN oder betriebliche Altersvorsorge?
• Wie wirke ich nach außen auf die Bewerber? Spreche ich nur über meine eigene Kompetenz als Unternehmen oder spreche ich den Beitrag an, den die poten ziellen Bewerber für mich und die Kunden bzw. Mitglieder leisten können?
Die Übersicht an Stellenangeboten und die Bewerbung müssen ähnlich einfach einsehbar und beziehbar sein, wie Mitgliedschaften und Produkte an die eigene Kundenzielgruppe.
Recruiting Tipp #2: „Future talents“ bewerten gerne den sozialen Ein druck, den Unternehmen hinterlassen. An dieser Stelle wird ein Abgleich mit den eigenen Wertvorstellungen vorge nommen. Die Chancen auf eine Be werbung steigen oder fallen mit dem Maß an Übereinstimmung. Welcher Vision, welchem Zweck folgt das Unternehmen? Setze ich mich für die Ge sunderhaltung der Menschen ein oder ist meine Vision, Spaß und Ausgleich vom Alltag anzubieten? Dann ist dies eindeutig und gut sichtbar zu kommu nizieren. Sie werden damit die Interes senten anziehen, die diesem Zweck folgen können und entsprechend Bindung zum Unternehmen aufbauen können.
Recruiting Tipp #3: Im Bewerbungs gespräch sollten Sie vorbereitet den Bewerbern gegenübertreten. Damit können Sie individuell auf diese ein gehen und zeigen Wertschätzung. Stellen Sie eine möglichst lockere, ungezwungene Atmosphäre her. Ein neutraler Ort, wie das Café um die Ecke, kann hierzu beitragen. Denken Sie auch an die Sitzkonstellation. Sich frontal gegenüberzusitzen heißt auch Konfrontation. Wenn Sie sich um die Ecke den Bewerbern zuwenden, zeugt dies von Kooperation.

















Das Onboarding der jungen Nach wuchskräfte beginnt bereits vor dem ersten Arbeitstag. Die erlernte Augenhöhe, auf der die Generation Z kommunizieren möchte, verlangt Wertschätzung. Sie zeigen diese mit kleinen Gesten. Dies kann eine E-Mail sein, in der Sie die Vorfreude auf den neuen Mitarbeiter zeigen. Dies kann auch ein Schreiben sein, das die wich tigsten Fragen beantwortet. Die direk ten Ansprechpartner, der Ablauf des ersten Tages oder auch der Lageplan mit möglichen Verweilorten der Mit tagspause können Bestandteil sein. Sie halten damit nicht nur Kontakt, um mit Wertschätzung den Zeitraum des Vertragsabschlusses und dem Arbeitsbeginn zu überbrücken. Sie reduzieren auch Unsicherheiten und nehmen damit die Rolle des Beraters auf Augenhöhe ein.
Mit Beginn der Tätigkeit sollte auch ein Onboardingplan vorliegen, an dem sich die Neulinge orientieren können. Hier lässt sich der „Nutzen“ des Mitar beiters für das Unternehmen deutlich machen. Zudem können „Dos“ und „Don’ts“ einfließen, die verschriftlicht für mehr Verbindlichkeit sorgen. Wich tig: auch die kleinen Teilerfolge auf dem Weg zum optimalen Onboarding zu feiern. Meilensteine des ersten Jahres, wie z. B. das erste Telefonat, der erste Verkaufsabschluss oder der erste Trai ningsplan, sind wichtige Teilschritte im Onboardingprozess. Dieser lässt sich
auch gut nach einem Jahr mit einer kleinen Teamfeier abschließen. Sollten Sie nicht wissen, was die Zler sich für eine solche Feier wünschen? Direkt fragen kostet nichts – und am besten bedienen Sie sich bei den Antworten der bereits eingearbeiteten Zler. Dann können Sie nichts falsch machen.
Auch bei der erfolgreichen Bindung der Generation Z ist Kommunikation Trumpf. Mit regelmäßigem Feedback zeigen Sie den jungen Talenten, dass Sie sich für deren Lern- und Arbeits prozess interessieren und darum sor gen. Dabei sollte nicht das jährliche Personal- oder Feedbackgespräch im Fokus stehen. Vielmehr sind es die kleinen, kurzen Feedbackgespräche, die Kontinuität sicherstellen. Und sie sorgen dafür, dass die Nachwuchs kräfte den Weg zur Bergspitze bei behalten und nicht kurz vorher in den Abgrund stürzen.

Nutzen Sie die digitale Kompetenz der Generation Z, indem Sie sie in SocialMedia-Aufgaben einbinden oder ent sprechende Projekte fördern. Sie er möglichen so auch Teamarbeit, die den Zlern wichtig ist. Stichwort an genehmes Arbeitsklima. Zudem be friedigen Sie ein Grundbedürfnis der Generation Z: die Nutzung des Smart phones. Die „FOMO“ und der Entzug vom digitalen Endgerät sind dann nicht mehr ganz so groß. Bei Projekten, die die Zler selbstständig angehen dürfen,

ist darauf zu achten, dass sie nicht einfach ins kalte Wasser geschmissen werden. Denn das ist diese Generati on größtenteils von zu Hause nicht ge wohnt. Durch Darstellung des „worst case“ und des „best case“ grenzen Sie den Korridor ein, was als Ergebnis folgen kann. Indem Sie Checklisten durch Ihre eigene Expertise erarbei ten, führen Sie die jungen Menschen zum „best case“ – und damit zu höhe rer Selbstkompetenz und der dazuge hörigen Wahrnehmung.
Von Mensch zu Mensch
Das Recruiting und die Bindung der Generation Z, aber auch aller anderen Mitarbeiter kann sich erfolgreich ge stalten, wenn eines vorliegt: mensch liche Führung. Durch investierte Zeit, Aufmerksamkeit und Wertschätzung werden die Grundlagen für ein vertrau ensvolles Miteinander gelegt. Jeder Mitarbeiter ist Sohn oder Tochter eines Elternteils. Welche Führung im Arbeits kontext würden Sie Ihren eigenen Kin dern, Nichten oder Enkeln wünschen?
Quellen:
Maas, R. (2019). Generation Z für Personaler und Führungskräfte. Ergebnisse der Generation-Thin king-Studie. München: Carl-Hanser.
Schlotter, L. & Hubert, P. (2020) Generation Z –Personalmanagement und Führung. 21 Tools für Entscheider. Wiesbaden: Springer Sinek, S. (2017). Leaders eat last. London: Penguin LLC US
Jan Paffhausen hat an den Universitäten Stuttgart und Tübingen Sportwissenschaft mit dem Profil „Gesundheitsför derung“ (Master of Arts) studiert. Nach dem Studium hat er als Bewegungs analyst und als Bildungsreferent für Trainerausbildungen im Radsport gear beitet. Er ist zudem Inhaber der B-TrainerLizenz Leistungssport Radsport. Am IST-Studieninstitut ist er schwerpunkt mäßig für die Ausbildungsbetriebe und Betreuung der Auszubildenden und Stu dierenden an den Standorten Stuttgart und Frankfurt/Main verantwortlich.
Willst du Teil der größten, vielfältigsten und flexibelsten SportCommunity in Europa werden? Profitiere von unseren kostenlosen Marketing- und Vertriebsdienstleistungen sowie zusätzlichen Einnahmen aus B2B- und B2C-Kundengruppen!


 Text Dr. Thomas Kruse
Text Dr. Thomas Kruse
Aufgrund steigender Preise sehen sich viele Fitnessstudios gezwungen, die Mitglied schaftspreise zu erhöhen. Viele Betreiber rechnen allerdings mit einer daraus resultieren den hohen Kündigungsquote. Wie preissensibel die deutschen Mitglieder wirklich sind und ob sie Preiserhöhungen mittragen würden, wurde im Rahmen einer Befragung von etwa 400 Mitgliedern in ganz Deutschland untersucht.
Im Rahmen einer Studie zur Preissen sibilität von Fitnessstudiomitgliedern in Großbritannien (Allen, J. (2022): Price Rise Sensitivy Report) wurde heraus gearbeitet, wie Fitnessstudiomitglieder auf mögliche Preiserhöhungen, z. B. aufgrund steigender Energiepreise, reagieren könnten. Allerdings sind die Ergebnisse der britischen Studie we nig aussagekräftig, insbesondere für den deutschen Markt.
Aus diesem Grund wurde eine Um frage für den deutschen Markt entwi ckelt. Diese fragt nicht nur ab, bis zu
welcher Höhe Mitglieder eine Preisan passung tolerieren würden, sondern auch eine Veränderung des Nutzungs verhaltens sowie der Verzicht auf ei nige der gewohnten Leistungen wie Sauna, Schwimmbad oder Solarium, um dem Fitnessstudio zu Einsparun gen der Energiekosten zu verhelfen. Insgesamt nahmen etwa 400 Mitglie der von Fitnessstudios aus 26 Städten in Deutschland teil.
Ein Großteil der Befragten (72 %) wa ren männlich, der Anteil der weiblichen Teilnehmer lag bei 28 %. Beim Alter hin gegen zeigt sich eine deutlich breitere Verteilung. So stellten die Befragten im
Alter von 30–39 Jahren mit 27 % den größten Anteil, gefolgt von den 40- bis 49-Jährigen (22 %) und den 50- bis 59-Jährigen (21 %). 78 % der Teilneh mer sind seit über 2 Jahren Mitglied in einem Fitnessstudio, lediglich 8 % sind nicht in einem Fitnessstudio angemel det. Im Durchschnitt trainieren die Teil nehmer zwei- (33 %) oder dreimal (29 %) pro Woche. 19 % trainieren viermal, 6 % fünfmal pro Woche. 7 % der Mit glieder trainieren weniger als einmal pro Woche. Der Schwerpunkt des Trai nings liegt bei 74 % der Befragten bei Krafttraining auf der Trainingsfläche, 5 % nutzen hauptsächlich das Kursange bot und 17 % kombinieren Fläche und
Kurse. 5 % trainieren hauptsächlich im Kardiobereich und 12 % an einem Trainingszirkel. Ähnlich wie bei der Al tersstruktur liegt bei den bezahlten Mo natsbeiträgen eine breite Verteilung vor. 27 % der Mitglieder zahlen bis 50 € im Monat, 22 % bis 40 €, 10 % bis 60 € und über 60 € liegen 15 %.
Zustimmung zu Preissteigerung bei 50 %
Auf die Frage, ob die Mitglieder mit ei ner (moderaten) Preisanpassung des Mitgliedsbeitrages aufgrund gestie gener Kosten einverstanden wären, antworteten 51 % mit „Ja“ und 35 % mit „Nein“. Hinsichtlich der Höhe der monatlichen Anpassung sind 34 % mit bis zu 5 % Erhöhung einverstanden, 49 % der Befragten mit bis zu 10 % und je 7 % mit bis zu 15 % Erhöhung bzw. bis zu 20 %. Lediglich 3 % der Mitglieder würden eine Erhöhung über 20 % akzeptieren.
Interessant ist, das 83 % der Befrag ten, die unter 20 € Monatsbeitrag lie gen, zu einer Preisanpassung bereit sind, dagegen lediglich 30 % bei den Beiträgen bis 30 € bzw. 44 % bis 40 €. Erst bei den höheren Beiträgen steigt die Bereitschaft wieder bis auf 65 % (über 60€ Monatsbeitrag). Tendenziell neigen männliche Mitglieder eher zur Bereitschaft (58 %), während weibli che Mitglieder eher verhalten sind (32 % Zustimmung). Ein Großteil der Be fragten wäre mit 10 % Erhöhung ein verstanden – unabhängig von der Bei tragshöhe. Je günstiger das Studio, desto höher die Bereitschaft, etwas mehr zu zahlen.
Gründe, keine Preiserhöhung zu akzeptieren
Auch der Grund, warum Mitglieder eine Preiserhöhung nicht akzeptieren, wur de abgefragt. Die 35 %, die in der Frage nach einer moderaten Erhöhung mit „Nein“ geantwortet haben, begründeten dies folgendermaßen (Mehrfachnen nung möglich, daher Summe > 100 %):
44 %: Das Fitnessstudio ist schon teu er genug; 30 %: Ich habe nicht genug Geld, um mehr zu bezahlen; 51 %: Ich bin nicht bereit, mehr Geld für ein Fitnessstudio auszugeben; 16 %: Eine Preisanpassung ist ok, wenn mehr Zusatzleistungen angeboten werden; 12 %: Andere Gründe

Zu den „anderen“ Gründen konnten die Teilnehmer ein Textfeld ausfüllen.
Das hier waren die meistgenannten Antworten: „Es müsste an Geräten aufgestockt werden“, „Wir hatten ge rade erst eine Erhöhung“, „Die Qualität des Studios rechtfertigt nicht mehr“, „Auch in anderen Bereichen sind Kos ten gestiegen“.
Die letzte Frage zielte auf die Bereit schaft ab, über einen bestimmten Zeitraum auf einige Zusatzleistungen im Fitnessstudio zu verzichten, um bei Einsparmaßnahmen zu helfen: So wären 30 % der Befragten bereit, auf die Nutzung der Duschen zu verzich ten, 34 % auf die Sauna, 21 % auf das Schwimmbad (wenn vorhanden), 23 % auf das Solarium, 2 % auf Massagen und Trainer. Allerdings sind auch 23 % der Befragten nicht bereit, auf Leistun gen zu verzichten.
Die Befragung hat gezeigt, dass bei Mitgliedern durchaus Bereitschaft vor handen ist, eine Preisanpassung mit zutragen. Diese Befragung hat wäh rend der Energiekrise stattgefunden, somit ist den Befragten bewusst, dass auch die eigenen Lebenshaltungskos ten steigen. Die Preisanpassungen sollten moderat sein, gut begründet und nicht pauschal. In einem individu ellen Anschreiben sollte um Verständ nis gebeten werden und verschiedene Durchführungsarten von Fitnessketten haben gezeigt, wie man es besser nicht macht: Schweigen ist nicht im mer Zustimmung. Aus diesem Grunde ist es wichtig, das Mitglied als Partner zu sehen und mit ins Boot zu holen.
Das zahlt sich für uns beide aus

Dr. Thomas Kruse blickt auf über 25 Jahre Erfahrung in der Fitnessbranche zurück. Er ist Mit-Gesellschafter und Geschäftsführer einer Fitnesskette, Inhaber einer Physiotherapie und leitet eine Werbeagentur & Marketingbera tung. Zudem ist er auf vielen Netzwer ken in der Branche unterwegs.



In Zeiten von steigenden Energie- und Lohnnebenkosten wird der üblicherweise für Firmenfitness genutzte Sachbezug anderen Corporate Benefits wie Tank gutscheinen oder Öffentlichen Verkehrs mitteln weichen müssen.
Synfit 334 ermöglicht Betreibern BGF gesetzeskonform nach § 3.34 EStG (bis zu 50 € p.M. pro Mitarbeiter) anzubieten. Dieser gewichtige USP wird die Netz werkpartner in die Lage versetzen, den B2B Verkauf an Unternehmen zu fokus sieren und daraus einen bedeutenden Teil an Mitgliedern zu generieren.
Mehr Info unter: www.synfit334.de

Virtuagym ist ein globaler Anbieter von branchenführender Fitnesstechnologie und unter stützt Fitnessunternehmen jeder Form und Größe mit einer integrierten All-in-one-Lösung für Coaching, Management und Engagement.
Für Fitnessunternehmen waren zeitund kosteneffizientes Training und Ver waltung noch nie so bedeutsam. Mit Virtuagym können Clubs, Online-Coa ches und Personal Trainer ihre physi schen und digitalen Leistungen in einer hybriden Lösung vereinen. So werden Prozesse optimiert und Kunden wird rund um die Uhr eine personalisierte Experience angeboten.
Die umfassende Plattform beinhaltet eine innovative Coaching-Software, die sie zur ersten Wahl für Coaches macht, um Kunden persönlich und di gital zu trainieren. Mit einer individuell anpassbaren Coaching-App können Fitnesstrainer ihre Kunden virtuell be treuen, Trainingspläne erstellen und Fortschritte und Ernährung verfolgen. Außerdem können Kursbuchungen über eine automatisierte Planungs
software optimiert und Umsätze durch In-App-Verkäufe, Webshops und Werbeaktionen gesteigert wer den. Das Ganze kann mit EngagementTools wie In-App-Community-Funkti onen und Herausforderungen sowie mit Add-ons wie einer integrierten Video-Workout-Plattform kombiniert werden.

Darüber hinaus bietet Virtuagym auch eine intuitive Software für Management und Wachstum. Mit einer cloudbasierten Lösung werden Mit glieder verwaltet, Zahlungen automa tisiert, Produktverkäufe ausgewer tet und Zugangskontrollen für Clubs implementiert.
In Deutschland arbeitet Virtuagym bereits mit über 1.000 Fitnessunter nehmen zusammen, darunter Mrs.
Sporty, Prime Time Fitness, Zott Fit ness und der FT-CLUB. Seit einer bedeutenden Neuinvestition Anfang 2022 befindet sich Virtuagym in einer erneuten Wachstumsphase, insbe sondere auf dem deutschen Fitness markt. Dazu gehört auch die geplante Eröffnung eines neuen Bürostandorts in Deutschland, um die Servicequalität für den wachsenden deutschen Kundenstamm weiter zu erhöhen.
Kontakt
Virtuagym BV Keizersgracht 424, 1016 GC Amsterdam
Tel. +49 (0) 30 / 22027017 E-Mail: support@virtuagym.com Web: business.virtuagym.com/de


































































































































































































































 Text Till Pitschel
Text Till Pitschel
Wie wertvoll der Blick über den Tellerrand der Fitnessbranche ist, zeigten unsere Artikel in der Fitnessausgabe 4-2022. Am Beispiel der Buchhandelskette Thalia zeigt unser Gastautor, wie wichtig es ist, externe Einflüsse aus anderen Branchen und Ländern zu kennen, zu analysieren und dann bei sich im Fitnessstudio für die eigene Zielgruppe anzupassen.
Die deutsche Fitnesswirtschaft dient der Gesunderhaltung der Bevölkerung wie kaum ein anderer Wirtschafts zweig (dibdib, 2022). Das Streben nach körperlicher und mentaler Fitness ist aus dem öffentlichen Leben und den Social-Media-Plattformen nicht mehr wegzudenken. Für mich persönlich steht Fitness für das intrinsische Be dürfnis der eigenen Weiterentwicklung wie keine andere Sportart. Und genau
wie man im Fitnesstraining hin und wieder externe Reize benötigt, um sich selbst zu verbessern, so möchte ich mit dieser Artikelserie externe Reize setzen, an denen sich die Branche zur stetigen Weiterentwicklung orientieren kann. Viele Branchen machen sich die Prozesse aus anderen Industrien zu nutze, um selbst bessere Ergebnisse zu erzielen. Warum also nicht auch die deutsche Fitnessindustrie? Lassen
Sie uns über den Tellerrand schauen und sehen, was wir von Thalia lernen können.
Die Thalia Bücher GmbH ist eine deut sche Buchhandelskette, die durch den Zusammenschluss mit der Mayerschen Buchhandlung 2019 zur größ ten deutschen Buchhandelskette wurde. Ähnlich wie andere Anbieter
(Hugendubel etc.) auf dem deutschen Buchmarkt, hatte die Thalia Bücher GmbH im Geschäftsjahr 2013/2014 ein immenses Umsatzdefizit von 436,5 Millionen € (Thalia, 2021). Es gibt also Parallelen zur heutigen Situation der deutschen Fitnessbranche, die seit Pandemiebeginn eine negative Um satzdifferenz von 3,3 Milliarden € ver zeichnet (DSSV, 2022). Thalia hat es geschafft, trotz diverser Widrigkeiten diese Umsatzverluste zu kompensie ren, und hat sich innerhalb kürzester Zeit rehabilitiert.
Wie hat Thalia die Krise überwunden?
Der erste Schritt zu alter Stärke war die Einführung eines hauseigenen E-Book-Readers, dem Tolino Shine, noch bevor der deutsche E-BookMarkt boomt. Vor Einführung des To lino® war der Marktanteil von E-Books (ausgenommen Schul- und Fachbü cher) bei gerade einmal 0,5 % (2010). Im Jahr 2013 stieg dieser schon auf 3,9 % an (GfK, 2022). In den USA war der E-Book-Anteil auf dem Buchmarkt des Jahres 2012 schon bei 23 % (Associ ation of American Publishers, 2013). Man erkannte also bei Thalia früh eine Möglichkeit, um die Umsatzerlöse vom reinen Offlinegeschäft zu entkoppeln.

Um sich vom Offlinegeschäft unab hängiger zu machen, setzt Thalia auf
eine starke Präsenz im Onlinebuch handel. Die Fusion mit der Mayerschen Buchhandlung sowie die Ausrichtung auf E-Commerce ermöglichen es Thalia, Umsätze auf dem deutschen Buchmarkt zu erzielen, die sich auf einem Level mit den Umsätzen von Amazon bewegen (Thalia, 2021).
Thalia hat als klassische Buchhand lung mit allen Widrigkeiten des Einzel handels zu kämpfen. Die Innenstädte sterben langsam aus, das Konsumver
bisher hat es Thalia allen Widrigkeiten zum Trotz geschafft, auf einem hart umkämpften Markt zu wachsen.
Was hat das mit Fitness zu tun? Die deutsche Fitnessbranche befindet sich seit Beginn der Pandemie in ei ner Art schwebendem Dauerzustand. Man plant inzwischen zwar wieder optimistisch voraus, die aktuelle wirt schaftliche Situation ist bei 68,5 % der deutschen Studios aber mit „eher schlecht“ oder „schlecht“ bewertet
Der erste Schritt zu alter Stärke für Thalia war die Einführung eines haus eigenen E-Book-Readers, vor dem Boom des eBook-Marktes
halten der Kunden verlagert sich mehr und mehr ins E-Commerce-Geschäft. Die Informations- und Entertainment vielfalt sorgt außerdem dafür, dass die durchschnittliche Lesedauer pro Tag sich konstant verringert (Seven.One Media GmbH, 2021). Und dennoch hat es Thalia geschafft, als einziger deut scher Buchhandel einen Umsatz von 1,2 Milliarden € im Jahr 2020 zu erwirt schaften (buchreport, 2021). Wie sich Thalia in der aktuellen Papierknapp heit verhält und wie sich diese auf die Umsätze des Buchgiganten auswirken wird, muss die Zukunft zeigen, doch
(DSSV, 2022). Die Branche gibt sich optimistisch und kämpferisch, plant in den nächsten 18 Monaten wieder zu alter Stärke gefunden zu haben und die Mitgliederniveaus aus 2019 wieder erreicht zu haben (DSSV, 2022). Und doch können wir von Thalia eine Men ge lernen.
So bewies Thalia im Jahr 2013 mit dem Tolino Weitsicht und erkannte den Trend hin zum E-Book sehr früh. Trends auf dem deutschen Fitnessmarkt kom men der Erfahrung nach aus den USA. Dort sind die Konzepte, welche bei uns
Das Schaffen von digitalen Ökosystemen wird ein immer wichtigerer Faktor, wenn es um die Kundenbindung geht
den Markt erobern, meist schon Jahre im Voraus entwickelt und erprobt. Ich möchte hiermit nicht zu Plagiarismus aufrufen. Vielmehr möchte ich an die Weitsichtigkeit der Fitnessstudiobetrei ber appellieren. Sich selbst und das eigene Konzept stetig zu hinterfragen, dauerhaft auf der Suche nach der bes ten Lösung für die eigene, sich über die Jahre eventuell verändernde Zielgrup pe zu sein, das ist die Art von Weitsicht, von der ich spreche.
Von der Theorie in die Praxis Um diese Ideen in den Alltag zu inte grieren, sollten Sie sich als Betreiber folgende Fragen stellen:
• Welche Fitnesskonzepte erobern in anderen Ländern gerade den Markt?
• Was wirkt wie ein Trend, der sich so schnell verabschiedet, wie er gekommen ist?
• Kann ich mich als Betreiber international vernetzen und im Austausch mit meinen Kolle gen funktionierende Konzepte implementieren?
• Wie verändern sich die Bedürf nisse meiner Zielgruppe gerade?
Damit diese Fragen sowohl gestellt als auch ehrlich beantwortet werden können, gilt es natürlich, die eigene Marktposition, die eigene Zielgruppe
kongress der dba-Baunatal sprach Prof. Dr. Matthias Obinger über die Veränderung des Sporttreibens. So sind laut Obinger der urbane und länd liche Raum inzwischen allumfassend zu Sportstätten geworden und die Be völkerung entwickelt sich immer wei
sowie deren Bedürfnisse zu kennen. Schaut man sich die globalen Trends der Branche an, so sieht man, dass die Individualisierung überall vor herrscht und Sportbegeisterte zu je der Zeit und überall in der Lage sein wollen, Sport treiben zu können. Kaum jemand lässt sich noch mit Workouts von der Stange hinterm Ofen hervor locken, bei denen er an die Maschinen und Geräte im Studio gebunden ist. In einem Vortrag auf dem zweiten Sport
ter von organisierten Sportarten und Sportzentren weg. Die Möglichkeit, über Datenanalyse und eine digitale Bedarfsanalyse auf den Kunden zuge schnittene Trainings- und Ernährungs pläne anzubieten, die hybrid sowohl im Studio als auch im Homeoffice oder auf Dienstreisen funktionieren, werden langfristig immer mehr an Bedeutung gewinnen. Auch das Schaffen von digitalen Ökosystemen wird ein immer wichtigerer Faktor, wenn es um die

Sich selbst und das eigene Konzept ständig zu hinterfragen zeugt von Weitsicht
Kundenbindung geht: Anbieter wie beispielsweise Wefitter.com ermög lichen das Verknüpfen von verschie denen digitalen Fitnessapps wie MyFitnessPAL, Fitbit, Apple Health, Garmin oder Polar auf einer Plattform und helfen so dabei, die Nutzer platt formübergreifend zu motivieren. Als Studio hat man durch solche Ökosys teme die Möglichkeit, weiterhin als „Epizentrum des Sports“ zu fungie ren und alle relevanten Daten bei sich zusammenlaufen zu lassen. Hat man diese Kundendaten vorliegen und weiß sie richtig auszuwerten und zu steuern, bleibt man für eine erfolgreiche Trai ningssteuerung des Kunden unerläss lich und hat mehr Kontaktpunkte im täglichen Leben des Mitglieds mit dem Studio. Hierfür ist neben dem Wis sen um die Daten vor allem eine hohe fachliche Kompetenz der Mitarbeiter alles entscheidend. Als leuchtendes Beispiel für eine gelungene Individua lisierung im Fitnessstudio ist 24 Hour Fitness zu nennen. Das kalifornische Unternehmen bietet eine studioeigene App an, in der dem Mitglied persona lisiert Blogartikel, News, Anleitungen und digitale Workouts zur Verfügung gestellt werden. Diese werden anhand der Präferenzen und des zeitlichen Ver fügungsrahmens des Mitglieds erstellt und automatisiert zugewiesen. Die Studiosoftware ABC-Fitness hat mit dem Kauf von Trainerize eine Integra tion von Ernährungsplänen und Daten aus Personal Trainings mit Klienten in das Studio-CRM eingefügt und bietet so die Möglichkeit, die Trainingssteu erung, Terminvergabe, Abrechnung, Mitgliederverwaltung und Ernährungs planung in einer Software zu bedie nen. Für tiefergreifende Informationen zu den Themen digitale Touchpoints, Individualisierung und das Schaffen digitaler Ökosysteme habe ich im Keep Your Members Podcast mit Paul Peez von der Fittech Company ausführlich besprochen.



















Wir sehen auf dem globalen Markt eine Vielzahl an Trends auf uns zukom men. Wir sehen auch, dass es sich für Unternehmen in einer schwierigen Marktsituation lohnen kann, Partner schaften und Kooperationen einzu gehen und diese zu pflegen. Ähnlich wie es Thalia auf dem Buchmarkt geschafft hat, trotz sinkenden Buch














absatzes den Umsatz zu verbes sern, gibt es auf dem Fitnessmarkt Möglichkeiten der besseren Kun denbetreuung. Schaut man auf den innovationstreibenden Markt in Nord amerika, sieht man, dass vor allem die Themen Individualisierung und Integration vorherrschen. Diese gilt es an die lokalen Bedürfnisse der einzel nen Zielgruppe anzupassen und ins Fitnessstudiokonzept zu integrieren.

Quellen:








Association of American Publishers. (05. 13 2013). eBooks Account for 23% of U.S. Publisher Sales in 2012. Abgerufen am 7. Juli 2022 von Statista: https://www.statista.com/chart/1091/ ebook-sales-in-the-us
dibdib. (2022). Branchennews. Von dibdib: https://www.dibdib.de/branchennews/gesund heit-braucht-fitness/ abgerufen DSSV. (17. 3 2022). Wirtschaftliche Situation ange spannt. Eckdaten der deutschen Fitnesswirtschaft 2022, S. 9.
GfK. (22. 3 2022). GfK Consumer Panel Media*S cope Buch). Deutschland. Thalia. (16. 11 2021). Statista. Von Hobby und Freizeit: https://de.statista.com/statistik/daten/ studie/172480/umfrage/umsatz-der-thalia-gruppein-deutschland-seit-2004
buchreport. (1. April, 2021). Umsatz der Thalia Gruppe in Deutschland in den Geschäftsjahren 2004/05 bis 2019/20 (in Millionen Euro) [Graph]. In Statista. Zugriff am 8. April 2022, https://de.statis ta.com/statistik/daten/studie/172480/umfrage/um satz-der-thalia-gruppe-in-deutschland-seit-2004

Seven.One Media GmbH (Ein Unternehmen der ProSiebenSat.1 Media SE). (20. Oktober, 2021). Durchschnittliche tägliche Nutzungsdauer ausge wählter Medien in Deutschland in den Jahren 2014 bis 2021 (in Minuten) [Graph]. In Statista. Zugriff am 8. April 2022, von https://de.statista.com/sta tistik/daten/studie/992180/umfrage/taegliche-nut zungsdauer-von-medien-in-deutschland
ABC Fitness: https://abcfitness.com/ press-release/abc-financial-acquires-trainerize


Nutzen Sie unsere fertig getränkten Desinfektionstücher in formschönen und praktischen Spendersystemen, die speziell für den Bedarf von Fitnessstudios und Rehazentren entwickelt wurden. Sie sind perfekt geeignet zur Desinfektion von Flächen und Geräten.






wet wipes günstiger im Verbrauch wet wipes bessere Wirkung wet wipeskein Sprühnebel wet wipes einfache Handhabung wet wipes ® Umweltfreundlich (keine Kunststo zusätze) wet wipes Wirksam gegen Covid (begrenzt viruzid)










Till Pitschel ist Experte für Fluktua tionsmanagement und Kundenbin dungsprozesse, Autor, Speaker und Personal Trainer. Gemeinsam mit zwei Partnern leitet er das Start-up „Keep Your Members“, um Studioverantwort lichen umfassend zu Fluktuationspro zessen und Kundenbindungsstrategi en zu beraten. Nähere Informationen auf: www.kym-solutions.de



SLED PUSH

FREE RUN
Simuliert durch regulierbaren Widerstand das schlittentraining mit der freiheit, ihr eigenes tempo und intensität nach belieben Machen Sie sich einen Eindruck





Burnout – ausgebrannt sein. Das englische Wort beschreibt es ziemlich gut, denn Men schen mit einem Burnout fühlen sich genau so: Sie haben keine Energie mehr, um auch nur die kleinsten Dinge im Alltag zu erledigen. Für Unternehmer, die auch für ihr Unternehmer brennen, ist das natürlich der Super-GAU. Daher heißt es, genau diesem Fall vorzubeugen, um den nachhaltigen Unternehmenserfolg zu sichern.

Das Gefühl der Antriebslosigkeit und Erschöpfung umfasst alle Lebensberei che und kann einem den Spaß an allen bisherigen positiven Aktivitäten neh men. Der Austausch mit den Mitglie dern und Lieferanten, die Entwicklung kreativer Ideen für die Weiterentwick lung des Unternehmens und natürlich auch die Zeit mit der Familie. Und dann die endgültige Gewissheit, dass nichts mehr so sein wird wie zuvor. Der Weg ins alte Leben, wenn er denn überhaupt gelingt, ist von Anstrengungen und Hin dernissen gepflastert.
Irgendwie ist es allen klar: Unterneh mer sind überproportional von Burn-
out betroffen, was gleichzeitig das Unternehmen in Schieflage bringen kann. Doch warum trifft es vor allem sie und was kann man tun, um einem Burnout vorzubeugen?
Der Burnout kommt auf leisen Sohlen
Beginnen wir mal am Anfang: Was genau ist ein Burnout? Es ist ein Syn drom, das Folge einer längerfristigen (Arbeits-)Überbelastung ist. Ein Bur nout ist nicht von heute auf morgen plötzlich da, sondern entwickelt sich schleichend. Die ersten Anzeichen wie eine steigende Infektanfälligkeit, Schlafstörungen, Gewichtsverlust und
vermehrte Unruhe tun viele noch als Infekt oder kurzfristige Schwäche ab. Aber auch das Bewusstsein für sich selbst ändert sich: Man stumpft ab, das Schmerzempfinden nimmt ab und man nimmt sich selbst als eher fremd und nicht zugehörig war – das kann bis hin zu einer Depersonalisie rung gehen. In einer späteren Phase versucht man, dem Stress, den man spürt, mit Medikamenten oder ande ren Mitteln zu begegnen. Nicht selten verändert sich aber auch das Frei zeit- und Sozialverhalten, das mit einer steigenden Aggression einhergehen kann. Irgendwann zeigt der Körper einem seine Grenzen auf und knockt
Irgendwann zeigt der Körper uns seine Grenzen auf und knockt uns aus, doch dann ist es oftmals schon zu spät
Das wohl Wichtigste ist das bewusste Wahrnehmen der eigenen Grenzen, die einem der Körper setzt, und damit einhergehend eine gesunde Work-LifeBalance. Dazu gehört es, sich feste Arbeitszeiten zu setzen und nicht zu häufig bis spät in die Nacht zu arbeiten, die Arbeit nicht mit nach Hause zu neh men und mit Menschen zusammenzu arbeiten, denen man Arbeit auch mal abgeben kann, ohne Sorge haben zu müssen, dass man regelmäßig ein greifen muss. Aber dazu gehört auch, sich einzugestehen und zu akzeptieren,

und unrealistische Ziele setzt, fällt es schwerer, Feierabend zu machen, da man nie das Gefühl hat, etwas erreicht zu haben.
Einen
Ein weiteres Problem ist die Anforde rung, viele Dinge gleichzeitig erledigen zu müssen, da die Zeit knapp ist. Aber durch Multitasking wird die Ausschüt tung der Stresshormone Cortisol und Adrenalin angekurbelt, was auf Dau er gesundheitsschädigend sein kann. Darum gilt es, sich für jede Aufgabe gebührend Zeit zu nehmen und nicht
geht oder ob man Yoga macht. Ein letzter, aber wichtiger Punkt ist, dass man nett und achtsam mit sich selbst umgeht. Es ist normal und okay, wenn man Fehler macht, es ist auch okay, wenn einem mal alles zu viel ist, wenn man früher Feierabend macht oder wenn man krank ist. Alles kein Welt untergang. Wirklich schlimm wäre es, wenn man all das ignoriert und einfach immer weiter über die Erschöpfung hi naus arbeitet, denn dann schadet das nicht nur einem selbst, sondern auch dem Unternehmen.
Fazit
wenn man krank ist und sich dann ent sprechend zu erholen. Und das heißt auch nicht, vom Bett aus zu arbeiten oder sich an den Schreibtisch zu Hau se zu quälen, sondern sich auszukurie ren, bis man wirklich wieder gesund ist. Dann ist man auch viel leistungsfähiger.
Meist hat man genaue Vorstellungen, was man mit seinem Unternehmen erreichen möchte, und das sind Ziele, die das Ergebnis langer Arbeit sind –keine, die man mal eben morgen er reicht. Das ist wichtig, denn man muss sich realistische Ziele setzen und den Berg nach und nach erklimmen. Wenn man sich zu viel auf einmal vornimmt
während eines Meetings noch schnell E-Mails zu beantworten oder Angebo te zu checken.
Wie bereits erwähnt, ist es wichtig, dass die Arbeit nicht das Leben be stimmt, sondern dass man einen Aus gleich schafft. Vor allem ein körper licher Ausgleich zu dem meist vielen Sitzen ist wichtig, denn durch das viele Sitzen am Arbeitsplatz treten bei vielen Menschen Schmerzen im Rücken und Nacken auf. Dem kann durch Sport leicht entgegengesteuert werden und gleichzeitig kann man den Kopf frei bekommen. Und hier ist es ganz egal, ob man ins Fitnessstudio oder joggen
Viele Unternehmer und Führungskräf te befinden sich in dem Dilemma, dass das Unternehmen sie braucht, aber man irgendwann nicht mehr kann. Hier steht und fällt es mit der Entscheidung, ob man so weitermacht oder etwas an dem Verhaltensmuster ändert. Ein Burnout ist meist die Folge und das liegt nicht daran, dass das Bewusst sein fehlt, sondern daran, dass dem nicht vorgebeugt wird. Dabei haben Unternehmer eigentlich keine Zeit für einen Burnout – und für die meist lange Regenerationszeit danach erst recht nicht. Und genau deswegen ist es wichtig, nicht einfach durch die Er schöpfung durchzuarbeiten, sondern eine gesunde Work-Life-Balance zu leben, um einen langfristigen Unter nehmenserfolg zu ermöglichen. Bur nouts dürfen nichts Gegebenes sein im Unternehmertum.
Für viele Unternehmer gehört ein burnoutförderliches Verhalten zum Alltag dazu


Nach wie vor kämpfen Fitnessstudios um jeden Kunden. Aufgrund der massiven Coronaeinbußen und des zunehmenden Verdrängungswettbewerbs haben viele Betreiber lange Vertragslaufzeiten durch monatlich kündbare Verträge ersetzt und verkaufen sich und ihre Dienstleistung zusätzlich unter Wert. Diese Entwicklung ist auf Dauer nicht gesund und kann gestoppt werden; denn bereits vor der Pandemie hat sich deutlich gezeigt, dass der Fokus in allen Lebensbereichen auf Gesundheit liegt. Immer mehr Menschen interessieren sich für aktuelle Trends und Themen aus dem Bereich Gesundheit und suchen nach ver trauenswürdigen Experten.

Gemeinsam mit meiner Familie be treibe ich seit ca. 30 Jahren sieben eigene Fitnessclubs im Remstal bei Stuttgart. Diese Gesundheitsanlagen kämpfen mit den gleichen Problemen und die genannten Pain Paints sind hinlänglich bekannt. Auch in unse ren Anlagen waren u. a. die Nebenumsätze mit Eiweißpulver und Riegeln lange Zeit kein relevanter Pro-KopfUmsatz und trugen somit auch nicht zu einer Verbesserung der Situation bei. Zum einen gab es keine inter nen Prozesse und kein attraktives Angebot, um die Produkte besser zu platzieren, und zum anderen fehlte speziell den Mitarbeitern die Sinnhaf tigkeit, ein Upselling beim Kunden zu platzieren.
So macht Upselling nicht nur Sinn, sondern auch Spaß Zielgruppenanalyse: Wer eine Stei gerung seiner Nebenumsätze plant, muss zuerst verstehen, welche Pro bleme die Kunden haben und was ihnen dabei helfen könnte, ihre Ziele schneller zu erreichen. Zott Fitness führte eine aufwendige Analyse bei Neukunden durch, mit folgenden Erkenntnissen:
• 60 % klagten über Schlafprobleme / schlechter Schlaf
• 45 % hatten Verdauungsprobleme
• 40 % litten an Entzündungen
Bei den meisten (Neu-)Kunden stellte sich zudem heraus, dass zu Beginn der Mitgliedschaft eine völlige Unter versorgung mit Nährstoffen vorlag. All diese Probleme führten dazu, dass das Training nicht seine volle Wirkung entfalten konnte; denn die Unterver sorgung wurde nicht aktiv angespro chen bzw. es wurde keine Lösung vorgestellt.
Problemlösung: Superfoods zur Man gelbeseitigung: Superfoods, d. h. Lebensmittel aus dem Bereich Obst und Gemüse, die besonders reich an Vitaminen, Mineralstoffen und Anti oxidantien sind, liegen voll im Trend. Mit Jungbrunnen Superfoods entwi ckelte ich eine Produktpalette, die all diese positiven Eigenschaften bein haltet und somit eine Lösung für die Probleme der Zielgruppe bietet. Doch ohne Wirksamkeitsnachweise würden die Trainer und das Zott Team auch Superfoods nicht besser verkaufen. Aus diesem Grund wurde eine Zu sammenarbeit mit InBody vereinbart. Ziel war es, die Wirksamkeit und den Zusammenhang von Training und Nährstoffversorgung mithilfe von Kör permessungen nachweisen zu kön nen und somit nicht nur den Kun den, sondern auch die Mitarbeiter zu überzeugen.
Die Datenerhebung
Ausgangslage: Insgesamt 200 Neu kunden wurden in den drei Premiumanlagen in zwei Testgruppen mit je weils 100 Teilnehmern geclustert. Ei ner Gruppe wurden zusätzlich zum Training unterstützende Superfoods für den täglichen Gebrauch verab reicht und die andere Gruppe trainierte ohne diese Unterstützung 1- bis 2-mal pro Woche. Bei jedem Trainierenden wurde vor Beginn des ersten Trainings und nach 6 Wochen eine Körpermessung durchgeführt und die Ergebnisse festgehalten und verglichen. Dabei wurde explizit auf zwei Messergebnisse, den Phasenwinkel und das Viszeralfett, geachtet.
Der Phasenwinkel ist ein wichtiger Indikator für die Zellgesundheit und kann der Einschätzung des Gesund heits- und Ernährungszustandes die nen. Je größer der Phasenwinkel ist, desto widerstandsfähiger und gesün der sind die Zellmembranen. Das be
deutet, ein möglichst guter Stoffaus tausch über die Zellmembranen kann gewährleistet werden.
Das Viszeralfett, bekannt als inne res Bauchfett oder auch Organfett, ist ein Risikofaktor für ernsthafte Er krankungen, wie etwa Herz-KreislaufErkrankungen sowie Stoffwechselerkrankungen.
Die Testgruppe mit Superfood-Unterstützung hat sowohl in Bezug auf die Verbesserung des Phasenwinkels als auch des Viszeralfetts deutlich besser abgeschnitten als die Vergleichsgruppe, bei der die Unterversorgung nicht aktiv beeinflusst wurde.
• 10 % aller Teilnehmer mit Super food-Unterstützung erzielten eine zweistellig prozentuale Verbesse rung des Phasenwinkels.
• Der Höchstwert lag bei 21 %.
• Im Schnitt wurde der Phasenwinkel in dieser kurzen Zeit um 4 % verbessert.
• Bei der Gruppe ohne Superfoods hatte das Training fast keinen Einfluss auf diesen Parameter.
• Ein Viertel aller Teilnehmer mit Superfood-Unterstützung erzielte eine zweistellig prozentuale Verbesserung des Viszeralfetts, d. h. eine deutliche Reduktion.
• Der Höchstwert lag bei 70 %.
• Im Schnitt wurde das Viszeralfett in dieser kurzen Zeit um -6 % verringert.
• Bei der Gruppe ohne Superfoods hatte das Training einen deutlich geringeren Einfluss (- 3 %) auf die Reduktion des Viszeralfetts.
Die Datenerhebung hat den vermute ten Zusammenhang zwischen Nähr stoffversorgung und Training nachwei sen können und zeigt auf, wie wichtig dieses Thema für den Trainingserfolg sein kann. Diese Messergebnisse überzeugen nicht nur Kunden, son dern auch das Team.
Superfoods als massiver Umsatzbooster
Nach der Auswertung und dem Nach weis der Wirksamkeit der Superfoods wurde das gesamte Team von den Ergebnissen in Kenntnis gesetzt. Da nach wurde der Prozess der Imple
mentierung von Superfoods bei Kun dengesprächen ausgearbeitet und gemeinsame Ziele wurden definiert. Seither wird die Körpermessung in jedem Neukundentermin integriert und besonders der Phasenwinkel und das Viszeralfett werden angespro chen und bewertet. Durch den stetig optimierten Gesprächsverlauf für die Ansprache der Superfoods konnte bei Zott der Nebenumsatz nur mit Super foods um 1.000 % gesteigert werden. Von den Superfoods profitiert so wohl das Team durch Provisionierung und Teamevents bei Zielerreichung, der Kunde durch noch bessere Trai ningserfolge, als auch der Unterneh mer durch gesteigerten Umsatz und Weiterempfehlung.
Superfoods – so einfach wie natürlich im Upselling
Die Messung der Körperzusammen setzung ist mittlerweile für fast alle Betreiber ein fester Bestandteil der Customer Journey eines Kunden. Und es war noch nie so einfach wie mit Superfoods, die Messungen für alle Beteiligten zu einer Win-Win-Situation zu machen. Die Zielgruppenanalyse und der nachgewiesen positive Ein fluss begleitender Nahrungsergänzung schlägt zwei Fliegen mit einer Klappe:
1. Studiobetreiber verschaffen sich Zugang zu einer neuen, viel größeren Zielgruppe, die bislang nicht im Fokus stand.
2. Außerdem wird diese neue Zielgruppe viel besser verstanden und man kann auf ihre Probleme eingehen. Ziele werden somit für beide Seiten leichter zu erreichen.
Nadine Zott ist CEO bei Performing Systems und betreibt selbst, im Remstal bei Stuttgart, sieben eigene Premium-Fitnessclubs im Familienbetrieb. Nadine Zott hat die Superfoodmarke Jungbrunnen gegründet. www.performing-systems.de

KUNDENBINDUNG, DIE FUNKTIONIERT: Auch nach Studio-Wiedereröffnungen nutzen aktuell 250.000+ PERSONEN* unser OnlineAngebot über ihr Fitness-Studio als Prämie für ihre Mitgliedschaftsverlängerung.






Am 25. Oktober fand die europäische Fitnesskonferenz FitNation im Eye Film Museum in Amsterdam statt. Bei der Konferenz trafen sich branchenführende Experten, um gemein sam mit den fast 300 Teilnehmern über die größten Innovationen und Herausforderungen der Fitnessbranche zu diskutieren und die wichtigsten Themen im Bereich Fitness und Gesundheit zu analysieren.

Die Kernbotschaft der Veranstaltung war, dass die globale Fitnessbranche sich mit anderen Branchen und Organisationen zusammenschließen muss, um ihre Position zu stärken und ein breiteres und ganzheitlicheres Ge sundheitsangebot schaffen zu können. Durch entsprechende Kooperationen sei es möglich, Mitglieder zu motivie ren und zu binden.
Welche Auswirkungen hat die Wirtschaftskrise auf die Fitnessbranche?
Die Veranstaltung in Amsterdam um fasste elf Keynote-Präsentationen und Workshops von renommierten internationalen Rednern, darunter der Fitnesstechnologie-Unternehmer Bryan O‘Rourke und die Ultratrail-Läuferin Anne-Marie Flammersfeld sowie Ex

perten von Unternehmen wie beispiels weise Virtuagym, EGYM und fit20. Die diskutierten Themen waren sehr vielseitig und reichten von der Rolle des E-Sports und Gamification für Fitness über zukünftige digitale Inno vationen im Gesundheitsbereich bis hin zu effektiven Wachstumsstrategien für Fitnessunternehmen und persönliche Leistungssteigerung.

In einer Podiumsdiskussion wurde zu dem über die Auswirkungen der glo balen Wirtschaftskrise auf die Fitness branche diskutiert. An der Diskussion nahmen mit Andreas Paulsen, CEO von EuropeActive, Patrick Rijnbeek, Direktor von NL Actief, Wellnessexper tin Jennifer Halsall-De Wit und Stefan Blahovec, Gründer von Form Factory, teil. Moderiert wurde die Diskussions runde vom Ernährungswissenschaftler und Autor Dr. Ludidi.
Laut Andreas Paulsen hat die Fitness branche bewiesen, wie wichtig sie für unsere Gesundheit im Allgemeinen und nicht nur für die Freizeit ist. Was sich darin zeigt, dass sie von vielen Regierungen seit 2021 als wesentli che Dienstleistung angesehen wird. Für Paulsen bietet der Aufbau von Strategien zwischen den Verbänden eine echte Chance, Fitnessclubs im Leben vieler Menschen zu etablieren, damit diese dort etwas für ihre kör perliche Gesundheit und ihr geistiges Wohlbefinden tun können. Dies kann z. B. durch bessere Konnektivität und digitale Strategien geschehen. Laut Patrick Rijnbeek bedeutet dies, dass die Branche Gesundheit und Fitness für Menschen zugänglicher machen kann, denen es nicht leichtfällt, in ein Fitnessstudio zu gehen oder regelmä ßig zu trainieren, wie etwa Menschen mit Behinderungen. Die Branche sollte sich mit Verbänden zusammenschlie ßen, die diese Bevölkerungsgruppen unterstützen.
Die rund 300 Teilnehmer der diesjährigen FitNation konnten an insgesamt elf spannenden Keynote-Präsentationen und Workshops teilnehmen
Bryan O‘Rourke betonte, wie wichtig es sei, dass eine Fitnessmarke Teil ei nes umfassenderen Ökosystems von Gemeinschaft und Inhalten ist, das die menschliche Erfahrung verbessert. Wobei die modernen Verbraucher die Produzenten seien. Für ihn ist eine in telligente Kommunikation und Zusam menarbeit zwischen Unternehmen und Ländern entscheidend für die nächste Stufe von Fitness und Gesundheit. Für Jennifer Halsall-De Wit liegt der Schlüssel für die künftige Gesundheit der Branche darin, dass Unternehmen und Organisationen zusammenarbei

ten und Synergien mit verschiedenen Diensten schaffen, um eine umfassen dere Gesundheitslösung zu bieten, die die spezifischen Kundenbedürfnisse versteht und weniger reaktiv ist.
Termin 2023 steht fest 2023 findet FitNation am 12. Oktober statt. Veranstaltungsort wird erneut das Eye Film Museum in Amster dam sein. FitNation 2022 wurde von EuropeActive und NL Actief unterstützt und von Virtuagym, Matrix, Hidden Profits Marketing, Mollie, InBody und ClubJoy gesponsert.


Ecorow Panatta ist ein Ruderergometer, das vollständig von Panatta-Technikern entworfen und in Italien in den Panatta-Werken sowie komplett in Italien hergestellt wird. Es simuliert das Rudern originalgetreu und wurde entwickelt, um Vibrationen im Vergleich zu klassi schen Rudergeräten und Auswirkungen auf den Lendenbereich, zu minimieren.
Dieses Rudergerät ist ideal für IndoorRuderübungen sowohl zu Hause als auch für den professionellen Einsatz im Fitnessstudio. Wie alle PanattaProdukte ist es so gebaut und kon zipiert, dass es möglich wenig Ver schleiß gibt und die Geräte lange haltbar sind. Außerdem ermöglicht es allen Trainierenden, in maximaler Sicherheit zu trainieren.

Das innovative Magnetsystem des Rudergeräts unterliegt keinem Ver schleiß und verbraucht keinen Strom. Der Widerstand gibt dem Benutzer ein sauberes und realistisches Ge fühl des Ruderns, da die Belastung immer proportional zur Intensität und Geschwindigkeit des Ruderns ist. Mit einem einfachen und schnellen Ein stellmechanismus auf 4 Ebenen kann man von einer agilen Ausführung zu einer mit zusätzlicher Belastung übergehen.
Die Mindestsitzhöhe von ca. 42 cm wurde speziell entwickelt, um die Ma schine auch für Benutzer mit einge schränkter Gelenkbeweglichkeit leicht zugänglich zu machen und gleichzeitig den Benutzer nicht zu weit vom Boden entfernt zu halten, um während der Ausführung der Übung keine Instabi lität zu erzeugen.
Die Proportionen der Maschine sowie die technischen Details ermöglichen es während der gesamten Bewegung eine physiologische Haltung einzu nehmen. Der Winkel der Fußrasten und der Griff ermöglichen maximale Sicherheit. Die Fußrasten sind mit ei nem einfachen und intuitiven System zum Einstellen der Fersenstütze aus gestattet, das sie für Benutzer in un terschiedlichen Fußlängen nutzbar macht.
Die Farbe der Maschine ist bis auf die Schiene und die Formteile vollständig anpassbar. Das Rudergerät ist mit Vor
derrädern für einen einfachen Trans port und einem Display ausgestattet, mit dem die folgenden Informationen angezeigt werden können: Zeit, Zeit für 500 m, Entfernung, Anzahl der Reihen, Kalorien, Leistung, Geschwindigkeit und Herzschlag (für die ein Pulsgurt erforderlich ist). Die Pulse RecoveryFunktion ist ebenfalls verfügbar, die die Herzerholungskapazität basierend auf der Abnahme des über eine Minute ge messenen Schlags testet. Das Display ist nicht optional, sondern wird immer mit der Maschine geliefert.
Panatta Srl
Via Madonna della Fonte 3/c 62021 – Apiro (MC) - Italy Tel. + 39 0733 / 611824
E-Mail: infode@panattasport.it Web: www.panattasport.com


Am 20. Oktober fanden im Düsseldorfer Classic Remise die diesjährigen BODYMEDIA Innovation Days statt. Neben den zahlreichen Innovationen und Trends war die Vergabe der BODYMEDIA Innovation Days Awards erneut ein weiteres Highlight der Veranstaltung.

Umgeben von Luxuslimousinen und edlen Oldtimern begrüßte Moderator Tobias Conrad, der wie gewohnt kompetent und unterhaltsam durch das Event führte, die Teilnehmer der BODYMEDIA Innovation Days. Diese freuten sich in einer außergewöhnli chen Location auf ein vielseitiges und spannendes Programm. Die Classic Remise Düsseldorf befindet sich in einem denkmalgeschützten Ringlok schuppen, der zwischen 1929 und 1931 erbaut und in den Jahren 2005 und 2006 liebevoll restauriert wurde. Zahlreiche historische und klassische Fahrzeuge, der offene Blick in die Service- und Restaurationswerkstätten und die Ausstellung kostbarer Oldtimer in den gläsernen Einstellboxen
in Verbindung mit aufregender an spruchsvoller Architektur aus ver schiedenen Epochen ermöglichten die BODYMEDIA Innovation Days in ein zigartiger Umgebung und Kulisse.
Bewährtes Erfolgskonzept Nach der Begrüßung richtete Gastge ber Nicolas Hessel, Geschäftsführer BODYMEDIA, noch einige Worte an die Teilnehmer, ehe das Programm startete. Das bewährte Eventkonzept, bei dem Fitnessclubbetreiber und Physiotherapeuten von der Industrie 25 Innovationen und Trends vorge stellt bekommen, kam auch in diesem Jahr sehr gut an. Neben insgesamt 15 zehnminütigen Speedvorträgen gab es zwei Runden mit Small-Group-

Pitches, die maßgeblich zur Dynamik des Events beitrugen. Insgesamt zehn Industrieunternehmen standen bei den Small-Group-Pitches vor der Herausforderung, ihr Unternehmen bzw. ihr Produkt in nur zwei Minuten vorzu stellen. Pro Runde, eine fand am Vor mittag und die andere am Nachmittag statt, wurden den Teilnehmern fünf Small-Group-Pitches präsentiert. So wurde sichergestellt, dass jeder Gast am Ende der BODYMEDIA Innovation Days die Möglichkeit hatte, jeden Pitch gesehen und gehört zu haben.
In den Pausen hatten die Teilnehmer nicht nur ausreichend Zeit, um sich bei leckerem Essen und Getränken zu stärken, sondern auch die Gelegen
Die Pausen wurden für das Netzwerken genutzt
heit, mit Branchenkollegen über das Gesehene und Gehörte zu diskutieren und zu netzwerken. Viele Betreiber tauschten sich zudem in den Pausen mit den Industrieunternehmen aus, um weitere, vertiefende Informationen zu den jeweiligen Produkten und Dienst leistungen zu erhalten.
Glückliche Gewinner
Ein Highlight der BODYMEDIA Inno vation Days war auch in diesem Jahr wieder, die mit Spannung erwartete Vergabe der BODYMEDIA Innovation Days Awards. Die Gäste konnten via Live-Abstimmung ganz einfach per QR-Code ihre Favoriten zum Sieger küren. Die BODYMEDIA Innovation Days Awards wurden erneut in den vier Kategorien „Bester Vortrag“, „Bester Small-Group-Pitch“, „Bestes Produkt“
und „Beste Innovation“ vergeben. Die Erstplatzierten erhielten die begehrte goldene Glühbirne von Nicolas Hessel überreicht. Die Gewinner und Platzier ten im Überblick:
Bester Vortrag
• Platz 1: Peter Hinojal, HOLD STRONG Fitness GmbH
• Platz 2: Stefan Weiffen, LES MILLS Germany GmbH
• Platz 3: Stefan Unterthor, THOR Training
Bester Small-Group-Pitch
• Platz 1: Eckhardt Santana, Santana Consulting GmbH

• Platz 1: Dr. Wolff Sports & Prevention GmbH
• Platz 2: LES MILLS Germany
• Platz 3: THOR Training & HOLD STRONG Fitness GmbH (punktgleich)
Beste Innovation
• Platz 1: HOLD STRONG Fitness GmbH
• Platz 2: LES MILLS Germany GmbH & & Dr. Wolff Sports & Prevention GmbH (punktgleich)
• Platz 2: Meike Reckers und Jürgen Schraml, CyberConcept GmbH
• Platz 3: Dominik Fogt, Heal11
Sobald die Termine und Orte für die BODYMEDIA Innovation Days 2023 feststehen, werden diese über die Fachmagazine und digitalen Kanäle von BODYMEDIA veröffentlicht. Bei











Oben:
Mitte: Peter Hinojal von Hold Strong (rechts) konnte sich gleich zwei Awards sichern. Er gewann in den Kategorien „Bester Vortrag“ und „Beste Innovation“




Unten links: Hartmut Wolff (links) freute sich über den Award in der Kategorie „Bestes Produkt“
Unten rechts: SANTANA-Geschäftsführer Eckhardt Santana (rechts) erhielt die Trophäe in der Kategorie „Bester Small-Group-Pitch“
Zu einem stimmungsgeladenen Fitnesskurs gehören ein Trainer, der begeistert, richtig guter Sound und eine motivierende Beleuchtung.
Sie haben den Trainer ‒wir haben die Technik!
Alle erforderlichen Handgriffe an der Musik- und Lichtanlage sollen für den Trainer selbsterklärend und easy aus zuführen sein, ohne dass lange Tech nikerschulungen nötig sind. Unsere Technik ist übersichtlich, anwender freundlich und trotzdem professionell und immer auf dem neuesten Stand.
Keep it simple + better – Aschenbach Audio Team hat im Laufe vieler Jahre das Design und die Funktionalität per fektioniert. Dies ist auch in unserem neuen Kursraumkonzept zu sehen. Er

zielen Sie mit unserer Beleuchtungs technik, wie z. B. den Pixeltubes, den Moving Heads oder den Bild- und Po destbeleuchtungen, die richtigen Ef fekte. Programmierte LED-Leuchten, die mit wenigen Knopfdrücken über Ihr Musik- und Lichtpult steuerbar sind, schaffen das richtige Ambiente und Erlebnis. Dazu sorgt unsere professio nelle Lautsprechertechnik für eine op timale Klangabstimmung sowie unsere Steuerungstechnik für eine einfache und schnelle Bedienung.
Aschenbach bietet alles, was das Trainerherz begehrt Um wirklich rundum versorgt und aus gestattet zu sein, bietet unser Aschen bach Pult New Style, ausgestattet mit einer Funkmikrofonanlage, einem Bluetooth-Verbindungsgerät, einem Wireless Charger für Ihre Endgeräte sowie professioneller Beschallungs technik, alles, was das Trainerherz
begehrt und was man für einen stim mungsgeladenen Fitnesskurs braucht. Abgestimmt auf Ihre Bedürfnisse er stellen wir Ihnen gerne ein individuelles Angebot und kommen auch zu einem unverbindlichen und kostenfreien Ter min zu Ihnen ins Studio. Beleuchtung und Sound schaffen Ambiente und Er lebnis. Überraschen Sie Ihre Mitglieder mit einem WOW-Effekt.

Aschenbach Audio Team GmbH & Co KG
Industriestraße 26 24536 Neumünster
Tel. +49 (0) 4321 / 959800 E-Mail: mail@aschenbach.com Web: www.aschenbach.com

Ein Produkt alleine schafft keine Emotionen. Fühlen, sehen und umsetzen.
Trainingswelten realisieren, die schon beim Betreten des Raumes Gänsehaut schaffen ist, unsere Expertise.
Von der Baustellenbesichtigung bis zur Auslieferung. Von veralteten Trainingsflächen bis hin zum neuen „GYM im GYM“.



Vereinbare einen unverbindlichen Termin mit unserem Sales Team.
Kontaktiere info@holdstrong.de

Am 11. Oktober fand im QX Manor in Frankfurt der Technogym Innovation Outlook statt. Die rund 50 geladenen Gäste, darunter Fitnessstudiobetreiber und Physiotherapeuten, hat ten die Möglichkeit, die neuesten Innovationen zu testen, und bekamen in Impulsvorträgen hilfreiche Tipps und Anregungen für ihr Business.
Das QX Manor ist eine Villa, die als Eventlocation genutzt wird. Hier finden z. B. Aufsichtsratssitzungen, ReleasePartys und Netzwerkveranstaltungen statt. Nachdem Andreas Mayer, Ge schäftsführer Technogym Deutsch land, seine Gäste begrüßt hatte, gab er einen Überblick, welch zahlreiche Innovationen Technogym in der knapp 40-jährigen Unternehmensgeschichte entwickelt und auf den Markt gebracht hat. Damals wie heute, so Andreas Mayer, sei es das Ziel aller Innovatio
nen gewesen, Menschen dabei zu hel fen, besser leben zu können. Bei ak tuellen Innovationen wie zum Beispiel Biostrength soll künstliche Intelligenz dabei helfen, das Krafttraining auf die nächste Stufe zu heben.
Die Gäste bekamen in kurzweiligen Vorträgen sowohl von TechnogymMitarbeitern als auch externen Speakern spannende Impuls vermittelt. Hierfür wurden die Gäste in zwei
Gruppen, Fitnessstudiobetreiber und Physiotherapeuten, eingeteilt. Eines hatten alle Vorträge gemeinsam: Sie beschäftigten sich mit der Frage, wie die Zukunft aussieht.
Markus Appelt von Performing Systems befasste sich in seinem Vortrag da mit, welche Auswirkungen die zuneh mende Tätigkeit im Homeoffice für Studiokunden hat, wie Digitalisierung die persönliche Dienstleistung sinn voll unterstützen kann. Auch auf das
Oben: Isabell Winkhardt von der BODYMEDIA mit Technogym Deutschland Geschäftsführer Andreas Mayer

Rechts: Im Fokus des Events lag die Biostrength-Linie, die die Gäste vor Ort testen konnten
so wichtige Thema Personalrecrui ting ging Markus Appelt ein. Er zeigte auf, welche Fehler Fitnessstudios bei der Mitarbeitersuche derzeit häufig begehen und wie sie dies zukünftig besser lösen können. Sascha Peter von Technogym verdeutlichte anhand von Mywellness, wie Studiobetrei ber das Trainingserlebnis optimieren und Mitglieder langfristig binden kön nen. Dabei ging er darauf ein, wie der Club der Zukunft und entspre chende Mitgliedschaftsmodelle aus sehen können, um Up- und CrossSelling erhöhen zu können. Christian Schröder veranschaulichte, welche Möglichkeiten der BIOSTRENGTHZirkel Fitnessclubbetreibern bietet. Anschließend hatten die Gäste die

Möglichkeit, Fragen zu stellen und die einzelnen Geräte des Zirkels zu testen. Zu den weiteren Technogym-Referen ten zählte Felix Osterbrink, der die ide ale Customer Journey im Reha- und Gesundheitssport nachzeichnete.
Zu den externen Speakern zählte neben Markus Appelt u. a. auch Eck hardt Santana von Santana Consul ting. In seinem Vortrag verdeutlichte er, warum es so wichtig ist, dass Fitnessstudios Wert schaffen und den Kaufprozess vereinfachen. Dies erklärte er anhand der Beispiele von Netflix und DAZN. Zudem machte er darauf aufmerksam, dass Fitnessclubs ihren Fokus stärker auf Bestandskunden richten sollen, wie sie es schaffen,
ihre Werbung effizienter zu gestal ten, und dass es wichtigere Parame ter als die Mitgliederzahl gibt. Zu den weiteren Referenten zählten außer dem Jasper Frederiks von Crown Consultancy und Niklas Arnold von RehaVitalisPlus e. V.
Zwischen den Vorträgen hatten die Gäste immer wieder die Möglichkeit, angeleitet von Technogym MasterTrainern die Trainingsgeräte auszu probieren und Fragen zu stellen. Abgerundet wurde das gelungene, exklusive Event am Abend durch ein Get-together. Bei leckerem Essen und Getränken tauschten sich die Gäste zu Branchenthemen aus.

Am 7. und 8. Oktober 2022 fand, nach zwei Jahren „online only“, im Mannheimer m:con Congress Center Rosengarten der Aufstiegskongress 2022 statt. Die Veranstalter – die Deutsche Hochschule für Prävention und Gesundheitsmanagement (DHfPG), die BSAAkademie und die BSA-Zert – präsentierten unter dem Motto „Better & stronger“ ein abwechslungsreiches Programm, das die Relevanz der Branche als Gesundheitsdienst leisterin noch einmal mehr deutlich machte.
Nach zwei coronabedingten „online only“-Ausgaben war das so wichtige Netzwerken wieder live erlebbar. Das genossen die rund 600 Teilnehmer gleichermaßen wie die Partner des Aufstiegskongresses, die zu großen Teilen bereits ihre Anwesenheit im nächsten Jahr ankündigten.
Die renommierten Redner widmeten sich bedeutungsvollen Fragestellun gen der Branche und boten in ihren Fachvorträgen sowie Gesprächsrun den wertvolle Hinweise aus der Praxis für die Praxis. Von Managementanre gungen über Marketingtipps bis hin zu aktuellsten Empfehlungen zur Trai ningsgestaltung gelang es den Veran staltern, für jeden Interessenschwer punkt Programmhighlights zu liefern.
Emotionaler Höhepunkt war der Auf tritt des Keynote Speakers Samuel Koch zum Abschluss des ersten Kon gresstages. Der seit einem Unfall in der TV-Show „Wetten, dass ...?“ vom Hals abwärts gelähmte Speaker, Autor und Schauspieler verkörpert wie kein anderer das diesjährige Kongress motto. In seinem packenden Vortrag „Schwerelos – wie wir Ballast abwer fen und Kraft tanken“ teilte er seine Einsichten und Erkenntnisse, was das tief beeindruckte Publikum mit begeis tertem Applaus dankte.
Idealer Rahmen zum fachlichen Austausch
Neben den spannenden Vorträgen bil dete die Partnerausstellung einen we sentlichen Bestandteil des Aufstiegs kongresses. Dort konnten sich die
Teilnehmenden über Trends und Inno vationen informieren und mit anderen Branchenangehörigen austauschen. Um mit den renommierten Branchenexperten über die wissenschaftlichen Erkenntnisse und die daraus abgelei teten nützlichen Anregungen aus ihren Vorträgen zu sprechen, bot die Speakers Corner den idealen Rahmen. Auch das Get-together am ersten Kongresstag sowie die KongressLounge wurden von den Besu chern gern genutzt, um mit „alten Bekannten“ aus der Branche wieder ins Gespräch zu kommen oder neue Kontakte zu knüpfen und zu vertiefen.
Interessenten können sich bereits jetzt den Termin für 2023 vormerken. Dann findet der Aufstiegskongress am 6. und 7. Oktober statt.

Emotionaler Höhepunkt war der Auftritt des Keynote Speakers Samuel Koch (Bild links) zum Abschluss des ersten Kongresstages. Der Vortrag des seit einem Unfall in der TV-Show „Wetten, dass ...?“ vom Hals abwärts gelähmten Speakers, Autor und Schauspieler lautete „Schwerelos –wie wir Ballast abwerfen und Kraft tanken“




Bremen, Wiesbaden, Leipzig und Stuttgart – das waren die Stationen der myline-Livetour. Beim zweiten Termin der Tour, der am 30. September im Wiesbadener Pentahotel statt fand, war auch BODYMEDIA mit von der Partie.

Neben der Vorstellung zahlreicher myline-Innovationen erwartete die rund 80 Teilnehmer ein spannendes Vor tragsprogramm mit wertvollen Praxistipps. Die Themen Neukundengewin nung, Mitarbeiter, Preisanpassung der Mitgliedsbeiträge und Einsparung von Energiekosten standen dabei im Mittelpunkt.
Als eine der Neuheiten wurde der Wer bemittelkatalog 2023 präsentiert. Der 40 Seiten umfassende Katalog, der auch digital erhältlich ist, enthält zahlrei che echte Erfolgsgeschichten. Der Ka
talog soll Studios dabei unterstützen, sich zukünftig noch besser positio nieren zu können. Zudem wurde den Teilnehmern die Januarkampagne „Wenn’s mal wieder so weit ist!“ für myintense+ und myline intense vorge stellt. Ziel des myintense+-Programms ist es, Kunden dabei zu helfen, 4 kg abzunehmen. Das Programm wird bis zu 100 % von den Krankenkassen bezuschusst. Beim myline-intenseProgramm ist ein Abnehmerfolg von 8 kg und mehr möglich. Zur Kampagne gehört ein umfassendes Paket an Wer bematerialien im neuen Design, die sowohl im Studio als auch online ge nutzt werden können. Ebenfalls neu ist
der Werbemittelkatalog mit „Naschen erlaubt Produkten“, der in Zusammenarbeit mit Inko entstanden ist. Teil des Katalogs sind u. a. auch das neue Schoko-Bananen-Müsli und der neue Riegel Banane-Schokolade mit 20 % Protein und nur 5,6 Gramm Fett. mylineGeschäftsführer Alexander Dillmann zeigte anhand eines Theken-Aktions plans des Vivana Fitness & Wellness Parks auf, wie Studiobetreiber mit den „Naschen erlaubt Produkten“ ih ren Umsatz, u. a. in der Weihnachtszeit steigern können. Erstmals wurde zudem die neue Produktserie „Wür zen erlaubt“ vorgestellt. Die Serie um fasst die vier Produkte Kochwürze,













Die Teilnehmer der myline-Livetour bekamen, so wie hier im Wiesbadener Pentahotel, ein spannendes Vortragsprogramm mit wertvollen Praxistipps geboten
Thai-Curry, Kräutergarten und Medi terrane Kräuter. Der Clou der Neuhei ten in Bioqualität sind die QR-Codes auf den Dosen. Sobald Kunden den Code scannen, erhalten sie Rezepte für Gerichte, die man mit dem jeweili gen Gewürz zubereiten kann. Im Wer bemittelpaket für Studios ist zudem ein hochwertiger Werbefilm enthalten.
Ein Highlight der vorgestellten Neu heiten ist der digitale Verkaufscoach 1.0. Per iPad können Trainer zukünftig in wenigen Minuten ermitteln, welcher Abnehmtyp der jeweilige Kunde ist. Berücksichtigt werden dabei u. a. die individuellen Vorlieben beim Essen, Allergien und Unverträglichkeiten. So bekommt jeder Kunde genau das Pro gramm, das ideal zu ihm passt. Um den größtmöglichen Erfolg mit dem digitalen Verkaufscoach 1.0 erzielen zu können, hat myline passende Wer bemittel entwickelt, die mit dem Slogan „Welcher Abnehmtyp bist du?“ gebrandet sind. Eine digitale Lead kampagne, die der myline-Koopera tionspartner FACEFORCE bietet, soll zusätzlich zum Erfolg beitragen.
Auch einige myline-Kooperationspartner präsentierten im Verlauf des Events ihre spannenden Neuheiten für myline-Kunden. Michael Banderenko von Polar stellte beispielsweise vor, wie Studios sich mit den neuen myline Fatburner Classes powered by Polar noch stärker als Abnehmspezialist positionieren können. Claudia TowaeKelbling von CTK, Coaching, Training & Konzepte GbR zeigte auf, wie Be treiber digitale §20-Präventionskurse einsetzen können, sodass sie ihren Mitgliedern einen echten Mehrwert bieten können. Nicolai Tauscher, Ge schäftsführer der igroup, griff das viel diskutierte Thema Mitarbeiter auf. An hand seines eigenen Unternehmens schilderte er, welche Sorgen er in diesem Bereich über viele Jahre hatte und wie es zu einem Umdenken bei der Personalauswahl kam. Zudem gab er Studiobetreibern wertvolle Tipps in Sachen Personalrecruiting.


Auf großes Interesse bei den Gästen stießen die Anregungen von Alexan der Dillmann zum Thema Neukunden-
gewinnung. Die Teilnehmer beteiligten sich aktiv an der Diskussion und schil derten ihre Erfahrungen und sprachen ihre Empfehlungen zur Neukunden gewinnung aus. Ein weiterer Themenblock auf der Agenda befasste sich mit den gestiegenen Energie kosten und möglichen Einsparmaß nahmen. Alexander Dillmann stellte die Maßnahmen des Vivana Fitness & Wellness Parks vor. Zur Kostenreduktion ist z. B. die 80-Grad-Sauna als eine von drei Saunen außer Betrieb. Die Sauna wird derzeit ausschließlich auf Kun denwunsch kurzzeitig eingeschaltet. Außerdem hat Alexander Dillmann in der Anlage frühzeitig auf Propangas umgestellt, auf LED-Technologie und Fotovoltaik umgerüstet.

Auszeichnung der myline-Partner des Jahres
Ein mit Spannung erwarteter Pro grammpunkt war die Auszeich nung der myline-Partner des Jahres 2020/2021. Ausgezeichnet wurden das Team-Fitness Unna, das TopSports Alten-Buseck und das maxx! Gesundheitszentrum.
Wohltuende Wärme und die sanfte Kraft des Wassers aktivieren die tieferen Gewebeschichten, regen den Stoffwechsel an, fördern die Durchblutung und lockern die gesamte Muskulatur. Dabei ist die Massage kontaktlos und kann sogar komplett bekleidet genutzt werden. Spa_Complete bietet zusätzlich eine einzigartige Entspannungswelt aus Licht, Farben, Aroma und Musik. Für ein ganzheitliches Wohlfühlerlebnis, das Ihre Mitglieder begeistern wird.





Die milon und five Stadiontour machte im September in insgesamt fünf großen deutschen Stadien halt. Nach dem Volksparkstadion Hamburg, dem Olympiastadion Berlin, dem Deutsche Bank Park Frankfurt und der VELTINSArena Gelsenkirchen fand am 27. September das Finale in der Münchner Allianz Arena statt. Beim Abschlussevent war auch BODYMEDIA mit von der Partie.
Mit rund 120 Gästen, dem besten Er gebnis der gesamten Stadiontour, ent puppte sich das Event im Stadion des FC Bayern München als Publikumsmagnet.
Zu Beginn der Veranstaltung begrüßten Marc Wisner, Mitglied der Vertriebslei tung und Bernd Reichle, Geschäfts führer der milon industries GmbH, die Gäste. Da Wolf Harwath das Finale der Stadiontour kurzfristig krankheits bedingt absagen musste, übernahm Marc Wisner auch dessen Vortragspart.

Positives Signal an die Branche Marc Wisner zeigte verschiedene Möglichkeiten auf, wie sich sowohl Studiobetreiber als auch Physiothera peuten vom Wettbewerb abgrenzen, Mitglieder halten und neue Zielgrup
pen gewinnen können. Auch wenn die Zeiten derzeit nicht einfach seien, sprach der Vertriebs- und Konzept spezialist den Teilnehmern Mut zu und verdeutlichte, welches Potenzial die Fitness- und Gesundheitsbranche zukünftig hat. Nach einer kurzen Pause referierte Christian Hasler zum Thema VIKOMOTORIK. Der Ge schäftsführer von movement concepts erklärte zunächst den Begriff, der sich aus den drei Wörtern Visuell, Kog nitiv und Motorik zusammensetzt. Anschließend zeigte er anhand von Beispielen auf, warum dieses Trai ning so wichtig ist und wie Physio therapeuten und Fitnessstudios mit dem entsprechenden Angebot neue Zielgruppen wie z. B. Vereine, Spitzen-
sportler, Senioren und Kinder für sich gewinnen können.
Nach der Mittagspause, die zur Stär kung und zum Netzwerken genutzt wurde, wurden die Teilnehmer in zwei Gruppen eingeteilt. Die eine Gruppe bekam von Christian Hasler einen Ein blick, welch vielseitigen Möglichkeiten der skillcourt bietet, anschließend wur de anhand einer Livedemo milon YOU vorgestellt. Der Nachfolger vom miloni zer, bei dem die 3D-Avatartechnologie zum Einsatz kommt, erfasst alle wich tigen Körperdaten äußerst präzise und verkürzt und vereinfacht den Onboardingprozess. Zum Abschluss wurde den Teilnehmern gezeigt, welche Funktionen
und Trainingsmöglichkeiten milonQ bietet. Die andere Gruppe erkundete währenddessen gemeinsam mit einem Guide das Stadion des FC Bayern München. Beim Stadionrundgang er fuhren die Gäste einige interessante Facts wie z. B. zur aufwendigen Dach konstruktion, zur Größe und Gewicht der Anzeigentafeln, den Logenpreisen und mit welchem Aufwand der Rasen gepflegt wird. Ein Highlight der Stadiontour war der Blick in die Katakomben, die Umkleidekabinen und der Weg von dort ins Stadion.



Zum finalen Vortrag von Alexander Strahl zum Thema Verkaufspsychologie versammelten sich wieder beide Gruppen in der Event-Box.

Am 16. und 17. September fanden sich wissenschaftlich interessierte Teilnehmer zum 3. Fitnesswissenschaftkongress ein, der in diesem Jahr in den Räumen der Goethe-Universität Frankfurt stattfand. Die Teilnehmer erhielten einen umfangreichen Einblick in unterschiedliche Themengebiete der Wissenschaft im Fitnessbereich.
Der Austausch junger und erfahrener Kollegen und die Zusammenkunft verschiedener Fachbereiche und He rangehensweisen sind der Grund gedanke, der hinter dem Fitnesswis senschaftskongress steht. Um das zu ermöglichen, teilte sich das Programm des Kongresses in unterschiedliche Abschnitte. Den Auftakt machten die drei englischsprachigen Wissen schaftskoryphäen Prof. Dr. Stuart Phillips von der McMaster University in Kanada, der über neue Erkenntnisse im Widerstandstraining sprach, Brad Schoenfeld mit der Wissenschaft hin ter dem Aufbau von Muskelmasse so wie Keith Baar, der die Gesunderhal tung der Gelenke in den Fokus nahm.
Nach den Vorträgen der etablierten Wissenschaftler durften Nachwuchs

forscher beim Young Investigators Award kurze Einblicke in ihre For schung geben. Dazu hatten sie nur wenige Minuten Zeit, um über ihre Projekte zu sprechen. Eine herausfor dernde Aufgabe, die von den jungen Wissenschaftlern gut gelöst wurde. Noch weniger Zeit hatten die Nach wuchsforscher, die im Anschluss da ran im Rahmen einer Posterpräsenta tion ihre Forschung vorstellten. Nach dem vielen wertvollen Input ging es zum gemeinschaftlichen Empfang und Abendessen. Hier wurde der Award für den besten Vortrag der Jungakademi ker von Gastgeber Prof. Dr. Michael Behringer von der Goethe-Universität und Initiator Prof. Dr. Stephan Geisler verliehen.
Umfangreiches Vortragspro gramm am zweiten Kongresstag Während das Programm am ersten
Kongresstag für alle Teilnehmer iden tisch war, mussten sich diese für den folgenden Tag jeweils zwischen zwei möglichen Themenblöcken entschei den. Darunter waren klassische The men wie Kraft oder Ausdauer, aber auch Sportmedizin, Muskelphysiologie und Athletik. Pro Themenblock wurden drei Vorträge angeboten, die von einer Podiumsdiskussion abgeschlossen wurden. Darunter waren z. B. Themen wie „Der ultimative Kraftkoeffizient“ von Prof. Dr. Stephan Geisler, „Sport und Multiple Sklerose“ von Prof. Dr. Dr. Philipp Zimmer oder „Muskelschwund und effektive Gegenmaßnahmen bei Astronauten, Alterssportlern und Pati enten“ von Prof. Dr. Jörn Rittweger.
Der nächste Fitnesswissenschafts kongress ist bereits geplant. Er soll dann 2024 stattfinden. Dann wieder in einer anderen Location.
Sarkopenie-Erkennung leicht gemacht mit dem einzigartigen Sarkopenie-Index


Die Analyse der Körperzusammensetzung ermöglicht es Ihnen, frühzeitig Anzeichen für Sarkopenie zu erkennen.
Die TANITA-Technologie verwendet Bio-Impedanz-Analyse für eine genaue Bewertung der Körperzusammensetzung.
Kann ein Frühindikator für zukünftige Gebrechlichkeit sein und ermöglicht rechtzeitige Vorbeugung Phasenwinkel



Der Phasenwinkel ist die direkte Messung der Integrität von Zellmembranen und zeigt den Gesundheitsstatus der Zellen an



Körperfettmasse
Das Gewicht des Fettes im Körper
Muskelmasse (magere Masse)
Das Gewicht der Muskeln im Körper; umfasst die Skelettmuskulatur, glatte Muskeln und den Herzmuskel
Skelettmuskelmasse
Das Gewicht der Skelettmuskeln allein
Körperfettanteil
Der prozentuale Anteil des Körpergewichts, der aus Fett besteht
Sarkopenie-Index

Ein Risikoindikator für die individuelle Tendenz, Sarkopenie zu entwickeln
Der Sarkopenie-Index ist auf allen unseren Segmentanalysewaagen mit TANITA-Software verfügbar



Weit über 100 Teilnehmer waren am 15. September in den Berliner DHZ-Showroom gekommen, um am DHZ-Partnertag teilzunehmen. Das abwechslungsreiche Tagesprogramm kam bei den teilnehmenden Studiobetreibern sehr gut an.
Beim DHZ-Partnertag referierten Sabrina Fütterer und Florian Kündgen vom DSSV, Eugen Liebman von GET FIT, Eckhard Santana von SANTANA Consulting und Jens Sauter für TRUGGE zu spannenden Themen. Außerdem wurde die gesamte Ver anstaltung durch das im Showroom fest installierte Licht-, Sound- und Videosystem der Firma Aschenbach präsentiert, die auch als Ansprech partner vor Ort war. Selbstverständ lich hatten die Gäste während den
Pausen ausreichend Gelegenheit zum Netzwerken.
Zufriedene Veranstalter Michael Birk, Geschäftsführer DHZ Fitness, zieht ein positives Fazit zum DHZ-Partnertag. „Es hat sich gezeigt, dass in der Fitnessbranche ein hoher Informationsbedarf besteht. Die Mög lichkeit, sich mit Fachleuten und Kol legen über die aktuelle Situation aus zutauschen, stieß auf reges Interesse. Wir werden auch weiterhin mit unseren

Partnertagen eine Plattform bieten, um durch positives Netzwerken die Fit nessbranche zu stäken. Wir haben uns natürlich sehr gefreut und sind ein biss chen positiv überrascht worden, dass so viele Gäste unserer Einladung ge folgt und nach Berlin gekommen sind.“
Abgerundet wurde der DHZ-Partnertag durch ein kulinarisches Buffet, ein gemeinsames Hotel Downtown Berlin und die abendliche Fahrt im Partybus quer durch die Hauptstadt.

Das spanische Wort „vamos“ bedeutet übersetzt vorwärts und ist zugleich das Firmenmotto von SANTANA. Richtig vorwärts ging es auch für das Start-up in den vergangenen zwei Jahren. Sinnbildlich für die rasante Entwicklung des Unternehmens stehen die neuen, größeren Räumlichkeiten, die Geschäftsführer Eckhardt Santana gemeinsam mit seinem Team Mitte August in Aschaffenburg bezogen hat.
Eckhardt Santana hat mit Anfang 30 schon einiges erlebt. Bis zu sei nem 12. Lebensjahr hat er in Cara cas, Venezuelas Hauptstadt, gelebt und die deutsche Schule besucht. Auf einem Fußballturnier in Argentinien hat er einige Scouts mit seinem Talent überzeugt und ihn zog es, allein ohne Familie, ins Internat des 1. FC Kaiserslautern. Nach zwei Jahren packte ihn das Heimweh und er kehrte in seine südamerikanische Heimat zurück. Mit 16 startete er dann einen zweiten Anlauf und er kam im Nach wuchsbereich bei Eintracht Frankfurt unter. Alles lief gut und die Karriere als Profifußballer schien zum Greifen nah. Doch dann riss ihm insgesamt dreimal das Kreuzband, sodass mit 19 Jahren der Traum des Profifußballers ausge träumt war. Immerhin gab ihm Viktoria Aschaffenburg die Möglichkeit, in der Regionalliga sein Können unter Beweis zu stellen und gleichzeitig eine Ausbil dung als Reiseverkehrskaufmann zu absolvieren.

Nach abgeschlossener Ausbildung zog es ihn erneut zurück nach Ve nezuela. Dort hatte er das Glück, für eine deutsche Agentur zu arbeiten, die 16 Boutique-Hotels betreute. Schnell übernahm der damals 21-Jährige Verantwortung und führte ein Team von 60 Mitarbeitern. Die hohe Inflation und Kriminalität in Venezuela veran
der Corona-Hochphase SANTANA zu gründen.
Neue Produkte und große Pläne Angefangen hat alles mit drei Mitar beitern. Mittlerweile gehören 17 An gestellte dem SANTANA-Team an. Bis Ende des Jahres soll es weiter auf 20 Personen anwachsen. Wenn Eck
lassten ihn, erneut nach Deutsch land zurückzukehren. Neben dem Sportmanagementstudium arbeitete Eckhardt Santana bei einer großen Discount-Fitnesskette. Dort durchlief er, wie später auch bei der inhaber geführten Premiumkette BodyCulture, alle Stationen von der Theken- zur Führungskraft. Als er leitende Posi tionen innehatte, entdeckte er seine Affinität für das Thema Marketing. Dieses Marketing-Know-how veranlasste ihn letztlich 2019, während

hardt Santana erklärt, wie aufwendig das entwickelte System zur OnlineMitgliedergewinnung ist und wie inten siv die einzelnen Kunden betreut wer den, versteht man, wie viele Rädchen ineinandergreifen müssen und warum so viel Manpower erforderlich ist. Zur Kundenbetreuung gehören wöchentli che Reportings, alle 14 Tage ein Jour fixe und Soforthilfe über das Kommu nikationstool Slack. Vor einer Zusam menarbeit finden zudem ausführliche Erstgespräche statt. Hier wird tiefgrün
dig die Positionierung des Kunden er fragt. Zudem werden ausführlich die Phasen der jeweiligen Kampagne be sprochen. Hierfür hat SANTANA eine sogenannte Journey entwickelt. Diese setzt sich aus der Buyers Journey, also der Mitgliedergewinnung und der Member Journey zusammen. Um den Verkauf von Online-Mitgliedschaften für Studiobetreiber zu vereinfachen und voranzutreiben, werden soge nannte Full Funnels gebaut, die den Abschluss einer Mitgliedschaft in nur drei Monaten über die Website er möglichen. Wichtige Bestandteile des SANTANA-Konzepts sind PerformanceMarketing und Branding, weshalb Eckhardt Santana auch den Begriff Brandformance kreiert hat. Ein Groß teil des Teams arbeitet auch in diesen beiden Bereichen. Ganz bewusst hat der Geschäftsführer all diese Mitar beiter in einem Großraumbüro un tergebracht. Eckhardt Santana ist es wichtig, dass beide Seiten, also zum einen die kreativen Köpfe und zum an deren die Analytiker Hand in Hand ar beiten. Was SANTANA ausmacht und von den Wettbewerbern hervorhebt,
Santana zeigtIsabell Winkhardt von der BODYMEDIA das Medialoft
SANTANA ist in den vergangenen zwei Jahren enorm gewachsen
Zum SANTANA-Team zählen mittlerweile 17 Angestellte
beschreibt Eckhardt Santana wie folgt: „Wir bieten keine Kampagnen von der Stange, sondern gehen individuell auf die Bedürfnisse und die Gegeben heiten bei jedem einzelnen Kunden ein. Wichtig ist, dass unsere Kunden verstehen, dass es nicht nur darum geht, Leads zu generieren, sondern Mitglieder zu gewinnen. Daher auch unser Claim Mitglieder statt Leads“, erklärt Eckhardt Santana. Wichtig ist dem Geschäftsführer zudem, dass SANTANA keine reine Online-Agentur ist.
Herzstück des neuen Office ist das so genannte Medialoft. Hier finden mehr mals pro Woche sogenannte Mediadays statt. Die umfassenden Mediaproduktionen werden individuell auf jeden Kunden zugeschnitten. Das pro duzierte Material, das Content für ein Jahr bietet, wird dann für die jewei


ligen Kampagnen verwendet. Doch nicht nur im Medialoft, sondern auch vor Ort in den Clubs wird fleißig pro duziert. Allein mit der Mediaproduktion sind drei Mitarbeiter beschäftigt. Vor allem Betreiber mit mehreren Studios und Ketten, wie zum Beispiel GET FIT, TOP SPORTS, FITSEVENELEVEN, FIT NESS LEVEL und JONNY M, zählen zu den Kunden.
Ab dem ersten Quartal 2023 wird es ein neues, preisgünstigeres Produkt namens Member Class geben. Ziel ist es, Studiobetreibern und ihren Teams in Schulungen Theorie zu vermitteln, sodass sie das 1x1 des Onlinemarke tings lernen und sie selbst erfolgreich Kampagnen entwickeln und durch führen können. Wissensvermittlung ist für Eckhardt Santana einer der wich tigsten Bausteine für den Erfolg seiner Kunden. Deshalb wird es im nächsten
Jahr pro Quartal ein Kundenevent in Aschaffenburg geben, wo sowohl SANTANA-Mitarbeiter als auch externe Referenten zu spannenden Themen referieren werden.
Eckhardt Santana hat in kurzer Zeit viel geleistet. Um weiterhin gesund wach sen zu können, wurde mit dem neuen Unternehmenssitz und der Teamerweiterung die ideale Infrastruktur geschaffen. Ziel ist es, so der ambitio nierte Geschäftsführer, die Projektent wicklung weiter zu verbessern. Dabei möchte er sich selbst stärker aus dem operativen Geschäft zurückziehen, noch mehr Verantwortung an seine Mitarbeiter übergeben und im Hin tergrund an neuen, kreativen Onlinekampagnen für Studiobetreiber arbei ten – getreu dem Unternehmensmotto „Vamos“.

Vom Bett zum Bürostuhl und dann auf die Couch: So sieht der Alltag bei vielen Deutschen aus. Lange schon wissen wir, dass sich die meisten am Tag zu wenig bewegen und kei nen Ausgleich für das viele Sitzen haben. Dabei ist körperliche Aktivität auch für den Kopf essenziell. Neben dem konventionellen Kraft- und Ausdauertraining braucht es auch einen kognitiven Baustein, um im Alter die mentale Gesundheit zu erhalten.
Jede Bewegung unseres Körpers beginnt im Kopf. Sie basiert auf einer Gewohnheit, einem neuromuskulären Programm, das wir teilweise unbe wusst ausführen. Ein Gedanke oder Impuls löst dabei einen Automatismus aus, der die Bewegung ablaufen lässt, indem ein Teil unseres Gehirns in sehr detaillierten Aufträgen über unser Ner vensystem und die Muskeln mitteilt, welche Muskelfasern sich anspannen oder loslassen sollen und wann diese Aktion wieder enden soll. So führen wir Bewegungen ganz automatisch und nebenbei aus und brauchen für

alltägliche Bewegungen, wie etwa morgens aus dem Bett aufzustehen, nicht besonders viel Aufmerksamkeit.
Der Gedanke „ich möchte aufstehen“ führt zu dem neuromuskulären Muster, löst die Bewegung aus und man steht wie von selbst auf. Man könnte sagen, jede alltägliche Bewegung ist bereits da, bevor wir sie ausführen. Egal, ob eine grob- oder feinmotorische Be wegung, wir brauchen das Zusam menspiel der Nerven und Muskeln, die miteinander kommunizieren und im ständigen Feedback stehen.
Bewegung ist schon im Kindesalter wichtig Impulse kommen auch von außen. Hierbei helfen uns unsere Sinne und kognitiven Fähigkeiten, wie die Umge bung wahrzunehmen, aufmerksam zu sein und zu denken, um die Informa tionen verarbeiten und umsetzen zu können. Diese Fähigkeiten sollten im Kindesalter erlernt, stabilisiert und bis ins hohe Alter erhalten werden. „Wenn wir uns den Alltag heute anschauen, sehen wir allerdings viele Defizite“, erklärt Chris Baur, Vertriebsleiter bei xelerate cognitive Fitness. „Kleinkinder






werden viel zu häufig schon vor dem Fernseher „geparkt“ und Puzzles wer den auch häufig schon auf dem Tablet gemacht. Hierdurch fehlt den Kids die Wahrnehmung, Haptik und die Fein motorik. Es ist um einiges anspruchs voller, ein Holzpuzzle zu lösen, als die Teile auf der Glasscheibe des Tablets ineinander zu fügen.“
Fest steht, dass 80 % der Kinder und Jugendlichen sich laut des Vierten Kinder- und Jugendsportberichtes1 nicht ausreichend bewegen und das von der WHO empfohlene Minimum von 45 Minuten leichtem Sport am Tag nicht erreichen. Die Annahme liegt nahe, dass Kinder, die sich nicht ge nügend bewegen, zu Erwachsenen heranwachsen, die das wahrscheinlich auch nicht tun. Gerade heute mit der vielen Zeit, die Kinder und Jugendliche vor den Bildschirmen der Smartpho nes und Computer verbringen, hat das fatale Folgen. Denn Sport ist nicht nur wichtig für die Gesundheit, sondern fördert auch die kognitive Leistungs fähigkeit. Leichte kognitive Beein trächtigungen äußern sich beispiels weise durch eine Verminderung des Denkvermögens, der Aufmerksamkeit und des Gedächtnisses und kann zu

Schwierigkeiten bei der Problemlö sung, Konzentrationsfähigkeit, Orien tierung und beim Sprechen führen.
Die geistige und physiologische Leistungsfähigkeit trainieren Um dem modernen, digitalisierten Alltag und dessen Hürden entgegen zuwirken, benötigt man ein speziell abgestimmtes Training, das die geis tige und physiologische Leistungsfä higkeit stärkt: ein kognitives Training in Verbindung mit körperlichem Trai ning. Schlüsselelemente sind hierbei das Sehen, Reagieren, Verarbeiten und Umsetzen der Bewegung. Ge rade in der Gruppe sorgt es für kon tinuierliche Motivation und „zwingt“ den Übenden, sich auf sich selbst zu konzentrieren.
Bei dem ganzheitlichen Training von xelerate findet das Training auf einer Power Area mit integrierten Senso ren und einem 65-Zoll-Monitor statt. Hierbei können so bis zu 650 Muskeln im Körper koordiniert und auf Bewe gungen abgestimmt werden. Das Training sieht dann wie folgt aus: Auf einem großen Bildschirm werden Be wegungsaufgaben angezeigt. In ver schiedenen Spielformen wie dem Mer
ken von Zahlenfolgen, dem Lösen von Rechenaufgaben, dem Buchstabieren oder Ablaufen von Feldfolgen muss der Trainierende die Aufgabe erfassen, in die jeweilige Lösung umwandeln und das Ergebnis auf dem richtigen Spielfeld anlaufen. Nach jeder Übung bekommt der Teilnehmer ein direktes Feedback über die Qualität der Bewe gung und Punkte für die Schnelligkeit und Treffsicherheit.
Hierbei gibt es unterschiedliche Übungskategorien:
• Fixe Abläufe, bei denen die Feld abfolge schon bekannt ist. Der Trainierende muss hierbei nicht auf den Bildschirm schauen.
• Zufällige Abläufe, bei denen der Trainierende auf den TV schauen muss, um die nächsten Bewe gungsaufgabe zu erfahren.
• Eine Kombination aus den oben genannten Kategorien mit zufälli gen Feldabfolgen.
• Ein kognitiver Ablauf, bei dem der Trainierende den Laufweg selbst „lösen“ muss, indem er z. B. Farbinformation in Bewegungsrich tung „übersetzt“, buchstabiert, rechnet oder Memory spielt.
Kognitive Fitness ist mehr als durch virtuelle Welten zu rennen und Su doku oder Kreuzworträtsel zu lösen. Während die Neuroathletik bereits Ein zug in den Spitzen- und Breitensport gefunden hat, ist es nun an der Zeit, dass auch die kognitive Fitness im Fit nessbereich integriert wird. „Wir soll ten heute schon an morgen denken. Demenz, Schlaganfälle, Osteoporose und Sarkopenie betreffen mehr als fünf Millionen Menschen in Deutschland. Wir werden immer älter, aber unsere kognitiven Fähigkeiten werden zu we nig trainiert. Hier gilt es gegenzusteu ern“, so Chris Baur. Eine Möglichkeit für Fitnessclubs wäre hierbei, das Training von Xelerate einzubinden. Es eignet sich für alle Altersgruppen und bietet mit seinen unterschiedlichen Schwie rigkeitsstufen einen neuen, attraktiven Baustein in der Fitnesslandschaft.
1 „Der Vierte Kinder- und Jugendsportbericht“. Alfried Krupp von Bohlen und Halbach-Stiftung, 29. Oktober 2020, www.krupp-stiftung.de/ vierterkinderundjugendsportbericht.







Am 1. Dezember 2021 wurde in Celle ein neues clever fit Studio eröffnet. Dabei setzt der Inhaber nicht nur auf moderne und vielfältige Trainingsangebote, sondern auch auf einen komplett neuen Look, um Mitglieder von seinem Gesamtkonzept zu überzeugen.
Als im Juni 2021 die letzten Ausstel lungsmodelle aus dem ehemaligen Autohaus gefahren wurden, war noch nicht daran zu denken, dass in der Fachwerkstatt, nahe der Lüneburger Heide, keine sechs Monate später das wohl modernste clever fit Studio in Norddeutschland eröffnet. Die attrak tive Lage, die vorhandene Infrastruk tur, die durchgehende Glasfassade, die offen gestalteten Flächen – verteilt auf zwei Etagen und verbunden durch eine große Metall-Wendeltreppe – ga ben jedoch schnell den Ausschlag für die Entscheidung, in diesem Objekt ein neues Fitnessstudio zu eröffnen.
Bei der Planung und Konzeption des Studios war die Aufgabenstellung von vornherein klar definiert. Es muss sich im Design als auch von der Ausstat tung gegenüber den vorhandenen Fitnesseinrichtungen abheben. Zielset zung war es, einen Raum zu schaffen,

in dem die Mitglieder durch den Einsatz modernster Fitnessgeräte ihren körper lichen Zielen nachgehen können und die Möglichkeit haben, in den vorhan denen Wellnesszonen zu entspannen. Zugleich sollen die Mitglieder einen Ort vorfinden, an dem man sich vor, wäh rend und nach dem Training wohlfühlt und gerne aufhält. Zu diesem Zweck entwickelte die PBH Projektbau Ham burg in Kooperation mit der Hambur ger Innenarchitektin Svetlana Matysik, Inhaberin von MIRONOVA Interior De sign, ein neues Interior-Konzept. In en ger Abstimmung und nach Freigabe von clever fit stand die Entscheidung fest, dass Celle das erste Studio im neuen Gewand wird. Nach der Eröff nung am 1. Dezember 2021 steht das neue Ausbaukonzept nun künftig allen Franchisenehmern als Alternative zum Standardkonzept zur Auswahl, wobei jeder Standort mit Blick auf die Flächenaufteilung und die baulichen Gegeben heiten individuell gestaltet wird.
Das Ergebnis des Re-Brandings ist ein modernes Design im Industrial-Look, welcher ein ständiges Zusammen spiel zwischen hellen und dunklen Flä chen bietet – in Verbindung gebracht durch den Einsatz von verschiedenen Holzelementen als Raumtrenner, als Wandbelag und natürlich beim Möbel bau. Ein wichtiger Aspekt bei der Ge staltung spielt das Thema Licht. Der of fene Galeriebereich wird geschmückt durch eine überdimensionale, kreisför mige Deckenleuchte. Zudem sorgen verschiedene Retro-Lampen und ver steckte Lichtleisten für eine angeneh me, funktionale Beleuchtung und At mosphäre in allen Trainingsbereichen der Anlage.
m2
Der Tresen ist dunkel gehalten und steht im Kontrast zu den hellen, sich überlappenden MDF-Wandelementen in Betonoptik. Lichtbänder, das hin terleuchtete Logo und die passenden
Hängeleuchten sorgen für einen ent sprechenden Kontrast und setzen passende Lichtakzente. Hinter dem Eingangsbereich laden eine Sofa lounge und der erhöhte Sitzbereich zum Verweilen ein. Die quer- und übereinanderliegenden Holzelemente ergeben einen 3-D-Effekt, der durch die indirekte Beleuchtung noch ver stärkt wird. Passend dazu bietet die vorhandene Bar eine große Auswahl an Mineral- oder Heißgetränken. An grenzend an die offene Trainingsflä che, die komplett mit Geräten von Life Fitness ausgestattet ist, befin den sich die Zugänge zur Studiolei tung, zu den beiden Solarien und zur Hydrojet-Liege.
Die größten Umbauarbeiten im Erd geschoss fanden im ehemaligen Werkstatt-/Lagerbereich statt. Hier entstanden die modernen und optisch abgestimmten Umkleiden, Nassbe reiche und WC-Anlagen. Über die
jeweiligen Umkleideräume gelan gen die Mitglieder zum Ruhebereich und der Sauna. Auch hier finden sich viele Elemente des neuen clever fit Designs wieder. Das Zusammenspiel der Holzlamellen- und Steinwände mit den eingelassenen Lichtstreifen und der Deckenleuchte sorgen für eine dy namische, aber auch entspannende Raumatmosphäre.

Der Freihantelbereich im Erdgeschoss bietet eine Vielzahl von Trainings geräten. Besonders hervorzuheben ist, dass in Celle die erste OFFICIAL HAMMER STRENGHT BOX in ein norddeutsches Studio integriert wurde.
Schwitzen mit Ausblick im Obergeschoss


Über die dunkel gespritzte MetallWendeltreppe gelangt man in das 1. Obergeschoss. Das offene Studiokon zept wird zwar durch die räumliche Abtrennung des ca. 150 m2 großen
Die durchgehende Glasfassade, die offen gestaltete Flächen, verteilt auf zwei Etagen, sowie die Rundleuchte sind zentrales Gestaltungselement im clever fit Celle
Kursraumes und des separaten LadyFitness-Bereichs unterbrochen. Da für werden die rund 2.300 Mitglie der durch den Blick aus dem Kar diobereich in das unterliegende Erdgeschoss entschädigt.
Stefan Köbke ist Inhaber des clever fit Celle. Zudem ist er Geschäftsführer der PBH Projektbau Hamburg GmbH. Diese ist seit über sechs Jahren als Generalunternehmen tätig und über nimmt dabei die Komplettabwicklung von Bauvorhaben innerhalb der Fit nessbranche in ganz Deutschland. Egal ob es sich um einen Neubau oder einen Umbau handelt.

Aschenbach Audio Team GmbH & Co KG; www.aschenbach.com; Seite 118, Beilage
Audio Factory Media GmbH; www.audiofactory.de; Beilage
ACISO Fitness & Health GmbH; www.aciso.com; Seite 60
Cleanpaper GmbH & Co. KG; www.cleanpaper.de; Seite 99
CyberConcept GmbH; www.cyberfitness.de; Seite 105
Deutsche Berufsakademie Sport und Gesundheit der HVU Bildungsakademie gGmbH; www.dba-baunatal.de; Seite 67
Debifit - First Debit GmbH; www. firstdebit.de; Seite 27
Deutsche Sportakademie; www.deutschesportakademie.de; Seite 55
DHZ Fitness Europe GmbH; www.dhz-fitness.de; Seite 71
Dr. WOLFF® Sports & Prevention GmbH; www.dr-wolff.de, Seite 9
DSB - digital systemische Betriebskonzepte GmbH; www.dsb.digital; Seite 73 DSSV e.V. Arbeitgeberverband deutscher Fitness- und Gesundheits-Anlagen; www.dssv.de; Seite 141
D & S Fitness GmbH; www.100prozent-fitness.com; Seite 51
EASYFITNESS Franchise GmbH; www.easyfitness.club; Seite 75 EGYM GmbH; www.egym.com; Seite 46 escrea GmbH; www.agilea.de; Seite 33
EQUIMED Vertriebs GmbH; www.equimend.de; Seite 82 Experten Allianz für Gesundheit e.V.; www.expertenallianz-gesundheit.de; Umschlagseite 2
FAMOSO GmbH & Co. KG; www.famoso-group.de; Seite 63 fitnessRAUM.de GmbH; www.fitnessraum.de; Seiten 108, 109 Heal11 GmbH; www.heal11.de; Seite 13
HOLD STRONG FITNESS GMBH; www.holdstrong.de; Seite 119 InBody Europe B.V. Niederlassung Deutschland; www.de.inbody.com; Seite 40 In-des-a; www.in-des-a.com; Banderole, Seite 11
IST-Studieninstitut GmbH; www.ist.de; Seite 137 JK-International GmbH; www.wellsystem.de; Seite 127
KOHL GmbH & Co. KG; www.fitness-kohlkg.de; Seite 123 Landesmesse Stuttgart GmbH; www.messe-stuttgart.de/therapro; Seite 103, Versanddeckblatt
LES MILLS Germany GmbH; www.lesmills.de; Seite 17 Livepro Fitness Europe GmbH; www.livepro-fitness.de; Seite 45 M.A.C. CENTERCOM GmbH; www.mac-centercom.de; Seite 61 Matrix Fitness; www.matrixfitness.com; Seite 53 M.A.N.D.U. e.G.; www.mandu.one; Seite 77
MEDEX Fitness GmbH; www.medex-gmbh.com; Seite 57
MEET THE TOP GmbH & Co. KG; www.meet-the-top.fitness; Umschlagseite 3, Beilage milon industries GmbH; www.milon.com; Seiten 24, 87 movement concepts GmbH; www.movement-concepts.com; Seite 29 myline Deutschland GmbH; www.myline24.de; Seite 95 Myzone Group; www.myzone.org; Seite 83
OPTIMUM11 GmbH; www.optimum11.de; Seiten 4, 5, 133 Panatta srl; www.panattasport.com; Seiten 34, 35, 112, Beilage
Pinter Möbel + Objektbau GmbH & Co. KG; www.pinter-moebel.de; Seite 85
PJB Sport Investment GmbH; www.ufcgym.de; Seite 81
POWER PLATE GMBH; www.powerplate.de; Seite 39
Peloton Interactive Deutschland GmbH; www.onepeloton.de ; Seite 41
PRIME TIME fitness GmbH; www.primetime-fitness.de; Seite 79
Reed Exhibitions Deutschland GmbH; www.fibo.com; Seite 139 RehaVitalisPlus e.V.; www.rehavitalisplus.de; Beilage
Santana Consulting GmbH; www.santanaconsulting.com; Seite 113
Scotfit GmbH; www.scotfit.de; Seiten 100, 101, 111 seca gmbh & co. Kg; www.secatru.com; Seite 47
sicada GmbH; www.dynostics.com; Seite 89
Sphery AG; www.sphery.ch; Seite 65
Synfit334 GmbH; www.synfit334.de; Seite 93
Technogym Germany GmbH; www.technogym.com; Umschlagseite 4
TANITA EUROPE B.V.; www.tanita.de; Seite 131
Urban Sports GmbH; www.urbansportsclub.com; Seite 91
Virtuagym BV; www.virtuagym.com; Seite 94
WeMa Service GmbH; www.wemaservice.de; Seite 125
XBody Training Germany GmbH; de.xbodyworld.com; Seite 25
BODYMEDIA GmbH & Co. KG
Ewald-Renz-Str. 1 76669 Bad Schönborn Tel. +49 (0) 7253 / 9875-700 Fax: +49 (0) 7253 / 9875-799 E-Mail: redaktion@bodymedia.de Web: www.bodymedia.de
Geschäftsführer Nicolas Hessel
Herausgeber Hubert Horn
Redaktion
Jonathan Schneidemesser (Ch.-Red.) (v.i.S.d.P)
Constantin Wilser (stellv. Ch.-Red.) Kira Kamrad Sarah-Lea Kuner
Hugo Braam, Stefan Köbke, Florian Möger, Jan Paffhausen, Stephan Müller, Till Pitschel, Daniel Schwarzenberger, Nadine Zott
Lektorat Paula Matos
Design & Layout
Jessica Urich Katharina Jaschinski Manuel Fröhlich
Druck
C. Maurer GmbH & Co. KG Schubartstr. 21 73312 Geislingen/Steige
Kundenberatung
Isabell Winkhardt Tel. +49 (0) 7253 / 9875-707
Bezugspreise
Jahresabonnement 49,- Euro zzgl. 7% MwSt., incl. Lieferung frei Haus.
BODYMEDIA erscheint 6 x jährlich. Das Abonnement ver längert sich jeweils um 1 Jahr, wenn es nicht einen Monat vor Ablauf schriftlich gekündigt wird. Gerichtsstand ist Mannheim.
Alle in dieser Ausgabe veröffent lichten Beiträge sind urheberrecht lich geschützt. Alle Rechte liegen bei BODYMEDIA. Fremdbeiträge geben nicht unbedingt die Mei nung der Redaktion wieder. Alle Angaben erfolgen nach bestem Wissen, jedoch ohne Gewähr. Eine Haftung wird nicht übernommen.
Lange war es schwer für Fitnessstudiobetreiber, Personal Training in den Anlagen erfolgreich zu etablieren. Durch Corona erfuhr es einen starken Schub, der nun gefestigt werden kann. Wie genau das funktioniert, erfahren Sie in der nächsten Ausgabe.

Die Ausgabe
BODYMEDIA Fitness 1-2023
erscheint am 30.01.2023*


Neben kurzfristig auftauchenden rechtlichen Herausforderungen wie z. B. Webschriftarten dürfen dabei die bereits bestehenden Themen wie Arbeitsrecht, Unter nehmensnachfolge und, immer wichtiger, das IT-Recht nicht aus den Augen gelassen werden. Aktuelle Rechtsinformationen zu ausgewählten Themen lesen Sie in Ausgabe 1-2023.
In schwierigen Zeiten sind Fitnessstudiobetreiber dankbar über die richtigen Partner an der Seite, die ihnen mit Expertise und Sachverstand zur Seite ste hen. In der nächsten Ausgabe stellen wir im Rahmen unserer Marktübersicht wichtige Unternehmen aus diesen Bereichen vor.
02.12. + 03.12. – Pirmasens www.ergo-fit.de
Hinweis Aufgrund von Corona können die Event-Termine abweichen
03.12. – Schweinfurt www.ihr-nextlevel.de/akademie

15.12. + 16.12. – Hüfingen/ Schweinfurt www.milongroup.de
03.02. - 05.02. – Stuttgart www.messe-stuttgart.de

27.03. - 30.03. – Mallorca www.meet-the-top.fitness
FIBO
13.04. - 16.04. – Köln www.fibo.com
04.05. - 06.05. – Leipzig www.therapie-leipzig.de












Biostrength™ hilft Ihnen, die häufigsten Fehler beim Krafttraining zu vermeiden und so bis zu 30% bessere Ergebnisse zu erzielen. Dank des patentierten Biodrive Systems können Sie einfach Ihr Ziel wählen und Biostrength™ stellt automatisch die optimalen Widerstände für Sie ein.

Zudem erhalten Sie ein Biofeedback in Echtzeit und trainieren immer mit der für Sie idealen Belastung. Biostrength™ gibt immer das richtige Tempo, sowie die richtige Anzahl von Wiederholungen und Ruhezeiten vor.
Jetzt mehr erfahren auf